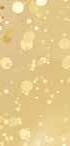

![]()





































































Sip swoon-worthy cocktails, savor delectable bites, and soak in the love-filled ambiance beneath a ceiling adorned with over 10,000 hearts.

Starting January 23rd, OPEN EVERY NIGHT AT 5PM ip swoon-wort r delectable bit love-filled amb ling adorned wit s, soak nc over 10,000 th h e benea








Fri, Jan 31 / 7 PM / UCSB Campbell Hall
Program includes Mozart, Stravinsky, Shostakovich, O’Carolan and contemporary arrangements of Nordic folk tunes
Event Sponsor: Anonymous Great Performances Suite Sponsors: G.A. Fowler Family Foundation and The Shanbrom Family Foundation


Double Grammy Nominee in 2024
Lakecia Benjamin and Phoenix
Fri, Feb 7 / 8 PM UCSB Campbell Hall




Epic Quintet Collaboration Imani Winds
Brass Sun, Feb 2 / 4 PM / Hahn Hall

Saxophonist and composer Lakecia Benjamin fuses soul and hip-hop with a strong foundation in the canon of modern jazz. Fans of John Coltrane, Wayne Shorter and Ornette Coleman, listen up – there’s a new horn in town, and she’s ready to roar.

Jazz Series Lead Sponsor: Manitou Fund


Hear & Now Series Sponsors: Linda Stafford Burrows and Dr. Bob Weinman Three Masters and Friends in a New Collaboration



Kayhan Kalhor, kamancheh Wu Man, pipa Sandeep Das, tabla
Wed, Feb 19 / 8 PM / UCSB Campbell Hall













Macduff Everton, Mary Heebner
Manager Ava Talehakimi Art Director Xavier Pereyra
Production Designer Bianca Castro Graphic Designer Leah Brewer
Columnists Dennis Allen, Gail Arnold, Sara Caputo, Christine S. Cowles, Laura Gransberry, Betsy J. Green, Shannon Kelley, Austin Lampson, Melinda Palacio, Cheri Rae, Hugh Ranson, Amy Ramos, Jerry Roberts, Starshine Roshell
Contributors Rob Brezsny, Melinda Burns, Cynthia Carbone Ward, Ben Ciccati, Cheryl Crabtree, John Dickson, Roger Durling, Camille Garcia, Chuck Graham, Keith Hamm, Rebecca Horrigan, Gareth Kelly, Kevin McKiernan, Zoë Schiffer, David Starkey, Ethan Stewart, Brian Tanguay, Tom Tomorrow, Kevin Tran, Jatila Van der Veen, Isabelle Walker, Maggie Yates, John Zant
Director of Advertising Sarah Sinclair Marketing and Promotions Administrator Richelle Boyd
Advertising Representatives Camille Cimini Fruin, Suzanne Cloutier, Bryce Eller, Remzi Gokmen, Tonea Songer Digital Marketing Specialist Graham Brown
Operations Administrator Erin Lynch
Office Manager/Legal Advertising Tanya Spears Guiliacci Distribution Gregory Hall Interns Ella Bailey, Hadeel Eljarrari, Nataschia Hadley, Madeline Slogoff, Luke Stimson, Tia Trinh, Ellery Wakeman
Columnist Emeritus Barney Brantingham Photography Editor Emeritus Paul Wellman
Founding Staff Emeriti Audrey Berman, George Delmerico, Richard Evans, Laszlo Hodosy, Scott Kaufman Honorary Consigliere Gary J. Hill IndyKids Bella and Max Brown; Elijah Lee, Amaya Nicole, and William Gene Bryant; Henry and John Poett Campbell; Emilia Imojean Friedman; Rowan Gould; Finley James Hayden; Ivy Danielle Ireland; Madeline Rose and Mason Carrington Kettmann; Izzy and Maeve McKinley
Print subscriptions are available, paid in advance, for $120 per year. Send subscription requests with name and address to subscriptions@independent.com. The contents of the Independent are copyrighted 2023 by the Santa Barbara Independent, Inc. No part may be reproduced without permission from the publisher. The publisher assumes no responsibility for unsolicited material. A stamped, self-addressed envelope must accompany all submissions expected to be returned. The Independent is available on the internet at independent.com. Press run of the Independent is 25,000 copies. Audited certification of circulation is available on request. The Independent is a legal adjudicated newspaper court decree no. 157386. Contact information: 1715 State Street, Santa Barbara, CA 93101 PHONE (805) 965-5205; FAX (805) 965-5518
EMAIL news@independent.com,letters@independent.com,advertising@independent.com Staff email addresses can be found at independent.com/about-us



First Before Restarting Off-Shore Drilling Interview by Victoria Riskin
This week, we’d like to introduce you to the woman who wrote our cover story, Victoria Riskin. She’s a dedicated activist who has launched her own magazine, Bluedot Living, which we work with to bring you the Santa Barbara Green Guide. You wrote our cover story this week and interviewed Linda Krop. Why is this story so important right now?

The prospect of Sable Offshore Oil restarting drilling in the Santa Barbara Channel is the most important environmental story in a decade regarding Santa Barbara, the region, and maybe even the State of California. Pumping oil out of the ocean to transport it 150 miles through a corroded pipeline would have disastrous effects on marine life, coastline, the air we breathe, and our economy if there is another spill, which is highly likely. Linda Krop is at the forefront of the legal battle to stop ExxonMobil and Sable, and her smart, spirited style makes her a good subject to profile.
What brought about Bluedot Living? Was this an idea you had for a long time that was finally able to be brought to life? Most climate stories highlight important aspects of the crisis, but these stories can also leave the reader feeling helpless. In fact, there’s a lot we can do in our homes and towns to be a part of the solution. I wanted to create a lifestyle newsletter and magazine to inspire people to become engaged and try some things that if we all do can make a difference. I wanted explore all the climate-solution innovation going on like new ways of farming, micro-nuclear technology, microgrids, wind and solar farms, kelp farms, electric cars and buses, even leather made of mushrooms, shoes made from pineapple… . I love to tell those stories and the people behind them.
You’re also working on another Santa Barbara Green Guide with the Independent. What are you most looking forward to for this year’s publication? Our second edition of the Green Guide will come out before Earth Day in early April this year. You’ll read about local community gardens, how parents can guide their kids, and you’ll learn about programs to save animals: pelicans, eagles, island foxes, peregrine falcons, gray whales, and monarchs. That sort of thing. Working with the Independent team is a real pleasure.


TUESDAY, FEBRUARY 18, 2025, 7:30PM
Sir Antonio Pappano, Chief Conductor Janine Jansen, violin

Community Arts Music Association and the Music Academy of the West co-present the London Symphony Orchestra under the direction of Sir Antonio Pappano in his first concert in the United States as Chief Conductor of the London Symphony Orchestra.
The legendary London Symphony Orchestra, led by esteemed Music Director Sir Antonio Pappano, returns to Santa Barbara for a special concert. Internationally celebrated violinist Janine Jansen joins them as soloist, performing on the 1715 Shumsky-Rode Stradivarius.
PROGRAM: BERNSTEIN: Serenade, after Plato’s Symposium MAHLER: Symphony No.1, “Titan”
We graciously acknowledge Linda and Michael Keston as the Lead Sponsors for this concert. CAMA further acknowledges these generous concert sponsors:
Principal Sponsor: The Herbert & Elaine Kendall Foundation
Sponsors: Anonymous • Bob Boghosian & Mary E. Gates Warren • Alison & Jan Bowlus
Judith L. Hopkinson • Sara Miller McCune • Ellen & Peter Johnson • Ellen & Thomas Orlando
Co-Sponsors: Alice & Todd Amspoker • Elizabeth & Andrew Butcher • Meg & Dan Burnham
Dennis & Frederika Emory • Zegar Family Foundation

EXHIBITIONS ON VIEW
Through March 9, 2025
Accretion: Works by Latin American Women
Through April 13, 2025
For more exhibitions and events, visit www.sbma.net.
1130 State Street, Santa Barbara, CA
Tuesday–Sunday 11 am–5 pm • 1st Thursdays 11 am–8 pm
Get advance tickets at tickets.sbma.net.
EVENTS
Saturday, February 1, 5 pm
Ant Hampton / Time Based Editions “Borderline Visible”
Audio-Visual Live Performance and Storytelling Get tickets at tickets.sbma.net.
Thursday, February 6, 5:30 – 7:30 pm
Family 1st Thursday Free art making


by



De la Guerra Plaza was packed with pink shirts, knitted pussyhats, and people waving signs both hopeful and defiant during the People’s March Santa Barbara, a community rally held Saturday as part of a nationwide day of unity and resistance before Inauguration Day.
Nearly 300 people filled the courtyard plaza, where former state senator HannahBeth Jackson served as emcee for the event, introducing a stream of short speeches from political heavyweights, community organizers, and representatives from local groups such as the Santa Barbara Women’s Political Committee, La Casa de la Raza, and the Dr. Martin Luther King Jr. Committee Santa Barbara. Following the demonstration, the group marched their way down State Street.
“We’ve seen these battles for a long time,” Jackson said during the rally before the march. “And we’re not giving up now.”
In the crowd, people listened intently, shouting words of agreement and waving homemade signs. “If I make my uterus a corporation, will you stop regulating it?” one sign read; “Let’s turn four years of shit into compost,” said another. One man in the crowd wore a Trump mask, a black-and-white prison uniform, and Mickey Mouse gloves, waving a sign that simply said: “Clown”
The event served as a chance for Santa Barbara’s progressive community to regroup, reenergize, and turn the page from mourning the results of the presidential election to preparing for the political fights ahead. This year’s theme, “Where the Power Truly Lives: With the People,” called on Americans to “remind Washington elites of the power and importance of collective action,” according to the event organizers. —RyanP.Cruz

The last of a five-day series of events to celebrate Dr. Martin Luther King Jr. began on a sunny Santa Barbara morning in De la Guerra Plaza, while at the same time in chilly Washington, D.C., Donald J. Trump was sworn in as the nation’s 47th president.
“With the inauguration of Trump, this represents a tremendous dissonance from Dr. King’s messages,” said the first speaker in downtown S.B., Assemblymember Gregg Hart. King had spoken of hope and dignity for the oppressed, and for love and equality among all Americans. However, 20 percent of farmworkers had stayed home that day, Hart said, out of fear of deportation, which was a message Trump pounded out during his campaign and since winning the election. Hart asked residents to rally to support farmworkers and immigrants in the coming days.
The day had been organized by the MLK Jr. Committee to reflect Dr. King’s beliefs, under
Former President Joe Biden and former First Lady Jill Biden arrived in Santa Barbara County Monday afternoon after attending the inauguration of President Donald Trump earlier in the day. The Bidens who also spent time on the Central Coast earlier this summer landed at Vandenberg Space Force Base following a brief sendoff ceremony at Joint Base Andrews on the East Coast.
The 46th president and his wife could be seen disembarking Air Force One and receiving a warm wel-
come from Vandenberg Space Force Base Airmen and Space Force Delta 30 commander Colonel Mark A. Shoemaker on the tarmac.
When the Bidens previously visited Santa Barbara County in August, the couple was spotted with family and friends around Solvang and Los Olivos. On this visit, the former president will reportedly be spending more time at the Kiani Preserve, the same 8,000-acre ranch and winery where he and his family stayed during their previous trek to the Santa Ynez Valley.
the theme for this year’s celebration: Everyone has the power for greatness. About 450 families, friends, and classmates gathered in the plaza at City Hall, waving signs carrying messages themed with peace and equality.
The program, hosted by Isaac Garrett, began with native prayers, chants, and songs shared by the Coastal Band of the Chumash Nation. Garrett introduced the speakers, who hyped the crowd with the spirit of giving of themselves. County Supervisor Laura Capps highlighted how anyone can perform acts of service, encouraging everyone to volunteer.
After the speeches, a dance party ensued to kick off the march up State Street toward the Arlington Theatre. A live jazz trio awaited at the end of the march, where some people danced while others headed into the Arlington to listen to UCSB professor Lisa Sideris and the poetry and prose of students in the writing contest to raise the spirit of service and empowerment.
—Elijah Valerjev






Tby Callie Fausey
housands of Los Angeles County families have been forced to flee their homes as fires whip through their neighborhoods, destroying more than 12,000 homes, schools, and other structures.
Santa Barbara has welcomed these families with open arms. Now, schools are beginning to see a small spike in enrollment coinciding with the number of families seeking temporary shelter or permanent residence on the South Coast.
Schools in wealthier neighborhoods, and near popular hotels, are absorbing the most students.
Montecito Union School District has seen the highest enrollment. As of Tuesday, they have a total of 18 new students, with 20 additional students either in the process of enrolling or inquiring about enrolling.
“The students and families are lovely,” said Montecito Union Superintendent Anthony Ranii. “Each family’s story is different, but all have been deeply affected by the recent fires.”
Ranii said they’re fortunate to have staff “who all know something about working through tough times, as most of us went through the Thomas Fire and 1/9 Debris Flow.”
Some families have lost their homes, while others’ homes are still standing but surrounded by burnt areas without power, he said. For some, their schools burned down or closed indefinitely.
Some families knew one another from their previous school, and reunited at Montecito Union.
“The love and care that our teachers are showing as they welcome these newcomers brings tears to my eyes,” Ranii said.
Around the South Coast, other schools are accepting newcomers of their own.
Hope Elementary School District has one student enrolled so far and two families inquiring. Santa Barbara Unified has two students enrolled.
And Cold Spring Elementary School District had two new students start on
Tuesday and several other families still gathering information, all from the Pacific Palisades and Pasadena.
Cold Spring, along with Peabody Charter School, also partnered with local organizations to host day camps with fun activities and trauma counseling for children and families impacted by the fires last week.
Cold Spring held three camps with 75 families in attendance, and Peabody took in an extra 40 families who were on the waitlist.
“The entire Peabody staff really stepped up to make this camp happen on very short notice,” said Peabody Superintendent Demian Barnett. “Our community also stepped up in a big way.”
Barnett said they put out a call for specific items like socks, pajamas, toiletries, and more, and within hours they had enough supplies for every family to get what they needed.
“You probably couldn’t have bought a pair of socks within a five-mile radius of Peabody School, as Peabody’s parents had bought them all to donate to needy families,” he said. “It was amazing.”
Peabody has enrolled one family so far, and they expect more in the coming weeks, he added. “Peabody is the largest elementary in Santa Barbara and, therefore, very full. Still, we hope to be able to support any displaced families who move into our attendance area if we can.”
Families displaced by disasters are protected by the McKinney–Vento Act, which requires school districts to provide homeless students with the same public education as other students who reside in the district or school boundary area, according to the Santa Barbara County Education Office.
In other words, families may immediately enroll their children in local public schools where they are temporarily housed (e.g., hotels, shelters, friends/family), without the usual hurdles.
However, unlike other school districts, South Coast schools are community-funded or basic aid districts, meaning they don’t get more money per student. While some schools said that they might face budgetary restraints, or issues with class size, with the increase in enrollment, not one said it would stop them from accommodating families to the best of their ability.
“While there are some challenges to welcoming new families mid-year,” said Ranii, “the biggest effect we have seen is the enrichment of our school community as we welcome some amazing new students and families.” n
by Ryan P. Cruz
UC Santa Barbara announced the purchase of multiple properties in downtown Santa Barbara, encompassing a whole city block near the corner of State Street and East Gutierrez Street. The largest property in the deal, the 80-unit Soltara apartment complex, will be utilized as “economically viable” workforce rental housing for campus staff and faculty members, according to a statement released by UCSB officials Thursday.

Also included in the debt-financed acquisition is Reid’s appliance store on the corner of Anacapa and East Gutierrez which will remain in place through its five-year lease and an 18,000-squarefoot commercial space that was formerly home to Staples on State Street.
The property deal was approved by the UC Board of Regents back in November, and the sale is expected to close by the end of this month. The terms of the deal have not been disclosed, though university officials have said that the property will be “self-supporting,” with rents fully covering the mortgage payments.
UCSB’s decision to invest in three buildings in the heart of downtown Santa Barbara marks the first time the university will have a permanent presence in the city’s center. The move is also considered a major step toward the revitalization of State Street and the downtown area, bringing workforce housing and a new space for UCSB events and programming.
In the coming months, university officials will work with Santa Barbara city leadership, downtown businesses, and the campus community to brainstorm what ways the former Staples storefront could be used for community benefit. Some early possibilities include an event space for lectures or performances, co-work offices, or a community “innovation hub” and maker’s space.
“UC Santa Barbara is extremely proud to be part of the Santa Barbara community, and we are tremendously excited about the opportunity to establish a permanent presence on State Street,” said Chancellor Henry T. Yang. “The university has always appreciated collaborating with partners across the county for the betterment of the entire region, and we look forward to working with the city of Santa Barbara and the local community to identify possibilities for this new space that will support downtown and benefit the entire area.”
The residential piece of the property acquisition, an 80-unit apartment complex built by developer Peter Lewis and
completed last year, will be slowly transitioned into housing for university faculty and staff. About 50 of the units are currently occupied by tenants who moved in within the last year, and while all the current leases will be honored, the remaining units will be filled over time by campus faculty and staff.
The remaining units, if any, will be offered to local public government employees, school teachers, first responders, and other public agency workers.
“Although the initial number of available units is limited and a rental process for university employees is still being developed, significant interest among existing faculty and staff in downtown living is anticipated,” university officials said.
The 80 downtown units are part of UCSB’s plan to provide more housing for its students and workers. Another project bringing 540 workforce housing units along Ocean Road is slated for development over the next few years, and the UC Board of Regents recently approved designs to build 3,500 beds for students at San Benito and East Campus.
Santa Barbara City Administrator Kelly McAdoo said the city is “thrilled with the investment” UCSB is making downtown.
“We have been in conversations with key UCSB team members for a number of months discussing opportunities for partnership,” McAdoo told the Independent. “We look forward to the activation of downtown this will bring as well as the provision of critically needed workforce housing in our community.”
Mayor Randy Rowse a proud Gaucho graduate who arrived in Santa Barbara to attend UCSB in the ’70s and never left said that his alma mater making a move to downtown is the “town and gown” connection that has been “missing for a long time.”
“This is exciting news for the city and particularly for me as a Gaucho alum who has been working on inroads with UCSB since my council days,” Rowse said. “It’s also one more major energy injection to our downtown.” n














by Tyler Hayden



Discover the GetHairMD difference with Dr. Keller. Using advanced AI technology, DNA diagnostics, and innovative transdermal techniques, we’ve helped over 100,000 patients stop hair loss and regrow hair — all without painful injections. With over 40 centers nationwide, GetHairMD is here to help you achieve real results.
Many patients experiment with treatments of uncertain or limited value, often without clear evidence of their effectiveness. With our DNA testing and AI-powered hair analysis tool, you can make informed decisions, select the right treatments, and accurately track your results.

wo Santa Barbara County judges who preside over criminal cases now find themselves on the hot seat after the Commission on Judicial Performance reprimanded one for poor courtroom behavior and accused the other of willfully abusing his authority. The unrelated matters were made public in reports filed last month by the six-member commission, an independent state agency tasked with investigating allegations of judicial misconduct.
The first report details a 2023 incident during which Judge Thomas R. Adams became so angry and impatient with an attorney that he “raised his voice and rose from the bench when addressing her, threw off his glasses, and flung papers at her.” The commission noted the attorney, a public defender, was admitted to the bar only three months earlier and was so distressed by the incident that her superiors sent her home for the day. When contacted by the agency about his outburst, Adams attempted to discredit the attorney by stating, without evidence, that she’d had prior “issues” with court personnel.
The commission also referenced other disciplinary actions against Adams, who was first elected to the bench in 1983, ran unopposed in 2021, and currently presides over all South County criminal arraignments. He was previously admonished in 1993 for jailing a family law litigant for two days without a contempt hearing, “an egregious violation of due process,” the agency found.
He was further cited for, among other things, “failing to cooperate with other judges and court officials in the administration of court business”; “engaging in speech that would reasonably be perceived as bias, prejudice, or harassment” when he agreed with a defendant that a female attorney was “so beautiful”; and failing to disclose ex parte communication with a jury foreperson.
Moreover, the agency said Adams “made misleading statements” during its most recent investigation. Arguing that no discipline was warranted, Adams, who is 84 years old, assured the commission his retirement was imminent when his private communications at the time made it clear he had no intention of retiring.
Adams did not respond to requests for comment.
Two days after reprimanding Adams,
the commission issued a 40-page “Notice of Formal Proceedings” against Judge Michael J. Carrozzo, charging him with “willful misconduct in office” and “conduct prejudicial to the administration of justice that brings the judicial office into disrepute.”
The allegations are based on actions Carrozzo took between 2017 and 2020 on behalf of his then-secretary, Sara Eklund, who would later become his wife. Carrozzo, the agency claimed, represented himself as Eklund’s attorney during her divorce proceedings and after she was involved in a car accident, a major breach of judicial ethics and violation of the California Constitution that could warrant removal from the bench.
The commission also accused Carrozzo, a former prosecutor appointed by Governor Jerry Brown in 2014, of using his clout as a judge to fight a rent increase for Eklund, speed up a mattress delivery, and secure admission to a high-demand school for one of their children.
Among the most damning pieces of evidence against Carrozzo is a recorded phone conversation between himself and the insurance agent handling Eklund’s accident claim, wherein Carrozzo allegedly stated he represented Eklund.
During the early stages of the commission’s investigation, Carrozzo defended himself by claiming he hadn’t intentionally advocated for Eklund in an official legal capacity. The commission didn’t buy it, stating that his “statements and representations were false, misleading, and reflected a lack of candor with the commission.”
Last week, Carrozzo’s attorney, Heather Rosing, submitted a formal response to the charges. “Judge Carrozzo accepts full responsibility for his conduct,” Rosing stated. However, Rosing goes on, Carrozzo “cannot and does not accept responsibility for allegations that are false,” including making misleading statements to the commission, and she said none of the allegations showed he “failed to perform his judicial duties.” Therefore, Rosing suggested, her client ought to be privately or publicly admonished, not removed from office. In a separate statement, Rosing reiterated that the commission failed to show Carrozzo had made any substantive errors as a judge.
The matter will next be heard by a special master appointed by the State Supreme Court. n
Santa Barbara Metropolitan Transit District (MTD) is considering raising bus fares for the first time in 16 years as operating costs continue to rise and the city’s rising population leaves fewer options for federal funding toward public transportation.
MTD announced the proposed change prior to a series of public meetings and a community survey that will give the public an opportunity to weigh in on the two options for a higher fare structure, which could raise the price from $1.75 a ride to either $2.25 or $2.50. Without that additional funding each year, and without any additional increase in revenue, MTD could be forced to make service cuts, according to Planning and Marketing Manager Hillary Blackerby.

day, January 25, at the Downtown Library Faulkner Gallery, 2-3:30 p.m.; and Wednesday, February 5, at Carpinteria Library’s Community Room, 6-7:30 p.m. Meetings will have English-Spanish interpretation.


The first of the open-house-style meetings was held on January 15 at the Goleta Valley Community Center. Three more in-person meetings will be held in Santa Barbara and Carpinteria over the next two weeks: Thursday, January 23, at the Eastside Library’s MLK Jr. Room, 5-6:30 p.m.; Satur-
MTD is also running an online survey for community input from those who are unable to make it to the public meetings. The survey is available in both English and Spanish, and will also be available as a physical survey on paper at the downtown Transit Center and onboard MTD buses.
If approved, the new fee structure would begin on August 18, 2025. For more info, visit sbmtd.gov/farechange —Ryan P.Cruz

The Santa Barbara County Association of Governments (SBCAG) voted unanimously last Thursday to fund a new Metrolink commuter train service between Ventura and Santa Barbara counties scheduled to begin this October.
SBCAG has been working on a commuter train for about 15 years. The attempt in 2018 to introduce commuter rail plagued with a 4 a.m. start time out of Los Angeles Union Station and frequent delays to allow southbound trains to pass on the region’s single set of tracks was just over a year old when the pandemic hit. That service was canceled after ridership plummeted.
The new service uses a Metrolink train, a more flexible service that will start in Moorpark at 6:38 a.m., avoiding the ear-
lier L.A. start time and rail traffic, said Aaron Bonfilio, SBCAG’s Director of Multimodal Programs. The service would leave Ventura at 7:12 a.m. and pull up to the Santa Barbara station at 7:51 a.m. The returning Metrolink would leave Goleta at 10:35 a.m. on its southbound route, to arrive at Union Station at 1:30 p.m. The afternoon returns will be the existing Amtrak trains that leave Goleta at 4:25 p.m. and 6:30 p.m.
Bonfilio said that 2018’s ticketing had started at $5 each way in order to jumpstart ridership. They were looking to state funding to subsidize a $10 ticket per day and perhaps free rides for new riders.
Seed saving is a fun and easy way to connect to the circle of life!
Come share seeds and knowledge with other backyard gardeners, plant lovers, beekeepers, farmers and more. Be a part of the seed saving movement! Special speakers, exhibitors, children activities, free seeds & live music.








Santa Barbara, California USA
This year’s Local Food Hero award honors Mesa Harmony Garden, a Community Food Forest founded in 2010. Founding members include Hugh Kelly, Alice San Andres Calleja, Josh Kane, & Larry Saltzman, with hundreds of volunteers contribuJng Jme and energy since its founding. Beginning on an unused plot of land, the garden became a pracJcal demonstraJon site of permaculture & organic principles applied to urban food producJon, and now produces 2000 lbs. of fresh produce annually to share with the local Food Bank. Volunteers work together in the garden and orchard every Saturday, and hold educaJonal workshops, classes and a bi-annual plant sale
—Jean Yamamura
The new service is a one-year pilot program that will expand to three years if funding continues. It would cost $4.4 million a year and earn perhaps $500,000 in fares from a hoped-for 200 riders a day. The remaining details to be ironed out before the October rollout would cost about $450,000, to be shared equally between SBCAG and the Ventura County Transportation Commission. SBCAG’s funding comes from South County’s portion of Measure A sales tax.






The witty Erin Graffy de Garcia died Monday night after a battle with cancer during the past half-year. She grew up in Santa Barbara and was the daughter of Jeanne Graffy, a Santa Barbara city councilmember and 2nd District county supervisor, and was married to James Garcia. Graffy, whose brother Neal is also a well-known historian, expanded on her knowledge of the city as an author and historian, writing a number of the S.B. Historical Museum’s Las Noticias quarterly magazines, exploring subjects like the Visiting Nurses Association, portrait painter Clarence Mattei, the Yacht Club, and the city’s Italian Renaissance style. She served on many nonprofit boards locally and expressed her love of the city and its traditions by volunteering on the board of Old Spanish Days and acting as its historian. Graffy seemed to know just about everyone in Santa Barbara. Under her Society Lady hat, which she wore for many years as a columnist for the Santa Barbara Independent, Graffy wrote an instructive series of books called How to Santa Barbara with her tongue firmly in her cheek for anyone finding it difficult to understand why the sun in Santa Barbara rose in the south and set in the north.

Her book Old Spanish Days, celebrating the city’s public art, won a regional nonfiction book award for excellence. She and artist Tom Mielko won a silver medal in the Benjamin Franklin Book Awards for Animalia, which paired Mielko’s gorgeous pencil drawings with Graffy’s poems written under the influence of Edward Lear. Graffy wrote across all of Santa Barbara’s highly competitive media over the years, most recently publishing her “The Talk of the Town” column at Noozhawk. Kind and gracious, Graffy seldom turned down a request to share her deep knowledge of Santa Barbara history for an article. She was, however, reluctant to divulge her age, which was somewhere in her sixth decade at her death.
—Jean Yamamura

With arms gracefully raised to greet the 40th edition of the Santa Barbara International Film Festival, artist Mary Heebner (above) unveiled her “Bird Woman” design for the commemorative 2025 SBIFF Poster. The festival, which is now dedicated to Los Angeles and a partnership with Direct Relief to raise funds in response to the unprecedented wildfires in the area, opens with the U.S. premiere of Jane Austen Wrecked My Life . Running February 4-15, SBIFF showcases big name celebrity tributes along with films from 60 countries, with 52 percent directed by women.
The Santa Barbara City Council chose beauty and passion over practicality on 1/14, when they upheld an appeal of a decision to change East
Anapamu’s official street tree from Italian stone pine to coast live oak. That means, from here forward, the empty tree beds that edge the sidewalks on East Anapamu between Garden and Milpas will be re-planted with Italian stone pine saplings much to the joy of historic preservationists and community members. The decision effectively reverses a Parks and Recreation Commission ruling of last October that redesignated the street’s tree to native coast live oak.
Sheriff’s deputies responded to a report of a shooting on the 400 block of Woodley Road in Montecito on 1/15. An adult male victim was shot in the upper arm while walking his dog, authorities said. Deputies determined that the round came from inside a nearby house, as indicated by a bullet hole in a window facing the direction of the victim. They quickly arrested the resident, Bendar Albashir, 44, who had been giving aid to the victim. According to authorities, it does not appear that the victim and the suspect knew each other. The victim was transported to the hospital and is expected to recover. Albashir was booked at the Main Jail for negligent discharge of a firearm, a felony. He has since been released on bail. Detectives served a search warrant at Albashir’s home, where they recovered the handgun they believe was used. n
by Callie Fausey
For Island View Preschool, a new daycare in Santa Barbara’s Riviera Business Park, it took nearly two years and $180,000 to open their doors this past November about double the time and quadruple the expected cost.
Their fence alone cost $30,000.
“There’s a lot of red tape involved to have children in a space,” said Executive Director Juniper Dwight, a Montessori teacher with 20 years of experience. “We just persevered.”
But Santa Barbara desperately needs more childcare options, particularly for low-income families and working parents. With a shortage of 9,000 childcare spots, long waitlists have become common, according to the Santa Barbara Foundation.
One reason Dwight started the school was because her daughter couldn’t find quality childcare for her own kids, she said. As such, Dwight’s grandchildren were some of the first kids enrolled.


A difficult hurdle to clear when opening a daycare is simply finding a space.
However, for Dwight, a location basically fell into her lap.
The Yardi family, known for being one of Santa Barbara’s philanthropic housing developers, bought the Riviera Business Park in 2022. Jason and Robin Yardi offered Dwight their children’s former preschool teacher a space in the park, but she was working on opening another school at the time, the Manzanita Montessori School in Ojai.
“When the space was offered to me, I thought, ‘If there were two of me, I could do this,’ ” she laughed. But then a lightbulb went off.
She thought of her friend Cathy Smith, a teacher of 30 years, and called her up, asking, “Whatcha doing? Wanna open a school?”
After pulling in Smith’s sister, Maida, they immediately went about establishing themselves as a nonprofit, which meant reduced rent from the Yardis, and they were off. They had the space. They had the manpower. The rest should be easy enough, right?
Nope.
“So many people have been shut down or given up on their goal to start a childcare center because it’s so hard,” Dwight lamented.
Their fence was so expensive because their building happens to be a city historic landmark. It needed to be a wrought-iron fence to match the park’s architectural aesthetics, as well as meet ADA and childcare licensing requirements.
And that was just one of the many hoops they had to jump through. Various factors contributed to a longer, more costly development process, explained Elias Isaacson, the city’s community development director.
That included state and local permitting, meetings with surrounding businesses, loans, licensing, staffing, city commission meetings, installing drywall, and inspections from different agencies.
Challenges also arose from the location, location, location. The park is not zoned to allow “childcare by right,” in technical terms, which necessitated a conditional-use permit.
Unexpected road bumps, including a miscommunication from the city’s building department staff concerning a different permit, led to further delays. However, the women did have the help of the city’s newly hired ombudsman, who assisted them in the complex endeavor.

“It was by no means an easy process,” Isaacson said, praising the women’s perseverance.
This process is often “restrictive, slow, and costly,” explained Eileen Monahan, a childcare consultant in the city who helped Island View navigate city regulations.
Nearly every operator she’s worked with, she added, has become discouraged at some point sometimes even before getting started.
Tight margins make permitting costs prohibitive and add to the difficulty of hiring experts to navigate the process. In most areas, building a new facility is not possible due to land costs, so most new centers are retrofits of buildings created for other uses.
“Even seasoned professionals face challenges due to a shortage of resources and complex and varying policies across communities,” she said.
Throughout the process, Island View had to pay their rent with no income.
“Because of the delays that we underwent in our permitting process with the City of Santa Barbara, we have a cashflow crunch that we will be dealing with for some time,” said Maida Smith. “The good news is that we have already received rave reviews from our new students and families.”
They could not have done it on their own. But luckily, they didn’t have to.
Island View’s landlords, the Yardi family, were incredibly supportive, they said, and helped cover the cost of the fence since it is a permanent fixture on the property.
Donations, grants, and technical support poured in, including from the Santa Barbara Foundation (SBF) and the Children’s Resource & Referral (CRR) of Santa Barbara County. They also received donated time and advice from architects, contractors, and others in the community.
“The process is daunting,” said Island View Director Cathy Smith. “There is a lot to be said for naivete, optimism, and perseverance. I have to say we found true support from a lot of key players in both the [city’s] planning department and the building department, too.”
The school’s five teachers stood by them throughout the

process, Dwight said. On November 18, 2024, the school opened for a small number of preschool-age students, and in December, they started their first infant class.
While admission currently ranges from $650 to $1,775 per month (based on age and schedule), Dwight said they want to raise money to eventually provide scholarships and help working families who could not afford it otherwise. “We believe education is for everyone,” she noted.
“Finding a preschool turned out to be more challenging than we had imagined, especially as first-time parents not realizing how early we were supposed to begin the waitlist process,” said Christina Wiesendanger, a parent who works at the clothing company Toad&Co. “We’re so happy to be able to enroll our daughter in Island View. It is, quite literally, next door to my office, cutting my commute time and allowing us to spend more time with our daughter both before and after drop-off.”
The childcare landscape in Santa Barbara County may seem bleak SBF’s needs assessment found just one licensed space for every 10 infants and toddlers but there’s progress underway.
Goleta, for example, updated its zoning policies to make it easier to start centers and recently approved $250,000 for childcare improvements. The county has also made changes, and state reforms now exempt family childcare homes from local permitting.
In 2023, the Santa Barbara County Board of Supervisors allocated American Rescue Plan Act (ARPA) funds to support childcare recovery efforts, including $1.125 million to SBF to collaborate with the CRR and County Education Office to improve access to childcare by 2025.
Through this ARPA-funded project, SBF and CRR have analyzed land-use policies and trained planners to prioritize childcare. “It’s encouraging to see their enthusiasm for policy changes and willingness to help,” Monahan said.
The Board of Supervisors also approved nearly $200,000 for a partnership with Goleta Union School District and Harding School Foundation to expand after-school programs for older kids.
“Quality childcare is vital not just for children’s development but as support for working families and the local economy,” Monahan noted. “Expanding access is an investment in our community’s future.”
Key strategies include incorporating childcare into housing developments, streamlining regulations, reducing costs, and increasing investments to open more centers.
Island View’s founders hope their story will inform and inspire others, and nudge the city to find ways to expedite the process. “The city has a crisis, and there are people willing to help,” Dwight said. “We need to make it easier for more people to open quality childcare centers in this town.”
Island View Preschool combines the philosophies of Reggio Emilia, Montessori, and Outdoor Classroom. It is open Monday-Friday, 8 a.m.-5:30 p.m., and provides care for infants and children up to age 5. While their infant program is currently full, the school is accepting applications for their preschool program. Learn more about how to apply at islandviewpreschool.com/admissions

Saturday, February 8, 2025
11:00 AM - 03:00 PM

3400 Calle Real Santa Barbara, CA 93105
• 70 Partner Agencies

• Free Haircuts, Health Screenings, & Vaccines
• Live Music from 80s cover band JOYSTIX and SAN MARCOS HS JAZZ ENSEMBLE
• Kids Activities
• Lunch for the first 500 attendees
• Door Prizes and more!





GENEROUSLY SPONSORED BY:










Ihave always been proud to be an American. That is, until the last eight or nine years. Bad behavior started becoming the norm back then and has now reached a crescendo.
I did not vote for the current president, but I decided this time to accept it, as he won the majority of votes. I made a vow to myself to not let anything that happens in the next four years get my blood pressure up.
But, when Mike Pence, Barack Obama, and the Clintons are booed as they entered the Capitol Rotunda before the inauguration, I turned my TV off. What ever happened to decorum? How were these people raised, by a pack of jackals? And these are our elected officials!
It makes me sick.
—Mary Overall, S.B.
should not be allowed to launch 100 rockets in a year. The environmental impacts, and impact on the quality of life of hundreds of thousands of human residents in our region, should be obvious. Aside from the gases and particulate matter that are deposited into the atmosphere, there is a non-zero risk of explosions and debris raining down over large areas. No plans or dedicated resources exist to clean up such debris, to my knowledge.
In terms of noise pollution, one sonic boom at a very early morning hour rattled my dwelling so severely I woke up thinking that a tree had fallen on the roof or an earthquake had struck. If dogs in the neighborhood start barking, my cat runs to hide, and my heart rate increases with panic, it stands to reason that wild animals are also negatively impacted.
I recall a second boom occurred when I was in a classroom. Students started asking there was an oncampus emergency to which we needed to react. It is for similar reasons that Air Force and Navy aircraft almost never break the sound barrier near populated areas.
It is no secret that Falcon 9 launches with Starlink payloads further enrich the richest person in the world, who is known to assert anti-democratic and racist viewpoints, and deliberately spread misinformation for political purpose. Catering to his organization degrades the reputation of Space Force and public perception of spacefaring ventures.
Some will point out the “national security” goals associated with the increased launch cadence proposed by the Department of Defense. The reality is that the U.S.A. already has a massive nuclear arsenal,


the largest air force in the world, the second largest navy in the world, and more military bases across the globe than any other country. We have the most expensive and advanced fighter jets, bombers, and submarines, and we are part of the largest and most powerful military alliance in history (at least at time of writing). I do not accept their justification. Militarization of space should be recognized as a potential cause of a third world war, just as arms buildups in the early 1900s and 1930s contributed to the first and second.
—Zachary Eichert, S.B.
Barry Maher’s January 9 Voices article was both amusing and alarming.
Good on ya, Barry.
The whole idea of building an eight (EIGHT!) story complex behind the mission reminds me of the Munger Hall debacle-kerfuffle at UCSB a couple of years ago.
Munger Hall was thankfully kiboshed by the good people of … everywhere.
Let’s do the same here, good people.
—LeeAnn Morgan, S.B.

Editor’s Note: Here we run a corrected version of the image that ran with Barry Maher’s piece. The editors got the height of the mission wrong, which this image corrects to 87 feet at the bell towers.
The Martin Luther King Jr. service on Thursday, January 17, was held at Trinity Lutheran Church, not at the United Methodist Church.
The Independent welcomes letters of less than 250 words that include a daytime phone number for verification. Letters may be edited for length and clarity. Send to: Letters, S.B. Independent, 1715 State St., Santa Barbara, CA 93101; or fax: 965-5518; or email: letters@independent.com. Unabridged versions and more letters appear at independent.com/opinions

BY DAVID OBST
For the last few hundred years, virtually no American family named their son Benedict. That’s because Benedict Arnold has become the exemplar of someone willing to sacrifice his country for money. Benjamin Franklin wrote of him, “Judas sold only one man; Arnold, three million.” There will also be no American boys named Elon for the next few centuries because we are very close to giving Elon Musk the power to be our next Benedict Arnold.
The British paid Arnold the equivalent of about $5 million in today’s dollars. The Chinese have paid Musk billions of dollars through loans and market exclusivity.
Among other things, Musk has benefited from his win-win dealings with China, as he is the only car company in China that is not required to partner with a native Chinese firm. In addition, more than one-half of Tesla’s cars are now made in China.
In China today, it is almost impossible for any other car company to earn a profit. General Motors took a $5 billion write-off for their company late last year and is shutting down its presence in China. Others are quickly following. Yet, China, in less than one month of negotiations, loaned Musk billions of dollars to help build his Tesla car factory. They then gave him an additional billion and a half to build a factory to produce the batteries for all electronic vehicles. So, why does China care so much for Mr. Musk? The answer is SpaceX, and specifically, a division of SpaceX called Starlink.
Musk’s company performs many functions for the U.S. government, both civil and military branches. Among its most secretive activities are launching classified satellites for the National Reconnaissance Office and providing encrypted communications and observational activities with Starshield, a military version
of Starlink designed for government use.
America has awarded Starshield satellites billiondollar contracts to build a network of hundreds of spy satellites. These satellites can track targets on the ground and share data with U.S. intelligence and military officials. They are an integral part of a new missile defense system we’re building to give America the potential to sense, target, and destroy nuclear missiles aimed at our cities and missile silos. They can track a missile launch from its inception. Data that guarantees America will never again face another Pearl Harbor.
The National Reconnaissance Office (NRO) is the largest and best-funded intelligence agency nobody has ever heard of. A vital part of the American intelligence community, it is an agency of the United States Department of Defense. Its mission is to design and build reconnaissance satellites for our government. It’s also a world unto itself.
The NRO works with the Space Development Agency (SDA) as part of the United States Space Force. Their job is to provide direct reporting on all space technology. Specifically, they are tasked with putting space-based missile-tracking satellites in orbit. The U.S. Air Force manages them. They intend to have more than one thousand satellites in the air by the end of next year. A centerpiece of their operation will be the Musk-owned satellite constellations used to track and detect any nuclear missile launched by an enemy against America.
Before we come to what the ramifications of all this mean to you, let’s take a quick look back to late last year when the government was almost shut down when Musk objected to the legislative bill to fund the government.
The bill was killed because it prohibited or required notification of overseas transactions involving China in sectors like the ones in which Musk was involved. A new bill was drafted and passed instead. This new

bill removed those prohibitions on Musk so he could continue to build and work with the Chinese on his multibillion-dollar plants in the People’s Republic and continue to work with the NRO to provide top-level intelligence to our missile defense systems.
It’s not as if our generals and the people they work with were blind to the threat of having Musk in charge of our most sensitive national security information. He has been refused top security clearance for his own satellite data. The Air Force and more than nine of our closest allies have demanded that he not be given such clearance to Starshield’s top-secret information.
This all changed on January 20, when Trump became our new commander-in-chief. Now a man who owes China billions of dollars will be in charge of the most important early warning system our military has against a hostile attack from the People’s Republic. If, as he’s already once threatened to do in Ukraine, he makes his Musk-owned Starlink data unavailable to us, we will be sitting ducks for potentially catastrophic attacks from our enemies.
The primary reason humans are still around in the nuclear age is the premise of mutually assured destruction. That means if you send a nuclear weapon against us, we’ll strike back. However, it’s a whole new ball game if an enemy can wipe out our retaliatory force before we know we’re at war.
Putting a man like Elon Musk in a position where he owns and operates America’s first line of nuclear defense is not only stupid but potentially fatal.
Giving Musk clearance to his company’s data means that the Chinese may have open access to it. This data is our only protection against a surprise nuclear strike. It must not be allowed to happen.
I’m not suggesting that Musk will betray us, but George Washington was positive that Benedict Arnold was a loyal American. We can’t afford to make the same mistake twice. n

Ruby Glass, loving wife, mother, grandmother and great grandmother, passed away peacefully January 3, 2025 surrounded by her loving family. Ruby had just recently celebrated her 100th birthday and passed away after welcoming the New Year.
Ruby was born September 25, 1924 in Paris, Texas to Hugh and Alma (Allen) Harvey. She was the oldest of 4 children. Ruby met George while attending Paris High School. The two were married in 1942 after graduating. George enlisted in the Marines and was sent to San Diego for basic training. Ruby and George were then stationed in Santa Barbara, where he was deployed to the South Pacific during World War II. Ruby went to work at the local Kress’ Department Store while she waited for George to return from overseas.
After the war, George returned to Santa Barbara and began working at Jordano’s as a meat cutter. Ruby and George then started their own business, the Handy Food Market, in 1953. It was a small, familyrun grocery store on Milpas Street. George ran the meat department and Ruby worked the register. The store soon became popular with the families on the east side and the Riviera and was the place to not only shop, but a hub to visit and chat with one another. Ruby liked the chatting part the best. After closing the Handy Food Market in
1969, she began working as a Teacher’s Aid for the Santa Barbara School District. She loved working with the teachers and students until she retired at the age of 76.
George and Ruby had 3 boys, George (Tom) Jr., Ron, and Rick who all helped at the store as they grew up. They were members of the First Methodist Church and very active in the boys’ school and sports activities.
In what little spare time she had, Ruby enjoyed many activities. This included square dancing with the Fairs & Squares, ballroom dancing, swing dancing, and cha-cha. Ruby always felt at home on the dance floor with George. They were so good together, they even won first place in a “Dancing with the Stars” competition at the age of 88 on one of their many Princess Cruise trips. Ruby was an avid golfer, water skier, poet, and motorcycle rider. Ruby traveled behind George as a passenger across the USA and Canada on their motorcycle after retiring. They also traveled hundreds of thousands of miles sailing on cruises and have seen almost every corner of the world, but they always looked forward to their return to Santa Barbara.
Ruby and George were active supporters of the Elks Club and could be found on the dance floor every week. They were members of the Hits & Misses Golf Club and helped with many of the golf tournaments at Santa Barbara Community Golf Course for many years. Ruby and George, with the help of their sons, built the family cabin in the Los Padres Forest.
Ruby is preceded in death by her beloved George, as well as her son Tom and is survived by her son Ron and his wife Barbie, her son
Rick and his wife Debi, 4 grandchildren, and 8 great grandchildren.
A special thanks to Central Coast Hospice & Vista Del Monte for their loving care.
Graveside services will be held at Santa Barbara Cemetery on Wednesday, January 15th at 10am. A reception will follow at 11am at Mulligan’s.
Brian Thomas Robertson
8/19/1941 - 11/13/2024

It is with heavy hearts we announce the loss of Brian Robertson, who passed away peacefully in his home on November 13, 2024.
Brian Thomas Robertson was born August 19, 1941 – the eldest son of parents Dr. Robert Robertson and Dorothy Robertson. Brian’s early childhood was spent in La Jolla, CA and in Hawaii while his father served in the U.S. Marine Corp and U.S. Navy during World War II. Following the war, the family settled in Santa Paula, and Brian’s youth was spent between the family ranch in Aliso Canyon and the family beach house on Faria Beach.
A graduate of Santa Paula High School, Brian attended University of Colorado, Boulder initially as a premed student. Mid-way through his studies, Brian’s true calling presented itself by way of a summer job at a Boulder travel agency where he worked as a ticketing agent. By 1962, Brian returned to California, settling into Santa Barbara as manager of the American Express Division for Booher Travel. Brian purchased
Booher Travel in 1970, and the legacy of Brian T. Robertson International/Robertson International Travel Consultants began. Brian’s career in travel spanned 56 years, and took him to over 100 countries, before his eventual retirement from the business in 2017.
Though his love of travel was great, Brian’s biggest and truest love was of his wife of 37-years, Judy. A true yin and yang, Brian and Judy both complimented and completed each other in every possible way.
Brian is preceded in death by his parents and two younger brothers (Robbie and Bruce). He is survived by his loving wife Judy, his son Scott A. Robertson, daughter-in-law Devon Sedlacek, and four grandchildren. Celebration of Brian’s life will be held privately.
Jaimie Curran
9/7/1971 - 12/26/2024

Jaimie Eleanor Kathleen Curran, a cherished and caring mother, daughter, sister, and friend, left this world unexpectedly on December 26, 2024, at the age of 53.
Born on September 7, 1971, in Queens, NY, Jaimie was the beloved daughter of Michael Curran and Kala Kunze. After graduating from high school, she pursued her passion for helping others by attending Mount Saint Mary’s University, where she earned her certification as a Physical Therapist Assistant.
Early in her career, Jaimie met Dan Warren, with whom she shared the joy of raising two children, Paige
and Aidan. Her children were her greatest pride, and she devoted her life to showing them the true meaning of unconditional love. She constantly encouraged them to embrace who they are, strive for their best, and remember that they were always enough.
Jaimie found immense fulfillment in her work at Cottage Hospital in Santa Barbara. As a compassionate and dedicated professional, she brought light, laughter, and comfort to her colleagues and patients alike.
Outside of work, Jaimie’s heart belonged to nature. She found serenity in outdoor adventures, whether running through trails, competing in triathlons, or walking along the beach with her loyal dog, Lacey. Her boundless energy and zest for life inspired all who knew her.
Jaimie’s kindness, warmth, and generosity left an indelible mark on everyone she met. Her passing leaves a void that cannot be filled, but her memory will forever remain a source of love and inspiration for her family and friends.
Jaimie is survived by her children, Paige and Aidan, her father and stepmom, Michael and Aretha Curran, her brother Sean, and countless friends and colleagues who loved her.
A celebration of Jaimie’s life will be held from 2 to 4 p.m. on February 3, 2025. Please contact Aretha Curran at arecurran@gmail. com for more details. In lieu of flowers, the family kindly requests that donations be made to the Santa Barbara Humane Society, a gesture that beautifully reflects Jaimie’s unwavering compassion, her love for animals, and her lifelong dedication to helping and supporting those in need. Rest in peace, Jaimie. Your light will continue to shine in the hearts of all who love you.

It is with a heavy heart that we say goodbye to a great man, Michael Angelo Lugo. His death came as a sudden and unexpected loss, leaving a profound void in the hearts of his family.
Mike was a self-employed professional, a gifted craftsman, designer, and builder whose creativity and skills were evident in every project he undertook. He was a gentle, giving man who worked tirelessly to ensure that his family had everything they needed and felt unconditionally loved.
Michael was a wonderful father and son. He cherished spending time with his children and grandchildren, particularly enjoyed attending his grandchildren’s events. They were the loves of his life.
He will forever be cherished and remembered by his family, including: Mother, Patricia Richardson. Mother of his children, Bridgette Lugo. Children, Michael Angelo Lugo, Jr. (Melissa), Amanda Hernandez (Baltazar), Bethany Lugo, and Shelby Lugo. Grandchildren, Nehemiah Marcelo, Shiloh Angelo, Kingston Michael, Arabella Bexley, Leia Lani, Andrew JuanCarlos, and Meadow Michelle. Siblings, Patricia Mata, Charles Richardson (Debbie). Nephews and nieces, Joe Aldana, Lydia Aldana-Vasquez, Daniel Richardson, and Briana Richardson.
He is preceded in death by his father, Charles Richardson, Sr.
A Mass in his honor will be held on Saturday, February 1, 2025, at 10:00 AM at Holy Cross Church, 1740 Cliff Drive, Santa Barbara.
Vander Ark
7/6/1933 - 12/13/2024

John Bernard (Van) Vander Ark was born in Byron Center, Michigan to parents John and Alyda Vander Ark on July 6, 1933. He was the middle child, and only son. He enjoyed an active childhood. He began piano lessons in first grade; outdoor games were allowed only after first practicing piano under his mother’s watchful eye. He added trumpet lessons in third grade. When in Byron Center Junior High, he marveled at the variety of band instruments and the band director’s ability to play all of them. Thus, he embarked upon his life’s calling, which was to become a “complete instrumentalist” and to share the joy of making music with literally thousands of people. In addition to traditional band instruments, Van learned to play the organ and played for church services for more than fifty years.
Van is survived by his loving wife of 69 years, Lorraine; by son Larry, his wife Sabrina, and their children (Krystal, Amanda/Marlan, and Danielle/Muhib); also by son Mark, his wife Laurie and their children (Aimee and David); by his sister Bonnie Van Wyke; and his brother-in-law Donald Vermeer.
Van’s education shifted to Redlands, California, in 1948, where he graduated from Redlands High School in 1951. He returned to Michigan to attend Calvin College in Grand Rapids, where he majored in Music Education and met his future wife, Lorraine Vaalburg. They were married
in Hanford, California, on August 19, 1955, and three weeks later, Van enlisted for a 2-year stint in the U.S. Army. His longest assignment was to Fort Bragg, North Carolina, where he participated in the 82nd Division Band.
Van was honorably discharged from the Army in 1957 and moved to San Jose to complete one year of graduate work at San Jose State University. From there, he and Lorraine moved to Santa Barbara in 1958 and took teaching positions. Van was hired as the Music Instructor at La Colina Junior High School in 1959, the year the school opened. Van continued teaching at La Colina for his entire career, retiring 34 years later in 1993. The school honored him by naming the building where he taught the “J. B. Vander Ark Performing Arts Wing”.
Van was skilled at capturing the attention of a classroom of more than 100 junior high school students. He was an excellent instructor with high standards for every Concert Band, Jazz Band, Marching Band, and Orchestra he directed. He loved being with his students and found ways to challenge them. Later in his career, his classes included children of students. For many years after his retirement, he would still recognize former students upon meeting, sometimes remembering their names but always remembering what instrument they had played in his classes. Over his career Van directed nearly 600 concerts.
Van was retired for a couple of years, yet musicmaking continued to be a passion. In 1995, with Lorraine’s help, Van started the Prime Time Senior Band in Santa Barbara. The first meeting of the band included 22 experienced musicians (some who had not played in many years) and 11 complete beginners. Van and Lorraine were both very active with the Prime Time band for 20+ years,
and the band continues to have about 60 members today. A few Prime Time band members originally had Van as their La Colina Junior High band teacher. For recreation, Van and Lorraine enjoyed traveling to new places and spending time in Bend, Oregon. Van was a sports enthusiast, playing tennis and softball for many years. He especially enjoyed watching UCLA basketball.
Van and Lorraine have resided at Samarkand Retirement Community since 2015, where Van enjoyed playing pool, visiting with friends, and playing the piano for special occasions.
Van had a lifelong faith in Jesus Christ and eagerly anticipated meeting his Savior upon finishing his time here. He passed away on December 13 at 6:40 AM. He is greatly missed. There will be a memorial service at 10 AM on Saturday, February 8, at the First Presbyterian Church, 21 East Constance Avenue in Santa Barbara.
Santa Ynez High School and stayed in the Valley through his life namely Buellton. His passion was art and is natural ability can be seen throughout the Valley. Many of Mel’s signs and logos are painted on countless businesses eqt, trucks, trailers and race cars.
Mel would sure leave you with a smile. Such a great man will be missed by allthank you Mel. You’re definitely a gem!
Rest In Peace.
Join us for a Celebration of life on February 1, 2025 at the Mendenhall Museum 2pm 24 Zaca St. Buellton CA.
10/12/1968 - 12/18/2024

Melvin Charles Harris 4/20/1954 - 12/25/2024

It is with great sadness to inform you of the recent passing of Melvin Charles Harris during the early evening of Christmas 2024. Born on April 20, 1954, in Cochabamba Bolivia. Mel returned to the States in a few short years when his father Colonel Fred Harris, Veterinarian Surgeon, stationed at Fort Hood Texas and finally at Fort Wainwright in Alaska for the final and last move with the US Army.
The family retired from the Army in Santa Ynez Valley where Mel graduated from Santa Ynez Valley where Mel graduated from
Beloved son, uncle and friend, Daniel G. Raabe born October 12, 1968, of Santa Barbara, CA, died at Cottage Hospital after losing his fight with leukemia on December 18, 2024.
He was born in Santa Barbara in 1968 to parents George A. Raabe and Susan A. Raabe. The youngest of 13 siblings. Dan was well read and well traveled. He could always make the best of any situation and will always be remembered for his humor.
Daniel was preceded in death by his parents George and Susan, his sister Delia and Susan and survived by 10 siblings: Kathy, Patricia, Michael, Ellen, Chuck, Frances, Josie, Leo, Bridget and Meg as well as 17 nieces & nephews, 18 great nieces & nephews and 1 great great niece.
A remembrance of life celebration will be held on Saturday, February 1st, 2025 at the Pat O’Malley Fieldhouse at Girsh Park, 7050 Phelps Road, Goleta, CA 93117 from 2:00pm to 4:00pm.






















BY VICTORIA RISKIN | PHOTOS BY INGRID BOSTROM








This month marks the 55th anniversary of the massive Santa Barbara Channel oil spill that marked the beginning of the environmental movement in the United States. The first Earth Day celebration, on April 22, 1970, was held in Santa Barbara the year following the spill.
At the time, it was the largest offshore oil spill in the world and deeply impacted a growing global concern about the ecological destruction from oil disasters. One of the champions in this struggle regionally has been Linda Krop, the lead lawyer at
Mthe Environmental Defense Center headquartered here in Santa Barbara. The following interview with Krop will remind readers that the struggle to protect our environment is ongoing.
Interviewing Krop is Victoria Riskin, a longtime Santa Barbara advocate for environmental preservation and the publisher and founder of Bluedot Living, a national publication focusing on ways to mitigate climate change and a partner with the Independent on the Green Guide magazine, the next Santa Barbara issue of which will be published in April.
any Santa Barbarans might assume oil drilling in the Santa Barbara Channel is a thing of the past, that the platforms will be decommissioned as we move toward a cleaner energy future. That’s not true. Yet.
Companies have drilled for oil off Santa Barbara’s coast for more than a century. But on January 28, 1969, a blowout on Union Oil’s Platform A caused a massive oil spill in the channel. When it was finally plugged, 4.2 million gallons had polluted the ocean and the beach. At that time, it was the largest oil spill in U.S. history.
The sight of the Pacific Ocean, with its blackened waves silently hitting the shore, too ladened with oil to make a sound, as thousands of seabirds and animals lay dying along its beaches, shocked the world.
Here in Santa Barbara, groups formed to prevent such a disaster from ever happening again. The Environmental Defense Center (EDC) was born from this movement. Eventually, it became the leading legal group fighting to protect the region’s land, air, and the people who live here from ecological destruction.
In 2015, another oil spill occurred at Refugio State Beach. Thick crude oil from an ExxonMobil platform was moving through a badly corroded pipeline, then belonging to the company Plains All American. It ruptured undetected, without a shutoff valve, and spilled around 140,000 gallons of oil, polluting the ocean and the land.
Linda Krop and the EDC team were part of the legal battles that forced the companies responsible to pay more than $700 million in liability and criminal negligence damages. The platforms were shuttered, and oil drilling ceased along the Santa Barbara Gaviota coast. ExxonMobil didn’t give up. In 2020, it took another stab at extracting offshore oil from Santa Barbara, planning to circumvent the corroded pipeline by trucking the oil to processing facilities in Kern County. The company proposed that a fleet of trucks would transport 70,000 barrels a day 150 miles up the 101 and 166 highways.

Krop and her team again rallied, arguing before the California State Lands Commission and showing that trucking accidents on these routes made such a plan extremely dangerous both to people and the vulnerable ecosystems bordering the route. The commission voted 3-2 to deny Exxon a needed


Now offshore oil production is again being proposed. ExxonMobil has entered into an agreement to transfer the leases for its local operations to Sable Offshore Oil, offloading their assets to a new company that claims it can repair the “anomalies” on the rusty pipeline. To restart, Sable requires permits or permissions from various state and local agencies, including the Santa Barbara Planning Commission and Board of Supervisors. So far, Sable and Exxon are winning the permissions at the state and local







Let’s talk about Sable Offshore Oil. Now that ExxonMobil has transferred the leases for all their operations in our region to Sable, when could the oil begin flowing? Sable wants to take the fast track to restart and doesn’t want to wait for approvals or to construct a whole new pipeline. They are just going to restart the existing pipeline it’s such a dangerous proposition because we know it’s corroded. Even if they put in new valves to detect leaks, as required by state law, that doesn’t prevent a leak.
The county’s own environmental experts determined that, with this pipeline, there is a risk of a spill every year, a rupture like 2015 every four years, and a spill that could be almost twice the size of what happened in 2015. We know what the consequences are so we’re fighting this aggressively.
But recently, the Environmental Defense Center released copies of notices of deficiency sent to Sable by an agency of Cali fornia’s Department of Fish and Wildlife stating that Sable’s oil spill response plans were inadequate. The agency is the Office of Spill Prevention and Response (OSPR) and it is responsible for making sure there are good plans in place to prevent or minimize the effect of oil spills.



I sat down with Krop at Han dlebar Coffee (and again on Zoom) to understand what’s going on. Could it be possible that a company with no track record would be allowed to to restart oil production and transport it through a pipeline with a well-documented history of corrosion?

What do you think will happen if the pipeline and the platforms do restart? If they restart, it would increase oil production in California by 20 percent. It could possibly double all of the county’s greenhouse-gas emissions. So, it’s really a step backward. We’re all very, very worried about what the Trump administration could mean for offshore oil development in California. I think the biggest risk to California is the Sable project.





“It could be,” she said, speaking with crisp clarity, though occasionally adding an ironic laugh at the incredulity of it all. She walked me through the work the EDC staff, particularly attorney Jeremy Frankel, was doing on the Sable project, history and the labyrinth of local and state agencies involved. Alex Katz, the Environmental Defense Center CEO, joined us and filled in details.


Really? Why not the whole coast? The Trump administration is limited in what they can do off California. One of the areas that has the most remaining oil and gas reserves is the Santa Maria Basin, between Point Conception and the San Luis Obispo County border. We have a new National Marine Sanctuary there now, so they can’t drill there anymore. Perhaps more importantly, President Biden withdrew all remaining areas offshore California from federal oil leasing. Combined with California’s ban, this means that no new areas can be leased for oil and gas development off California. So, to me, the biggest threat of offshore oil and gas off California is the Sable project.
These recent documents seem to say that Sable has not shown the State of California a good action plan if there is an oil spill, either on land or offshore. Is that right? Or is this just a procedural hiccup for Sable? Maybe it just didn’t fill out the forms correctly. Or is it more substantial than that? These deficiencies are very serious. Although some of the initial deficiencies were minor, the continuing and remaining deficiencies are quite alarming. According to the most recent notice for the onshore pipeline, Sable still needs to submit a complete Risk and Hazard Analysis, including the size, frequency, cause, duration, and location of a potential oil spill, and the control measures that may mitigate such risk, or what the potential is for spills even after such control measures are implemented.
Sable also needs to submit a complete Off-Site Consequence Analysis, which sets forth the potential consequences of a spill, e.g., where and how far the spill may spread, and what environmental, cultural, and economic resources may be impacted.
These two analyses go to the crux of an oil spill contingency plan, and the fact that Sable has received three deficiency notices is a strong indication that the company cannot safely operate these facilities. Similarly, for the offshore pipeline, Sable has received two deficiency notices for not submitting an adequate Risk and Hazard Analysis.
What does this mean for Sable’s very aggressive timeline for getting Exxon’s old operation up and running? Sable cannot operate the pipelines without approved oil spill contingency plans. Sable’s deadline to resubmit the plan for the onshore pipeline was January 16; OSPR will review it. Sable’s deadline to resubmit the plan for the offshore pipeline was December 22; it is under review now. Since we don’t have the underlying documents, we don’t know how long it will take Sable to comply, but these are very substantive requirements.
What does it mean for the State Fire Marshal and other agencies that must give approval? These plans are relevant to some agencies. For example, the County of Santa Barbara cannot approve the change of operator from ExxonMobil to Sable without an approved oil spill contingency plan.
And, perhaps most importantly, what difference does it mean for Sable investors? First and foremost, the lack of an adequate oil spill contingency plan for a pipeline that caused one of the largest spills in California history (costing the owner $750 million) and is likely to cause another spill (according to the county’s expert analysis) should be of concern to potential investors.
Second, Sable’s inability to submit an adequate plan despite several months and repeated warnings from the state is indicative of the company’s ability to responsibly and safely operate these facilities. Sable also has multiple Notices of Violation from the California Coastal Commission, Regional Water Quality Control Board, and California Department of Fish and Wildlife.
And then there was the 2015 oil spill, which many people remember. The oil spill occurred in the morning. You had this oil spilling out of this culvert onto the beach, into the ocean, and nothing was happening. By the afternoon, everyone was standing around waiting for the Coast Guard to show up, but nothing was happening. When the Coast Guard captain showed up, it was early evening. At the press conference, the Coast Guard captain who was head of the Unified Command overseeing the oil spill response said, “Now it’s dark, it’s night, and we’ll wait for the morning, and we’ll come up with a plan.”
How could there not have been a plan? I knew, having worked in this field for decades, that they had a plan! Every oil and gas facility, whether it’s a platform or a refinery or a pipeline, has to have an oil spill contingency plan so you know what’s going to happen if there’s an accident. They just didn’t use it.
The other thing that caused so much oil to spill unnecessarily is that the owner of the pipeline, Plains All American Pipeline Company, did


















not shut off the pipeline right away. It was flowing for a couple hours. Some oil traveled 150 miles down the California coast.
You’ve been involved in lots of different cases over the years. Is there a standout? Probably the most impactful case was one where we came up with an idea for the state to be able to challenge 40 federal oil leases. Out of the 83 leases that had been granted by the federal government, about 40 were not developed yet, and so we initiated a legal theory that the state Coastal Commission and governor joined to terminate those 40 leases, so they could never be developed. Basically, we got rid of half of the potential oil and gas development off the coast of California. That’s pretty good. That case went up to the Ninth Circuit Court of Appeals, and we won. It’s a great example of the fact that so many of our victories are things people don’t see and don’t know about. We could have had twice as many platforms off of our coast.






How many platforms are there? There are over 20 platforms, and most in our area, a few down south. Eight of them are no longer producing. So, when that happens, they have to enter into what’s called the decommissioning phase. When these platforms were installed, the oil companies agreed that when they finished extracting the oil and gas, they would then remove everything and restore the ocean to its natural condition. That’s the basis on which “the people,” who own the ocean, lease the drilling rights.
Now they want to save money by leaving them or leaving them partly there. Under current law, they can apply to do that and show that it would be better for the marine environment than removing them completely. The federal government just completed an environmental evaluation looking at different decommissioning options, from fully removing the platforms to partially removing them, and determined that the best for the marine environment was full removal.
So, eight are permanently shut down, and six of those are entering the decommissioning phase to start early this year.
Who owns those eight? [Platform] Holly was owned most recently by Venoco, who declared bankruptcy in 2017, so now the State of California is responsible. Fortunately, the prior owner, ExxonMobil, still has obligations for decommissioning, is working with the state, and paying for most of the cost of decommissioning the platform. This will be the first test of decommissioning off California in probably 30 years.
It’s really important people follow what’s going to happen, because it could set a precedent.
The other platforms off the Gaviota Coast up north at Point Conception are the ones that Chevron installed, and they are completely shut down. They will start going through the decommissioning process, probably later this year.
With some assets where they can’t make enough money, big companies like ExxonMobil sell their lease rights to smaller companies like Sable Offshore Oil.
I was surprised the Santa Barbara County Planning Commission apparently gave ExxonMobil permission to transfer their lease to Sable so easily. We were shocked at the lack of in-depth review. The county has an ordinance that requires its approval to transfer a lease. We argued the county should not transfer the permits, because Sable hasn’t shown it has the financial resources to safely operate these facilities or respond to an oil spill. It doesn’t even have approved oil spill contingency plans. It keeps submitting deficient ones. It hasn’t shown that it can safely operate. It has notices of violations from not just the California Coastal Commission, but now also the Regional Water Quality Control Board. They violated the Clean Water Act as well.
Sable hasn’t shown that they have adequate insurance or bonds, but the county staff didn’t require them to show these things with any detail. They said it’s kind of a paper transfer. But Sable is in debt. They borrowed almost $800 million from Exxon to buy this project. They have no other assets. They have no other revenue if they don’t start operating. We don’t know if they have enough money to operate safely when things go right, but if there’s an oil spill, they don’t have the money to deal with that.
And unlike the decommissioning responsibility that stays with the seller, ExxonMobil will have no responsibility because they didn’t install these assets. If there’s an oil spill on Sable’s watch due to their negligence, they’re not going to have the money to clean it up.
It strikes me that taking on Exxon and the other oil companies is a big task, and you seem to have done it over and over again. Well, that’s why the Environmental Defense Council was formed after the 1969 oil spill. It was really to be the voice of the community and to empower the community to stand up to the giants like the oil industry that caused the ’69 spill. We have lots of great tools at our disposal.

I know you have a strong coalition of environmental groups working on this with you. We have a great group. As a law firm, our clients include Get Oil Out, the Santa Barbara County Action Network, [and] the Sierra Club, and [we] work closely with the Santa Barbara Channelkeeper, Center for Biological Diversity, Surfrider Foundation, and others. We’re a very close-knit coalition and have already been successful to some extent because Sable, in trying to attract investors, said that it was going to restart all of these facilities in September 2024, and then October 2024, and then December. Now they’re saying early 2025, but they still are shut down because of the Coastal Commission, and still don’t have approvals from many other agencies.
So you think that this struggle is not over. One of the silver linings of the ’69 oil spill, though, was the environmental protection laws that we use today that were passed at the state and federal level. Those are the laws we use to defeat oil projects, gas power plants, and other LNG [Liquified Natural Gas] projects. And I’m just really proud of EDC for standing up. n
The California Natural Resources Agency (CNRA) has prepared a summary of the various state agencies that have oversight on Sable’s restart project. It, as well as copies of the Notices of Deficiencies and a longer version of the Linda Krop interview, can be read at Independent.com.




My name is Mary Mormann, and I’m reaching out to you with an urgent and heartfelt request. As a California native, I’ve had the privilege of living in many beautiful parts of this state—Menlo Park, San Francisco, Lake Tahoe, Santa Ynez, Santa Barbara, and now Ventura. I’ve always embraced an active, outdoor lifestyle and have spent over a decade teaching yoga and running a massage therapy practice in Santa Barbara. Most importantly, I’m a mother and a proud grandmother of two little boys, and I have so much life yet to live.
However, on March 1st, 2022, my life changed dramatically when I was hospitalized for EndStage KidneyFailure. After experiencing extreme fatigue and loss of appetite, I was immediately put on dialysis, which has been keeping me alive ever since. Dialysis has saved my life, but it’s also come with its challenges. I go three times a week for three-hour sessions, and I’ve endured severe complications, including seizures—one of which was so serious that I was placed in a medically induced coma for three days. It was a terrifying experience, and it made me acutely aware of how precious life truly is.
Now, almost three years into battling Chronic Kidney Disease (CKD), I am still in need of a kidney transplant. Despite undergoing countless tests, imaging, blood work, and numerous hospital visits, I have not yet found a suitable donor. I’m currently working with the UCLA Living Organ Transplant Team, but I am reaching out to the broader community in the hopes of finding a kind soul who might be willing to donate a kidney.
If you, or someone you know, is open to donating a kidney, it would give me the chance to live my life fully again. I am asking for your help as we enter 2025. A kidney donation would not only save my life, but it would also allow me to continue to enjoy time with my family, my community, and all that I hold dear.
Thank you so much for your compassion, consideration, and support during this difficult time. Please don’t hesitate to reach out to me directly if you are interested or have any questions.
With deep gratitude, Mary Mormann
Phone: 805-450-9933
Email: marye@coastalranch.com

In-person and virtual appointments available.
High quality medical care for patients in Santa Barbara County.


For more information or to schedule your appointment online, visit cottagehealth.org/primarycare



Santa Barbara | Goleta | Santa Ynez Valley








Accepting New Patients at Three Convenient Locations

Cottage Primary Care – Goleta 805-681-6424
Cottage Primary Care – Santa Barbara 805-563-7010
Cottage Primary Care Santa Ynez Valley 805-686-3200








New House Santa Barbara provides a clean, sober and healthy environment that allows men with alcohol and other drug problems to begin their journey of recovery and reclaim their self-esteem and sense of purpose. We operate three houses in Santa Barbara and pride ourselves on our supportive atmosphere with the common goal of recovery, based on twelve-step programs. Scholarships are available.


THURSDAY 1/23
1/23: Chaucer’s Book Talk and Signing: Cameron Walker DJ Palladino will talk with area author Cameron Walker about her book How to Capture Carbon, a selection of short stories that navigate the seas of a changing climate and the transformative power of loss and of love. 6pm. Chaucer’s Books, 3321 State St. Free. Call (805) 682-6787. chaucersbooks.com/events
FARMERS MARKET SCHEDULE


1/23: Boogie for Our Bodies Put on your Western wear for a silent disco with DJ Darla Bea and dancing. This Planned Parenthood fundraiser will support the fight for reproductive freedom for all and feature a raffle, costume contest, and more. 6:30pm. Wildcat Lounge, 15 W. Ortega St. $25. Ages 21+. Call (805) 722-4690 or email riley.dewitt@ppcentralcoast.org tinyurl.com/BoogieForOurBodies25
FRIDAY 1/24
1/24, 1/26:
¡Viva el Arte de Santa Bárbara! La Santa Cecilia This band and voice of a new bicultural generation in the U.S.A. will play their blend of cumbia, bossa nova, rumba, bolero, tango, jazz, and more in a hybrid of Latin culture, rock, and world music. Fri.: 7pm, Isla Vista Elementary, 6875 El Colegio Rd., Goleta; Sun: 6pm, The Marjorie Luke Theatre, 721 E. Cota St. Free. Call (805) 893-3535 or email info@artsandlectures.ucsb.edu tinyurl.com/La-Santa-Cecilia

1/24: Queen Nation Symphonic Rock Show This tribute band dedicated to celebrating the electrifying spirit and legacy of Rock ‘n’ Roll Hall of Fame music group Queen will perform note-for-note renditions of classic songs such as, “Bohemian Rhapsody,”“We Will Rock You,”“Somebody to Love,” and more. 8pm. Chumash Casino Resort, 3400 E. Highway 246, Santa Ynez. $20-$40. Ages 21+. Call (805) 686-0855. tinyurl.com/QueenNationJan24
1/24: Martin Media Presents: Paula Poundstone Paula Poundstone, the iconic comedian who regularly plays theaters across the country; hosts a weekly comedy podcast, Nobody Listens to Paula Poundstone; and is a regular panelist on NPR’s Wait, Wait Don’t Tell Me, will bring her smart, observational humor to S.B. 7:30pm. Lobero Theatre, 33 E. Canon Perdido St. $64.25. Call (805) 963-0761. lobero.org
1/24-1/25: Film Screening: The Shining Watch a screening of Stanley Kubrick’s 1980 mystery horror film, The Shining (R), which tells the story of a family who heads to an isolated hotel for the winter, where a sinister presence influences the father into violence, and, at the same time, his psychic son sees horrifying visions. 9pm. SBIFF Film Center, 916 State St. $7-$12. Email help@sbiff.org tinyurl.com/SBIFFTheShining
1/25: LVAA Artist Reception: California Wilds: Prints by Angelina LaPointe The Lompoc Valley Art Association (LVAA) presents California Wilds, a collection of prints that illustrate the state’s diverse and beautiful animal life displayed against the backdrop of its distinctive landscapes, by printmaker Angelina LaPointe. Meet the artist and enjoy light refreshments. 1-3pm. Cypress Gallery, 119 E. Cypress Ave., Lompoc. Free. Call (805) 737-1129. lompocart.org/events
THURSDAY
Carpinteria: 800 block of Linden Ave., 3-6:30pm
FRIDAY
Montecito: 1100 and 1200 blocks of Coast Village Rd., 8-11:15am
SATURDAY
Downtown S.B.: Corner of State and Carillo sts., 8am-1pm
SUNDAY
Goleta: Camino Real Marketplace, 10am-2pm
TUESDAY
Old Town S.B.: 500-600 blocks of State St., 3-7pm
WEDNESDAY
Solvang:
Copenhagen Dr. and 1st St., 2:30-6:30pm
(805) 962-5354 sbfarmersmarket.org
FISHERMAN’S MARKET
SATURDAY
Rain or shine, meet local fishermen on the Harbor’s commercial pier, and buy fresh fish (filleted or whole), live crab, abalone, sea urchins, and more. 117 Harbor Wy., 6-11am. Call (805) 259-7476. cfsb.info/sat

1/25: UCSB Arts & Lectures Presents: Fran Lebowitz Sharp-tongued, quick-witted, and with a disarmingly world-weary persona, Fran Lebowitz enjoys a reputation as one of today’s great raconteurs and will deliver an endless supply of hilarious one-liners and dry social commentary to skewer the vanities of contemporary life. 7:30pm. Campbell Hall, UCSB. UCSB Students: $15, GA: $37.50-$67.50. Call (805) 8933535. artsandlectures.ucsb.edu


1/25: Maverick Saloon Flannel 101,
event-calendar
1/23-1/29: SOhO Restaurant & Music Club Thu.: Buddha Trixie, Sports Coach, Big Hungry, 8pm. $15-$20. Ages 21+. Fri.: Fishbone, Bite Me Bambi, 9pm. $35-$40. Ages 21+. Sat.: Cool Water Canyon, 9pm. $15-$18. Ages 21+. Sun.: Sandy Cummings & Jazz du Jour, 12:30pm. $10. Dr. Wu: The Music of Steely Dan, 7:30pm. $28$32. Mon.: Songwriters in the Round with Jena Douglas, Mary J. Madden, Michael Wild, and more, 7pm. $10. Tue.: UCSB Jazz Combos Concert, 7pm. Students: $5 (cash at the door); GA: $15-$18. 1221 State St. Call (805) 962-7776. sohosb.com
1/24: Eos Lounge Fields of Funk Presents Boombox, 8pm. $12.36. 500 Anacapa St. Ages 21+. Call (805) 564-2410. eoslounge.com
1/25-1/26: Cold Spring Tavern Sat.: Oddly Straight, 1:30-4:30pm. Sun.: Grass Mountain, 1:30-4:30pm. 5995 Stagecoach Rd. Free. Call (805) 967-0066. coldspringtavern.com
1/25: Hook’d Bar and Grill The Will Stephens Band, 2pm. 116 Lakeview Dr.,
Cachuma Lake. Free. Call (805) 350-8351. hookdbarandgrill.com/music-onthe-water
1/25: Lost Chord Guitars Rick Berthod, 7pm. $10. 1576 Copenhagen Dr., Solvang. Ages 21+. Call (805) 331-4363. lostchordguitars.com
1/25: M. Special Brewing Co. (Goleta) Larry Williams & the Groove, 7pm. 6860 Cortona Dr., Ste. C, Goleta. Free. Call (805) 968-6500. mspecialbrewco.com
1/25: M. Special Brewing Co. (S.B.) Pocket Fox, 8pm. 634 State St. Free. Call (805) 968-6500. mspecialbrewco.com
1/25: Wylde Works The Rhythm Industrial Complex, 8pm. 609 State St. Free wyldeworks.com/pages/events
1/27: The Red Piano Celso Salim, 7:30pm. 519 State St. Free. Call (805) 3581439. theredpiano.com
1/26: Emporium Presents MANIA: The ABBA Tribute An extraordinary cast of talented musicians and singers will perform all of ABBA’s greatest hits, such as, “Dancing Queen,”“Waterloo,”“Mamma Mia,” and more with stunning costumes, choreography, and musicianship. 6pm. Lobero Theatre, 33 E. Canon Perdido St. $44.50-$74.50. Call (805) 963-0761. lobero.org
1/26: Chaucer’s Book Talk: Mary Tonetti Dorra Area author Mary Tonetti Dorra will talk about and sign copies of her latest collection of short stories, I Am a Portrait: Flash Fiction and Other Short Stories, which tells the story of how a painting moves from Cuba to Paris to California to Pittsburgh, illuminating the last century of international cultural diaspora, tied together by art and cuisine. 3pm. Chaucer’s Books, 3321 State St. Free. Call (805) 682-6787. chaucersbooks.com/events









































1/26: The 17th Annual S.B. Community Seed Swap Come share seeds and knowledge with other backyard gardeners, plant lovers, beekeepers, farmers, and more. Enjoy speakers, exhibitors, kids’ activities, live music, and free seeds. 11am-4pm. S.B. Community Arts Workshop, 631 Garden St. Free Call (805) 962-2471. sbpermaculture.org
MONDAY
1/27: In-Person or Virtual Monday Evening Guided Lamrim Join in person or online for a breathing meditation, traditional preparatory prayers recited before the Lamrim teaching of the day, and a second guided meditation on that topic. All levels are welcome. 6:30pm. Mahakankala Kadampa Buddhist Center, 1825 State St., Ste. 202. $15. Call (805) 563-6000. meditationinsantabarbara.org
1/28: Montecito Book Club This month’s selection is TJ Klune’s The House in the Cerulean Sea, which, according to Goodreads, is “an enchanting story, masterfully told about the profound experience of discovering an unlikely family in an unexpected place — and realizing that family is yours.” 2-3pm. Montecito Library, 1469 E. Valley Rd. Free. Call (805) 969-5063. tinyurl.com/Montecito-Book
WEDNESDAY 1/29

1/29: Artist Advocacy Foundation Presents Once There Was a Town: The Port Chicago Story This live, multimedia, spoken-word event will feature actors, images, and film clips of residents of the town of Port Chicago, 20 miles northeast of San Francisco Bay, the site of a devastating explosion at its Naval Munitions Depot during WWII and the subsequent mutiny trial of striking Black sailors protesting the unsafe working conditions prior to the explosion, which killed 320 persons, more than 200 of them Black sailors. 7pm. $35. Maverick Saloon, 3687 Sagunto St., Santa Ynez. Call (805) 448-4208 or email ron.colone@gmail.com. artistadvocacyfoundation.org
1/29: UCSB Arts & Lectures Presents: An Evening with Tommy Orange Author and citizen of the Cheyenne and Arapaho Tribes of Oklahoma Tommy Orange will talk about There There, a Pulitzer Prize finalist that tells a thrilling multi-generational story about urban Native Americans. 7:30pm. Campbell Hall, UCSB. UCSB Students: free; GA: $20. Call (805) 893-3535. artsandlectures.ucsb.edu










An Evening with Tommy Orange
Wed, Jan 29 / 7:30 PM / UCSB Campbell Hall
FREE copies of Orange’s new book, Wandering Stars , will be available while supplies last (pick up at event, one per household)
Justice for All Lead Sponsors: Marcy Carsey, Connie Frank & Evan Thompson, Eva & Yoel Haller, Dick Wolf, and Zegar Family Foundation







Just added!
Award-winning Palestinian-American Poet An Evening with Naomi Shihab Nye
Tue, Feb 4 / 7:30 PM / UCSB Campbell Hall
Justice for All Lead Sponsors: Marcy Carsey, Connie Frank & Evan Thompson, Eva & Yoel Haller, Dick Wolf, and Zegar Family Foundation





Award-winning Historian Sir Niall Ferguson
Why We Study History: Standing at the Crossroads of Past, Present and Future
Sat, Feb 8 / 4 PM (note special time) / Granada Theatre
Major Sponsors: Susan McCaw and Laura & Kevin O’Connor







Pulitzer Prize-winning Environmental Novelist Richard Powers in Conversation with Pico Iyer
Sun, Feb 23 / 7:30 PM / UCSB Campbell Hall
Speaking with Pico Series Sponsors: Martha Gabbert, Robin & Roger Himovitz, Siri & Bob Marshall, and Laura & Kevin O’Connor
Of the many annual offerings making Santa Barbara’s cultural calendar as rich and inclusive as it is, one of the most unique goes by the telling and innately affirmative moniker ¡Viva el Arte de Santa Bárbara! The exclamation points have long since earned their place here.
Launched in 2006 as an offshoot of the UCSB Arts & Lectures seasons, in conjunction with various cultural organizations and always free to the public the series pays respects to the vitality and vibrancy of Hispanic culture in our neighboring region, from regional Mexican music idioms outward in the Latin American diaspora. Dance also figures into the programming at times. The residency-based series blends concerts at the Isla Vista school on Friday night, in Guadalupe on Saturday, and a grand finale at the Marjorie Luke Theatre on Sunday with workshops and educational settings around the area. It’s a fullservice encounter with the visiting artists, versus one-night-stand operations.
Mariachi often figures into the equation of programming, but so does son jarocho, banda, such distinctive artists as Gaby Moreno and Perla Batalla, and hybrid variations, as represented by such respected genre-crossing groups as the famed East L.A. ensemble Las Cafeteras (which made a welcome return to the series last fall) and L.A.’s La Santa Cecilia, settling in for a residency as the new year’s first installment of the series, January 24-26.

Celebrating the breadth of influences from Latin music to rock and vestiges of other world music traditions, the Grammywinning band happily marries and mixes contemporary and traditional styles. Genre-wise, cumbia, bossa nova, mariachi, bolero and norteño can be heard in their musical ingredient list, along with rock flavors and pinches of jazz.

As the lead singer known as Marisol “La Marisoul” Hernández said in an interview during an earlier visit to Santa Barbara, the group’s sound is “very diverse, which is like our experience. Personally, I always wanted to be in a rock band, but I was taught by street musicians and I was taught all the traditional music. At times, it felt like I had two lives. During the week, I went to school with my friends and we listened to rock ’n’ roll and classic rock. Then on the weekends, I would sing for tips on Olivera Street, singing all the beautiful traditional music.”

She continued, “In this band, we’re able to combine those two lives, to combine this feeling of being from here and from there. We combine that love for the music we heard from our parents and that we love to jam out or rock out with our friends.”
Coming up later this season, ¡Viva el Arte de Santa Bárbara! turns its focus to the all-female salsa group Las Guaracheras, from Cali, Colombia (Mar. 14-16) and then back to Mexico and dance with Ballet Nepantla (May 16-18). In this group, contemporary ballet does a happy dance with traditional Mexican folk dance. In short, the magic is in the cultural and historical blending, a key to the ongoing success of the series, by now an institution always worthy of attention. And did we mention the tasty, gratis Mexican pastries at the Luke Theatre, post-concert?
—Josef Woodard
¡Viva el Arte de Santa Bárbara! is well worth checking out. For more information on the La Santa Cecilia performances, visit bit.ly/42dUUqN.









For more than 30 years, John Blondell has been creating wondrous theatrical artistry in the Santa Barbara community and beyond, conceptualizing and directing shows for Lit Moon Theatre and heading the theater arts department at Westmont College (among other endeavors around the world). This year marks the end of an era: Blondell is retiring and heading overseas to devote his time to international projects. To commemorate this last turn as a Santa Barbara director, Lit Moon is presenting a theater festival of four plays January 22-25 at the Community Arts Workshop. The works are, as Blondell says, “All part of the past and present Lit Moon web. These pieces are tied together methodologically and stylistically.”
The plays include Uncle Vanya and King Lear, both Lit Moon shows directed by Blondell. Uncle Vanya (for which the tagline reads: “the heart aches and dreams fade, but there’s vodka”), one of Chekhov’s many plays about quiet dissatisfaction, runs the evening of January 25. King Lear was created by the company in a Macedonian artists’ villa. “It’s an intimate show,” says Blondell, “with a lot of puppet and toy and paper elements.” Lear will play January 22-24.
Prospero’s Black Box , performed by onetime Lit Moon player Jeff Mills, runs the afternoon of January 25. The piece was inspired by Geoffrey Hinton’s relationship to AI (the “new magic”) and Prospero from The Tempest. The show, says Blondell, is physical, poetic, and provocative, with AI and VR at the forefront of thought. Finally, A Real Elephant, a toy, paper, and object-based theater piece created and performed by Yulya Dukhovny (who also made the paper-based props for King Lear ), runs on January 24.
“It’s a celebration, homecoming, goodbye, Saturn return,” says Blondell. “We wanted to bring it to an end in a really meaningful way it’s been a great run.”
—Maggie Yates
The Lit Moon Theatre Festival runs January 22-25 at the Community Arts Workshop (631 Garden St.). Register for tickets at litmoontheatre.com.






























































TENNESSEE NATIVE TURNED SOUTHERN CALIFORNIA TRANSPLANT WILL PERFORM JANUARY 25

“I’m not an activist. I’m just a comedian,” clarifies Trae Crowder, his raspy, deep southern accent emphasizing his position.
Crowder performs under the stage name “Liberal Redneck,” which is very fitting considering that he is a microscopic blue dot in deep-red Tennessee.
“Everybody hears my accent and assumes I’m like a Bible-thumping ultra-conservative. But I’m not, and that’s because they only ever hear this accent saying that stuff. So, I started saying the opposite stuff in this accent to try to even the scales out.”
Crowder credits his father for his “black sheep” views in a Republican stronghold state.
“I was raised by a single father who was really into movies, music, art, and stuff. He was a godless, rock ’n’ roll, dope-smoking, jean-jacket-wearing type of guy. I’m just sort of the way that I was raised to be even though I grew up in a place where that’s not the norm,” Crowder shares.
His juxtaposing political views and his status as a self-proclaimed Southern California transplant are just some of the things that he derives his comedic material from.
“I was also kind of a fat dork as a kid, which meant I was funny,” he quipped.
Growing up in his father’s video store, Crowder’s Video, provoked Crowder’s childhood infatuation with movies. He grew up with dreams of writing and directing films, but as the movie industry became oversaturated, he turned his attention to comedy and television.
Crowder cites a pivotal moment in his life, when he watched Bigger & Blacker by Chris Rock on HBO with his father. But it wasn’t until age 24 that Crowder moved to Knoxville, Tennessee, and started performing open mic at a comedy club called Side Splitters.

Crowder gained traction and received feedback that his jokes were a hit. In 2016, Crowder quit his day job working for the U.S. Department of Energy after going viral for his Liberal Redneck “porch rant” videos.
Since then, he has written a best-selling book, The Liberal Redneck Manifesto: Draggin’ Dixie Outta the Dark; appeared on multiple TV shows and podcasts; toured the country three times; developed and sold five scripted pilots; and sold out countless shows. Crowder currently co-hosts the hit podcasts WellRED, Weekly Skews, and Puttin’ On Airs
Throughout his several cross-country tours, Crowder has yet to perform his comedy for a Santa Barbara audience. “I don’t really know what to expect. Maybe fancy people. People that like red wine and have little dogs. I’m really looking forward to it, though,” Crowder jokes.
Crowder now lives in Los Angeles with his wife and two sons. He says he’s grateful for the opportunities that career has afforded him, including meeting legends such as Mel Brooks and Morgan Freeman. Despite all of the success during his career, Crowder’s favorite part of his job has remained simple. “My priority is to make people laugh and hope that they have a good time. I’m not trying to change the world.”
Those who plan on attending his Santa Barbara show can expect his material to range from heavier topics such as the state of American schools and recent political happenings to lighter topics such as being a dad, having a Southern accent, and a recent trip to the U.K. —Madeline Slogoff
Come witness the Southern charm and progressive twang from Trae Crowder himself at the Lobero Theatre (33 E. Canon Perdido St.) on Saturday, January 25, 7:30 p.m. Tickets can be purchased at lobero.org.





Thu, Jan 30 | 4–6 PM | McCune Conference Room, 6020 HSSB
Drawing from his work on aesthetic environments, Professor Claudio Benzecry (Northwestern University) will give a talk about how and when humans and things become objects or subjects. He will focus on the figures of the opera fan, the shoe fit model, and the museum custodian.
Learn more: bit.ly/Benzecry-IHC ihc.ucsb.edu


Wed, Feb 12 / 7:30 PM / UCSB Campbell Hall
$25 / FREE for all students (with valid ID)
The co-founder of Tompkins Conservation and former CEO of Patagonia, Kristine McDivitt Tompkins has dedicated her life to preserving wild beauty and biodiversity by creating national parks, restoring wildlife and inspiring activism.
Event Sponsor: Patricia Bragg Foundation




/
(registration recommended)
Follow conservationist Kristine McDivitt Tompkins as she and entrepreneur Doug Tompkins leave







Robin Greenfield owns almost nothing all of his possessions have been reduced to fit in a three-wheeled stroller. A handmade sign on the front reads, “WALKING CANADA TO L.A. EACH STEP A GREETING TO MOTHER EARTH.”
Environmental Activist Robin Greenfield’s Trek to Los Angeles Is Lead-Up to ThreeMonth Experiment in ‘Non-Ownership’
by Callie Fausey
On January 10, Greenfield made it to Santa Barbara. The environmental activist had completed 1,500 miles of his journey from Canada, including 900 miles in handmade moccasins and 600 miles completely barefoot.
His trek to Los Angeles is the lead-up to a three-month experiment in “non-ownership,” where he plans to shed everything he owns, including, yes, even his clothes.
Greenfield, a sustainability YouTuber with more than 400,000 subscribers, is no stranger to social experiments in the past, he’s worn his trash for 30 days straight. But this will be a new kind of challenge for him.
Sitting cross-legged in Plaza de Vera Cruz the Cota Street park known for its trapeze acts Greenfield was surrounded by a circle of local fans, fellow walkers joining him for the final stretch, and a modest film crew.
“I’m thinking about how, days from now, I will be naked in a park, owning absolutely nothing,” he said with a smile, picking at the grass beneath his legs.
The Wisconsin-born environmentalist set out on his adventure from the U.S/Canadian border in July 2024, primarily following the Pacific Coast Highway. His long journey

is evident in his calloused, dirt-covered feet and his clothing, held together by safety pins.
Once he reaches Los Angeles, Greenfield plans to give up the last remnants of his belongings.
The walk, he said, is to help him slow down, simplify, and break free from the common “trappings” of everyday life. He’s walked six to seven hours each day (minus rest days), which he’s spent living in the moment and “making the sky his best friend.”
“I can tell you my relationship with the birds is very different than it was when I left Canada,” he chuckled.
To prepare, Greenfield simplified his physical possessions down to things he can walk with. And he’s been giving away some of those possessions as he’s passed through different communities, along with revealing all of his secrets in a YouTube series, to “empty his mind” and open himself up to “complete transparency.”

“With each day on the road, I’m shedding more of the past and walking into the present,” he said.
Soon, the man who still owns some stuff (for now) will be the man who owns nothing. He told his Santa Barbara groupies that he is questioning the things unquestioned money and ownership, he noted, are made-up social concepts.
“At the heart of this is sustainability,” he added, vowing to consume less in the face of overconsumption.
By shedding his worldly possessions, he wants to “unravel” this “web of consumerism” he found himself in. He chose Los Angeles because it’s a well-populated epicenter of culture, and an ideal place to share his message and stay warm using only basic items.
“It’s also to see if I can maintain a deep connection to Earth even though I’m in a major city,” he explained. “My objective is to experiment with existing with the absolute basics, not even carrying a cup or a bowl or a book or a notebook or a light.”
However, he will borrow a few items for no longer than 10 days at a time prioritizing clothes, a blanket or sleeping bag, and maybe a sleeping mat or tent. When he initially ditches his clothes to start the experiment, Greenfield is hoping someone will donate a sheet or some other article of clothing to cover himself up. If none are offered, he plans to use a natural solution like a nearby palm frond.
He will live without accepting or handling any money, but people have offered to pay others or volunteered themselves to record content for his YouTube and social media channels. He plans to use the Earth to provide himself with his basic needs, and make relationships with the life and community around him to share resources.
During his time owning nothing, he will “live in service to the community,” including volunteer work; “practice simple living”; and share his messages with others.
He did acknowledge that for some, non-ownership is
not optional. He is not saying that anyone should practice non-ownership. “I’m incredibly sensitive to people who are experiencing homelessness, and, of course, the people who have lost everything recently to the fire,” he said, referring to the fires burning through Los Angeles.
We live in a society “where the haves have so much more than the have-nots,” he said, and extreme excess and consumerism have taken a toll not only on humanity but also plants and animals.
“And so my entire intention is to speak to those who have means to say, ‘Look, there’s so many people that don’t have their basic needs met; we can come together; we can share our resources,’ ” he continued. “We’re trying to fill the voids inside of ourselves through stuff, all of this stuff causing a substantial amount of destruction. So that is at the heart of my message.”
However, the fires in Los Angeles have put an unexpected wrench in his plans.
“I’m not sure what to do yet,” he later told the Independent via email.
Greenfield said that he is currently in Ventura, “keeping my ears open to the situation and to the community.” He will resume his walk on Saturday, January 18, at the earliest, arriving in L.A. on January 21 at the soonest.
“A big part of the premise of this experiment was, ‘Can I own nothing and have no money, but give more to society than I receive?’ ” he said. “And I still believe that, no doubt, I could arrive in Los Angeles and do just that by being of service to people in need.”
“You’ve caught me in the middle of something I was so certain about, and now really being at a bit of a loss of how to move forward at this moment, but I’ll know in time.”
Learn more about Greenfield, his walk, and his experiment at robingreenfield.org.
Santa Barbara is certainly not New York City, home of the quick-cooking and iconic Bacon, Egg, and Cheese (BEC) sandwich. But what we lack in bodegas, we make up for in a variety of breakfast sandos that will please any palate. From fluffy French croissant concoctions to kaiser-roll deli classics, Southern-inspired sausage biscuit behemoths, and myriad bagel combinations, there are a number of satisfying breakfast sandwich options coming out hot and fresh from our California kitchens. Here are a few of the top ways to start your day on the right side of the bed.
BY REBECCA

It’s easy to be enticed by Alessia Patisserie’s dreamy pastry case, bursting with creative confections like a gourmet Snickers bar, dusted with gold and topped with mousse. However, Mom’s advice to eat something savory before dessert is a not only wise but also delicious choice at this light and bright French outpost on Canon Perdido Street. What better place to start than breakfast? Executive Chef Alessia Guehr offers two outstanding breakfast sandwiches, including a classic on their bouncy brioche bread loaded with shaved Black Forest ham or bacon, sauteed mushrooms, tomato, Gruyère, onion jam, garlic aioli, and a fried egg. My favorite is the croissant sandwich, which shows off their perfectly executed pastry, a hypnotizing creation of countless layers of buttery goodness. Filled with fried or poached eggs, Gruyère cheese, heirloom
tomatoes, red onion, and hollandaise, this delicacy can be made even more luxurious by adding Black Forest ham or smoked salmon. Crown your meal with a decadent dessert for a truly regal start to your day.

Bacon, egg, and cheese. Simple but, when done right, revelatory. Like a rocking supergroup, Big T’s Deli in the Santa Barbara Public Market manages to take every part and do it just right in their best-seller, the Westside BEC. Eggs beam with healthy yellow yolks and are lightly fried for ideal jamminess, and they use “New School” American cheese, which elevates the snack-bar standby by using real ingredients, such as aged cheddar cheese, resulting in the same meltiness and better flavor. The kaiser rolls are brought in daily from S.B. fave D’Angelo Bakery, and when they’re toasted and lathered in their lightly spiced “bodega sauce,” this creation might just transport you to the streets of Brooklyn. “We take pride in using the freshest ingredients available, ensuring every bite bursts with flavor,” owner Travis Twinning said. “Known for our generous portions and affordable prices, we prioritize quality over quantity; we’d rather run out of a product than serve day-old bread or bagels, guaranteeing that our offerings meet the highest standards.” You can taste this meticulous care in all of their sandwiches and breakfast bagel creations. I was enamored by the Salmon Sammy, a fresh Yetz’s bagel containing a savory blanket of folded eggs, lox, grilled onions, arugula, tomato, and cream cheese. With a menu that will satisfy all of your cravings, Big T’s is the neighborhood deli we’ve been waiting for.
Big T’s Deli, Santa Barbara Public Market, 38 W. Victoria St.; sbpublicmarket. com/vendors/big-ts-deli
S.B. has often been called The American Riviera for its Mediterranean climate, winemaking culture, and, I’d argue, its incredible pastries. French transplants and founders of Bree’Osh Bakery, Pierre Yves-Henry and his wife, Nellie, are a

large part of this delectable and methodical approach to baking that offers us all a taste of la belle vie. Their popular Brioche Breakfast Sandwich features two soft scrambled organic eggs with Emmental cheese, special sauce, caramelized onions, and arugula. “We like to cook the right way, very gently and slowly,” Yves-Henry said. I added bacon to take it over the edge, but it certainly is not a requirement. The high quality of each ingredient sings a beautiful solo that needs no additional notes. The brioche itself takes 15 hours to make, and it’s a threeday process to create their croissants. You can taste and feel the intentional difference in the lamination in their Croissant Breakfast Sandwich, which includes uncured ham or cremini mushrooms, a sunny-side-up egg, and Swiss cheese. After all of this deliciousness, I expected to feel stuffed or sleepy, but in true French style, their food left me energized, sated, and ready to continue living the good life.

While the main draw to this rainbow of a shop might be their eye-catching and tastebud-dazzling donuts, do not sleep on their excellent array of breakfast sandwiches. The same meticulous care and ingredient sourcing that goes into their creative handmade donuts is evident in their super-satisfying breakfast creations. “Coming from a background as a private chef, I’ve always been focused on creating exceptional and memorable experiences for my clients, so I wanted to bring that same level of intention to our breakfast menu,” co-owner
Denisse Salinas said. The GOAT features a fried egg, luscious goat-cheese mousse, a bourbon bacon jam that simmers for hours on the stove, and fresh baby arugula nestled inside their heavenly handmade buttermilk biscuit. Each ingredient works together seamlessly. In their Sausage, Egg and Cheese, their house-made maple-sage sausage patty pairs perfectly with an herby avocado mayo and Jack cheese. Inventive creations like the Cubano, which layers scrambled eggs, applewood-smoked ham, Swiss cheese, and stone-ground mustard on a toasted English muffin, with a side of homemade dill pickle/serrano hot sauce, surprise and delight. “Every sandwich is carefully crafted to balance quality, flavor, and texture just like our donuts each with its own unique (and hopefully unforgettable) personal touch,” Salinas said. With vegan options and great coffee as well, there’s something for everyone at this sweet and savory paradise.
Hook & Press; 15 E. Figueroa St.; hookandpressdonuts.com




With all this discussion of bread, I must shine a spotlight on Lilac Pâtisserie’s incredible Breakfast Sandwich, which is made with an ethereal I-can’t-believe-it’s-gluten-free brioche. This thoughtfully crafted creation, available at their Parisian-inspired locations, proves that not all egg and bacon enclosures need be laden with wheat to be delicious. With one bite of this beauty, which combines jammy organic eggs, thick Black Forest ham, bright homemade pesto, baby arugula, and sharp cheddar cheese between perfectly griddled brioche bread, you’ll be planning your next trip back. “The addition of our house-made pesto and the sweetness of the brioche bread balanced by the savory ham is what knocks it out of the park for me,” owner Gillian Muralles said. For a French-infused, open-faced breakfast sandwich, the Croque Madame is a must. This decadent specialty of Black Forest ham, Gruyère cheese, and two fried eggs layered on rustic white toast and draped in a velvety Mornay sauce satisfies on every level and is perfectly balanced by the fresh side salad drizzled with their light and lemony house vinaigrette. With quality ingredients thoughtfully prepared, Lilac provides impeccable dishes that will ease the minds of those who are gluten-free and please the palates of all.
Lilac Pâtisserie, 1017 State St.; lilacpatisserie.com. Lilac Montecito, 1209 Coast Village Rd.; lilacmontecito.com

Looking to scratch your bodegabrekky itch? Search no further than Revolver, the Westside’s groovy little vinyl-infused, chef-driven, sourdough pizza haven. “Everything for Revolver, if we can make it in-house, we do,” said owner Nick Bodden, who hails from Long Island. Bodden’s experience cooking in Michelin-starred kitchens, pizza parlors, and bagel shops in New York City and beyond shines in his attention to detail. After returning from a trip to the city, he was inspired to bring the breakfast sandwich culture to S.B., and their Sunday morning pop-up was born. I can’t think of a lovelier way to start a Sunday than pulling up a red barstool at their hole-in-the-wall outpost, grabbing a latte from Considered Coffee out front, and chatting with neighbors or the personable Bodden while awaiting this delicacy. Simplicity reigns here with only two options to choose from: the vegetarian, filled with two fried eggs, avocado, cheddar cheese, and the perfect hit of house-made chili crisp; or the meat version, which rotates weekly. I lucked out on a day that Bodden offered imported Italian mortadella. Ham’s cosmopolitan cousin is the perfect sumptuous costar to savory fried eggs and cheese. Both options are true to Revolver’s from-scratch ethos and nestled inside a house-baked kaiser roll. I didn’t understand the allure of a kaiser roll before trying their cloudlike, tender, poppyseed-topped concoction; now I wish I could buy theirs in bulk. Revolver is a testament to the power in making just a few things very, very well.






































































































































Last July, I wrote that Santa Barbara staple Judge for Yourself Café, at 1218 Santa Barbara Street, had a for-sale sign in the window even though the restaurant was still open. I called the business at the time and was told that the restaurant has been for sale but there have been no buyers. I have now received an update from management that the restaurant has closed permanently. “Thank you for all your patronage over three decades,” say the owners. “Due to unforeseen circumstances, we will no longer be open. We will miss serving this community. A big thank you for all the love and support. —The Judge Crew”
MASALA SPICE OPENS ON THE MESA: Reader Tony W. tells me that Masala Spice has opened at 1919 Cliff Drive, the former home of Mesa Verde restaurant, which closed last July after 10 years in business. This will be a second location for Masala Spice, which opened in January 2019 at 5796 Calle Real in Goleta. Instead of the just Indian dishes like on the Calle Real menu, this location includes a pasta menu, a pizza menu, and a taco menu.
BREAKWATER RESTAURANT CLOSES FOR RENOVATIONS:
The Breakwater Restaurant at 107 Harbor Way, which came under new ownership last year, closed this week for a few months to implement planned changes. “Looks like we will be closing the Breakwater for our renovations,” says new owner Dudley Michael. “We hope to be reopened with a new look, and more importantly, new bathrooms in the spring.”
THE ELLWOOD UPDATE: While attending a pre-opening event recently at The Ellwood, coming soon to the former home of the Beachside Bar-Café at Goleta Beach, I was told that the opening day was to be January 22. Reader Chompee McGillicutty now says that the opening has been moved to the end of this month.
LOMPOC RESTAURANT WEEK COMING IN FEBRUARY:
The Lompoc Valley Chamber of Commerce has announced a special week-long event: a seven-day celebration of dining and beverage artistry in conjunction with the restaurant owners of the Lompoc



Valley. Lompoc Restaurant Week is scheduled for Monday, February 17, through Sunday, February 23, 2025. Lompoc Restaurant Week will present a lineup of discounted dining options at participating restaurants and tasting rooms a prix-fixe meal, a two-for-one dining option, a special event or wine/ beer flight with pairings all for $20.25, plus tax and tip. Establishments and food trucks interested in participating in the week-long event can register online at lompoc.com. Business registration is open through February 7 and is free for Chamber members and $35 for nonmembers. For more information, call the Lompoc Valley Chamber at (805) 736-4567.
PACIFIC PICKLE WORKS DEBUTS TWO NEW PRODUCTS:
Pacific Pickle Works of Santa Barbara, which makes pickled vegetables, condiments, and drink mixers, will launch two new pickle products at the upcoming Fancy Food Show in Las Vegas. This event is hosted by the Specialty Food Association. “We’re constantly inspired by global culinary traditions and our customers’ evolving tastes,” said Bradley Bennett, Founder of Pacific Pickle Works. “These two new products reflect our commitment to innovation and quality, bringing unique flavors to the table while staying true to our core values of creating great-tasting products with clean and natural ingredients.”
“Kimchi Meets Pickle” is pickle chips that is a fusion of kimchi flavors and classic pickling with a vegan-friendly twist on a traditional Korean staple. Featuring extra-thick-cut cucumber slices alongside a mix of daikon radish, carrot, and onion, this pickle mix is seasoned with coarse gochugaru chili flakes, chopped garlic, and ginger. In place of traditional fish sauce, Pacific Pickle Works uses liquid aminos to create an umami flavor while keeping the product vegan. As with all Pacific Pickle Works products, Kimchi Meets Pickle will be vegan, kosher, NonGMO Project Verified, and shelf-stable.
“Pickled In Pink” is sliced red onion with jalapeño and habanero and features thinly sliced red onions pickled with a touch of spice from fresh jalapeño and habanero. These pickled onions help enhance tacos, sandwiches, salads, or any dish in need of an oniony kick.












(Mar. 21-Apr. 19): Author Anaïs Nin wrote, “Life shrinks or expands in proportion to one’s courage.” I bring this to your attention because you Aries folks now have a mandate to expand your life through courageous acts, thoughts, and feelings. I suggest we make the Arctic fox your power symbol. This intrepid creature undertakes epic migrations, journeying more than 2,000 miles across sea ice, using starlight and magnetic fields to navigate. Let’s dare to speculate that you have something in common with it; let’s propose that you are equipped with an inner guidance system that gives you a keen intuitive sense of how to maneuver in unfamiliar territory. PS: Anaïs Nin has another tip: “We don’t see things as they are, we see them as we are.”
(Apr. 20-May 20): Taurus archeologist Howard Carter made a spectacular discovery in 1922: the intact tomb of the Egyptian pharaoh Tutankhamun, more than 3,300 years after his death. It was filled with more than 5,000 artifacts, became a global sensation, and to this day remains the most famous find from ancient Egypt. A short time before he succeeded at his five-year quest, Howard Carter nearly gave up. But then his sponsor agreed to provide funds for a few more months, and he continued. In this spirit, Taurus, I urge you to keep pushing to fulfill your own dream. Renew your faith. Boost your devotion. Remember why you feel so strongly.
of the effects that your work and play have on the world. Are they aligned with your intentions? Are your ambitions moored in impeccable integrity?
(Sept. 23-Oct. 22): Why are diamonds considered so valuable? I’m skeptical. High-grade diamonds are not as rare as public perception would lead us to believe. Yes, they are extraordinarily hard and scratch-resistant, but is that a reason to regard them as a sublime treasure? I acknowledge they are pretty in a bland way. But other gems are more intriguingly beautiful. Maybe the most important reason they are so prized is that diamond sellers have done effective marketing campaigns to promote them as symbols of love and luxury. All this is a prelude to my main message: Now is an excellent time to think and feel deeply about what is truly beautiful to you and take steps to bring more of it into your life. For you Libras, beauty is an essential ingredient in your life’s purpose.
(Oct. 23-Nov. 21): The way that ancient Romans made concrete was more ingenious than modern methods. Their manufacturing materials included “lime clasts,” which gave the concrete self-healing qualities. When cracks arose, they fixed themselves. That’s why Roman aqueducts built 2,000 years ago can still convey water today. Metaphorically speaking, I hope you will work on building similar structures in the coming weeks. It’s time to create strong foundations that will last for a very long time.



















(May 21-June 20): The James Webb Space Telescope is the largest telescope in space. Recently, it discovered hundreds of galaxies that no humans had ever before beheld. They are very old, too far more ancient than our own Milky Way galaxy. I propose we make this marvelous perception-enhancing tool a symbol of power for you. According to my analysis of the astrological omens, you now have a robust potential to see things that have always been invisible, secret, or off-limits to you. Some of these wonders could motivate you to reinterpret your life story and reshape your future plans.
(Nov. 22-Dec. 21): Do you harbor a yearning to learn a new language, new skill, or new trick? The coming weeks will be a favorable phase to get serious about doing it. Have you fantasized about embarking on an adventure that would expand your understanding of how the world works? The time is right. Have you wished you could attract an inspirational prod to unleash more creativity and experiment freely? The astrological omens suggest that inspirational prod is imminent. Have you wondered whether you could enhance and fine-tune your receptivity and thereby open up surprising sources of fresh teaching? Do it now!













(June 21-July 22): One theory says that humans evolved to be afraid of reptiles because our early ancestors were frequently threatened by them. Among the most commonly feared creatures in modern culture are snakes. And yet, as anyone knows if they’ve studied mythology, snakes have also been symbols of fertility and healing in many cultures. Because they periodically shed their skin, they also represent regeneration and rebirth. I’m hoping you don’t harbor an instinctual aversion to snakes, Cancerian. The coming weeks will be a favorable time for you to call on and benefit from their iconic powers.
(July 23-Aug. 22): In the coming months, be extra creative as you enhance your network of connections and support. Encourage your allies to provide you with tips about opportunities and possibilities that you would not otherwise know about. Ask them to serve as links to novel resources that will nurture your long-term dreams. Here’s an idea to energize your efforts: Get a vivid sense of how trees use vast underground fungal webs to communicate with each other. (Learn more here: bit.ly/TheWoodWideWeb) Knowing about this natural magic may impregnate your subconscious mind with evocative suggestions about how to be ingenious in weaving the kind of community you want.


(Aug. 23-Sept. 22): I love my job as a horoscope writer. What could be more fun than analyzing cosmic signs to generate inspirational counsel for my readers? It’s a big responsibility, though. I am intensely aware of how crucial it is that I craft my messages with utmost care and compassion. Having been scarred as a young adult by reckless, fearmongering fortune-tellers, I’m rigorous about nurturing your free will, not undermining it. I want you to be uplifted, not confused or demoralized as I was. With these thoughts in mind, I invite you to take a vigorous inventory
(Dec. 22-Jan. 19): Bristlecone pine trees grow very slowly, but they are hardy and long-lived. Their wood is so dense and strong that it’s virtually immune to disease, insects, and erosion. They grow in places that are inhospitable for many other trees, flourishing in cold, windy environments where the soil is not particularly rich in nutrients. For the bristlecone pine, apparent obstacles stimulate their resilience. I don’t want to exaggerate the ways they remind me of you Capricorns, but you and they certainly have affinities. I believe these shared qualities will be especially useful for you in the coming weeks.
(Jan. 20-Feb. 18): In old Hawai‘i, it was forbidden for ordinary people to touch objects that belonged to the chiefs or to anyone with spiritual powers. Other taboos: Never walk across the shadow of an important person, and never wear red and yellow feathers. Our modern taboos are different, but often equally rigid. For example, you are probably hesitant to ask people how much money they make or what their relationship status is. What are other taboos you observe? I won’t outrightly advise you to brazenly break them, but now is a good time to reevaluate them and consider changing your relationship with them.
(Feb. 19-Mar. 20): As winter progresses, each day is longer and each night shorter. Most humans feel an undercurrent of joy that the amount of light in the world is growing. But as an astrologer who appreciates cycles, I like to honor the beauty and powers of darkness. That’s where everything new gets born! It’s where the future comes from! In ancient Hawaiian religion, the word kumulipo meant “beginning-in-deep-darkness.” It was also the name of a prayer describing the creation of the world. In the coming weeks, I believe you will be wise to tap into the rich offerings of darkness.
ENGINEERING
STAFF DATA Engineer, Job #
2024‑01‑001SKK (Procore Technologies, Inc.; Carpinteria, CA): Design & develop data products using object‑oriented analysis, design & programming skills, & design patterns. Telecommuting permitted from anywhere in the U.S.
Salary: $193,844 to $266,535/yr. Applicants should email their resume to: external.recruitment@procore.com. Ref job #. An EOE.
FINANCE
STRUGGLING WITH debt? If you have over $10,000 in debt we help you be debt free in as little as 24‑48 months. Pay nothing to enroll. Call Now
1‑877‑435‑4860 (Cal‑SCAN)
HEALTH & FITNESS
ATTENTION OXYGEN therapy users! Discover oxygen therapy that moves with you with Inogen Portable Oxygen Concentrators.Free information kit. 1‑866‑477‑9045
ATTENTION: VIAGRA and CIALIS USERS!
A cheaper alternative to high drugstore prices! 50 Pill Special ‑ Only $99! 100% guaranteed. CALL NOW: 1‑888‑256‑9155 (Cal‑SCAN)
DENTAL INSURANCE from Physicians Mutual Insurance Company. Coverage for 400 plus procedures. Real dental insurance ‑ NOT just a discount plan. Do not wait! Call now! Get your FREE Dental Information Kit with all the details! 1‑844‑203‑2677 www.dental50plus.com/calnews #6258 (Cal‑SCAN)
DENTAL INSURANCE from Physicians Mutual Insurance Company. Coverage for 400+ procedures. Real dental insurance ‑ not just a discount plan. Get your free Information Kit with details! 1‑855‑526‑1060 www.dental50plus. com/ads #6258
SAFE STEP. North America’s #1 Walk‑In Tub. Comprehensive lifetime warranty. Top‑of‑the‑line installation and service. Now featuring our FREE shower package and $1600 Off for a limited time! Call today! Financing available. Call Safe Step 1‑888‑989‑5749 (Cal‑SCAN).
PRODUCT MANAGER for life sciences instrumentation company. Position duties are supporting the development of Nanoscale Infrared Spectroscopy (nanoIR) and Scattering Scanning Nearfield Optical Microscopy (sSNOM) equipment and systems including reviewing customer specifications; developing market requirements documentation; driving products through the product lifecycle process; and analyzing nanoIR market trends and research developments. Requires a PhD in Chemistry, Materials Science or a related field that included experience utilizing sSNOM technology for 2D and 1D material research applications. Salary range for position is $138,000 to $148,000. Position is located in Santa Barbara, CA and requires 30% travel. Send resume to Bruker Nano by email to Andy McCue at Andrew.mccue@bruker.com. Please reference PMNIR in response.

FACILITIES MANAGEMENT
Oversees the management, coordination, and performance of multiple FM operational activities and services including maintenance support, Work Service Center call triage and tracking of repair services, campus communications related to infrastructure and safety issues, and procurement services for Design, Facilities, and Safety Services (DFSS). Oversees the computerized maintenance management system (CMMS) program to ensure efficient flow of work orders through the system and supervises the flow of all maintenance work through the system. Manages a variety of data and records to accurately account for labor, materials, tools, equipment and rolling stock. Works closely with a varied clientele ranging from custodial, grounds and trades staff to architects, project managers and design engineers to ensure that work is completed to maximum customer satisfaction. Oversees all aspects of the Facilities Management Storeroom Operations and inventory management of over 5000 skus with an estimated value of $1M worth of materials. Directs and coordinates activities of the Storeroom Operations and Procurement Services with the annual average spend of $7M. Facilitates forecasting and strategic planning for FM. Creates and maintains effective “benchmarks” for production work to include the cost of materials, cost of labor, cost of materials used, and other resources. Develops key indicators related to FM performance, planning and delivery, equipment performance and run‑time. Analyzes FM data and makes recommendations for improvements. Responds to system‑wide requests for information regarding FM’s business matters. Provides oversight, coordination and liaison with university organizations including but not limited to: Equipment Management, Design & Construction Services, Housing, Dining & Auxiliary Services, Business & Financial Services, External and Internal Audit, Office of the President as well as outside service enterprises to resolve any Facilities Management issues or plans for operational improvement that may affect the campus community. Plans, develops and manages an operating budget for the Operations Unit including the forecasting and reporting of future growth and needs. Reqs: Bachelor’s degree. 4‑6 years’ experience in the utilization of maintenance management software applications. Strong skills to facilitate and collaborate with diverse internal and external constituencies on short‑ and long ‑term facilities planning and management. Strong interpersonal skills including verbal and written communication, active listening, critical thinking, persuasiveness, advising and counseling skills. Demonstrated ability to manage, supervise, and direct a professional and skilled‑level staff of highly specialized and technical personnel, including the knowledge and ability to effectively plan, organize, and coordinate work in situations where numerous diverse demands are involved. Knowledge and understanding of modern management principles, practices, methods, procedures, and techniques. Thorough knowledge and ability sufficient to interpret and
provide guidance on complex written material and specifications, and knowledge sufficient to make clear and accurate oral and written presentations.
Strong analytical, research, and report preparation skills to meet regulatory and budgetary reporting requirements. Strong knowledge of University rules and regulations, processes, protocols, and procedures for budget, accounting, and fund management. Proven experience managing multi‑functional and diverse programs of significant budgetary impact to both the overall campus and department. Advanced expertise in administering a proactive maintenance program utilizing FM software. Strong skills in management, regulatory compliance, and operations planning. Proven successful track record and understanding of work production, scheduling, and coordination; material and service contracting; client relations; material acquisition, storage and delivery typical to a large, complex facilities maintenance operation. Broad knowledge of building trades, associated language, maintenance materials, and purchasing practices. Advanced knowledge of construction and maintenance repair materials and parts. Strong skill in ensuring assistance to shop personnel and field technicians in identifying and sourcing parts through local vendors. Notes: Maintain a valid CA driver’s license, a clean DMV record and enrollment in the DMV Employer Pull‑Notice Program. Satisfactory criminal history background check. Pay Rate/ Range: $125,000.00 to $140,000.00/ year. The University of California is an Equal Opportunity/Affirmative Action Employer, and all qualified applicants will receive consideration for employment without regard to race, color, religion, sex, sexual orientation, gender identity, national origin, disability status, protected veteran status, or any other characteristic protected by law. Please visit: https:// policy.ucop.edu/doc/4010393/PPSM‑20; https://policy.ucop.edu/doc/1001004/ Anti‑Discrimination. Open until filled. Apply online at https://jobs.ucsb.edu Job # 75086

CAMPUS DINING
Manages the culinary operation of Campus Catering, Conference Catering and Departmental Catering areas
($2 million annually), assisting with establishing production standards, cooking processes and procedures for day to day operations. The Campus Catering Chef is responsible for training production personnel in food preparation, display design, equipment usage, proper food handling, recipe testing, and creative menu planning and innovations. Implements budget plans and cost control techniques during the academic year and the Summer conference season. Supervises service and staff for special high profile campus related events requiring knowledge of the academic and political climate on campus. Ensures high quality food and presentation for all catering events on campus and off campus, ranging from groups of 10 to 2000. Helps create and maintain an effective team that takes pride in their product and services and inspires them through modeling catering as an art form and platform for using creativity and new skills. Ensures that food quality and safety guidelines are established and consistently maintained to achieve the highest public health standards and reduce the risk
of food borne illness. Responsibilities include direct supervision of 2 Senior Cooks and on‑site supervision of up to 20 full‑time cooks, and up to 30 student cooks throughout the year, as well as kitchen management and production during the summer conference season. Reqs: Extensive previous catering experience with a strong command of fundamentals. Demonstrated ability to organize and manage a high volume kitchen as well as produce specially requested menu items. Ability to take on last minute events and prioritize workload. Extremely organized and detail oriented, specialized in utilizing the freshest of ingredients and producing items from scratch with an artistic and innovative presentation. Experience in plated service, baking, appetizers, and hot/cold food buffets. Demonstrated ability to develop and implement a wide variety of menus incorporating varied ethnic cuisines and current trends. Working knowledge of excel and word programs. Knowledge of state and federal safety and sanitation regulations regarding proper handling, storing, cooking and holding temperatures and proper use and cleaning of kitchen equipment. Ability to train others in these areas Or equivalent combination of education and experience. Notes: Satisfactory criminal history background check UCSB is a Tobacco‑Free environment. Must maintain valid CA DL, a satisfactory DMV record and enrollment in DMV Pull‑Notice Program. Able to work a flexible schedule including evenings and weekends. Hiring/Budgeted Salary Range: $58,600.00/yr ‑ $73,500.00/ yr Full Salary Range:$58,600.00/yr ‑ $78,000.00/yr. UC Santa Barbara is an Equal Opportunity/Affirmative Action Employer. All qualified applicants will receive consideration for employment without regard to race, color, religion, sex, sexual orientation, gender identity, national origin, disability, age or protected veteran status. For the University of California’s Affirmative Action Policy, please visit: https:// policy.ucop.edu/doc/4010393/PPSM‑20. For the University of California’s Anti‑Discrimination Policy, please visit: https://policy.ucop.edu/doc/1001004/ Anti‑Discrimination. Open until filled. Apply online at https://jobs.ucsb.edu, Job #75495

ENVIRONMENTAL HEALTH AND SAFETY
Serves as the Claims Assistant for Risk Management and Workers’ Compensation Programs. Receives, collects and enters claim information into relevant databases and prepares reports. Serves as employee liaison to the University’s self‑insurance programs and provides administrative assistance. Supports various components of the programs including general and auto liability, auto physical damage, property, employment liability, business travel and workers’ compensation. In a highly confidential environment, works with a diverse clientele, including faculty, staff, students, Third Party Administrators, Office of the President, attorneys and external agencies. Provides administrative support to the department as directed. Reqs: High school diploma or equivalent experience. Ability to work independently as well as with others. Organized and detail‑oriented with ability to handle frequent interruptions. Demonstrates strong organizational skills and attention to accuracy and detail. Ability to establish and maintain
job priorities when there are changes in the workload and competing deadlines. Excellent interpersonal skills and ability to provide excellent customer service when interacting with administrators, faculty, staff, students and visitors. Ability to maintain confidentiality. Thorough knowledge in administrative procedures and processes including word processing, spreadsheet and database applications. Requires good verbal and written communication skills, active listening, critical thinking, multi‑task and time management skills. Requires interpersonal and work leadership skills to provide guidance to other nonexempt personnel. Notes: Maintain a valid CA driver’s license, a satisfactory DMV record and enrollment in the DMV Employer Pull‑Notice Program.Satisfactory criminal history background check. Budgeted salary range: $32.67 to $34.17/hr. Full salary range $28.44 to $ 40.76/hr. The University of California is an Equal Opportunity/ Affirmative Action Employer, and all qualified applicants will receive consideration for employment without regard to race, color, religion, sex, sexual orientation, gender identity, national origin, disability status, protected veteran status, or any other characteristic protected by law. For the University of California’s Affirmative Action Policy, please visit: https:// policy.ucop.edu/doc/4010393/PPSM‑20. For the University of California’s Anti‑Discrimination Policy, please visit: https://policy.ucop.edu/doc/1001004/ Anti‑Discrimination. Open until filled. Apply online at https://jobs.ucsb.edu Job #75615

RESIDENTIAL AND COMMUNITY LIVING
Is charged with the responsibility of articulating and educating the Housing and Residential Communities on resident policies, procedures and community standards. The Conduct Officer: ‑Develops and implements programs for Lead staff, resident assistants and student‑residents on Residence Hall/Apartment Living community standards ‑Assists in the investigation, adjudication and general resolution of cases referred to Resident Student Conduct (Housing) and the Office of Judicial Affairs ‑Maintains and updates the curriculum for HDAE Personal Responsibility and Fire Safety courses. Leads/co‑leads the facilitation of these courses throughout the academic year ‑Serves as an institutional contact and referral point for students, parents and clients who have questions and concerns regarding the judicial process. ‑Co‑advises and trains the Peer Review Board ‑Responsible for maintaining the conduct case management database/ system (Advocate) ‑Responsible for the coordination of conduct hearings and restorative justice circles. Reqs: Bachelor’s degree in related area and / or equivalent experience / training Experience working in a confidential environment. Experience adjudicating a student conduct caseload with strict adherence to due process procedures. Outstanding interpersonal skills
in working with college students; para‑professional counseling skills required. Strong analytical and computer skills for the collecting, coding and recording of disciplinary files. Outstanding administrative and organizational skills. Thorough knowledge of advising and counseling techniques. Strong knowledge of common University‑specific computer application programs and knowledge of University and departmental principles and procedures involved in risk assessment and evaluating risks as to likelihood and consequences. Thorough knowledge of Student Affairs / Student Life specialization. Skills in judgment and decision‑making, problem solving, identifying measures of system performance and the actions to improve performance. Abilities in project management, problem identification and reasoning skills. Ability to develop original ideas to solve problems. Notes: UCSB Campus Security Authority under Clery Act Satisfactory criminal history background check. Budgeted Salary Range: $58,600 to $79,700/ year. Full Salary Range: $58,600 to $100,800/year. UC Santa Barbara is an Equal Opportunity/Affirmative Action Employer. All qualified applicants will receive consideration for employment without regard to race, color, religion, sex, sexual orientation, gender identity, national origin, disability, age or protected veteran status. For the University of California’s Affirmative Action Policy, please visit: https:// policy.ucop.edu/doc/4010393/PPSM‑20. For the University of California’s
Continued on p. 40



Anti‑Discrimination Policy, please visit:
https://policy.ucop.edu/doc/1001004/
Anti‑Discrimination Open until filled. Apply online at https://jobs.ucsb.edu
Job #75357

DINING ASSOCIATE
CAMPUS DINING
The Conference Dining Associate, under the supervision of the Conference
Dining Manager, plans, organizes and manages dining and catering content for assigned, moderately complex summer conference programs on campus and at University‑owned apartments. The Conference Dining Associate interacts with a diverse clientele, including University professors and commercial program directors, to assess and determine how a program’s dining and catering needs can be met by our services and facilities, or other on and off‑campus resources. Serves as a planning consultant to event organizers to ensure that all dining and catering details have
ANNOUNCEMENTS
24/7 LOCKSMITH: We are there when you need us for home & car lockouts. We’ll get you back up and running quickly! Also, key reproductions, lock installs and repairs, vehicle fobs. Call us for your home, commercial and auto locksmith needs! 1‑833‑237‑1233.
ATTENTION: VIAGRA and CIALIS
USERS! A cheaper alternative to high drugstore prices! 50 Pill Special ‑ Only $99! 100% guaranteed. CALL NOW:
1‑866‑472‑4367
BATH & SHOWER UPDATES in as little as ONE DAY! Affordable prices ‑ No payments for 18 months! Lifetime warranty & professional installs. Senior & Military Discounts available. Call: 1‑877‑510‑9918.
BEAUTIFUL BATH UPDATES in as little as ONE DAY! Superior quality bath and shower systems at AFFORDABLE PRICES! Lifetime warranty & professional installs. Call Now! 1‑855‑402‑6997
CASH PAID FOR HIGH‑END MEN’S SPORT WATCHES. Rolex, Breitling, Omega, Patek Philippe, Heuer, Daytona, GMT, Submariner and Speedmaster. These brands only! Call for a quote: 1‑855‑402‑7109
DIRECTV STREAM ‑ Carries the most local MLB Games! Choice Package $89.99/mo for 12 mos Stream on 20 devices at once. HBO Max
included for 3 mos (w/Choice Package or higher.) No contract or hidden fees! Some restrictions apply. Call IVS
1‑866‑859‑0405
GOT AN UNWANTED CAR??? DONATE IT TO PATRIOTIC HEARTS. Fast free pick up. All 50 States. Patriotic Hearts’ programs help veterans find work or start their own business. Call 24/7: 1‑855‑402‑7631
MOBILEHELP AMERICA’S premier mobile medical alert system. Whether you’re home or away. For safety & peace of mind. No long term contracts! Free brochure! Call 1‑888‑489‑3936
WE BUY houses for cash as is! No repairs. No fuss. Any condition. Easy three step process: Call, get cash offer & get paid. Get your fair cash offer today by calling Liz Buys Houses: 1‑844‑877‑5833
WESLEY FINANCIAL Group, LLC Timeshare Cancellation Experts Over $50,000,000 in timeshare debt & fees cancelled in 2019. Get free info package & learn how to get rid of your timeshare! Free consultations. Over 450 positive reviews. 833‑308‑1971.
PRIVATE FITNESS SB All ages/levels, friendly expert trainers In‑home 1‑on‑1 guided exercise Book TODAY: www.raresolfit.com Or email: contact@raresolfit.com
STORM DAMAGE? You need a local expert provider that proudly stands behind their work. Fast, free estimate. Financing available. Call 1‑888‑292‑8225
BATH & SHOWER UPDATES in as little as ONE DAY! Affordable prices ‑ No payments for 18 months! Lifetime warranty & professional installs. Senior & Military Discounts available. Call: 1‑877‑252‑9868 (Cal‑SCAN) DON’T PAY For Covered Home Repairs Again! Our home warranty covers ALL MAJOR SYSTEMS AND APPLIANCES. We stand by our service and if we can’t fix it, we’ll replace it! Pick the plan that fits your budget! Call:1‑855‑411‑1731 (Cal‑SCAN) JACUZZI BATH Remodel can install a new, custom bath or shower in as little as one day. For a limited time, we’re waiving ALL installation costs. (Additional terms apply. Subject to change and vary by dealer. Offer ends 6/30/24 Call 1‑833‑985‑4766 (Cal‑SCAN)
GENERAL SERVICES
VAN DRIVER NEEDED. Must be hard working, reliable and customer service oriented individuals that provide world‑class service experience in a positive and compassionate manner. Driver Must demonstrate a high level of resourcefulness and flexibility. Must be Professional with excellent communication skills. Contact (Ryanshmaltz@gmail.com) for more details.
HOME SERVICES
AGING ROOF? New Homeowner? Got Storm Damage? You need a local expert provider that proudly stands behind their work. Fast, free estimate. Financing available. Call 1‑888‑878‑9091
AGING ROOF? NEW HOMEOWNER?
been considered, working with the client’s needs and budget parameters, developing a comprehensive services package that includes vendor contracts. Determines scope of project, timelines and unit requirements to fulfill service agreements. Reqs: Two to three years of experience and strong knowledge in event planning and management in the hospitality sector. Exceptional customer service skills with ability to cultivate professional business partnerships. Proficiency with Microsoft applications and general database management. Ability to learn specialized software systems quickly. Working knowledge of Google Workspace. Or equivalent combination of education and experience. Notes: Satisfactory criminal history background check. Must maintain valid CA DL, a satisfactory DMV record and enrollment in DMV Pull‑Notice Program. Work hours/days may vary during the summer season. Overtime may be required from May‑August to meet the operational needs of the department. Hiring/ Budgeted Hourly Range: $28.07 ‑ $ 33.07/hr. The University of California is an Equal Opportunity/Affirmative Action Employer, and all qualified applicants will receive consideration for employment without regard to race, color, religion, sex, sexual orientation, gender identity, national origin, disability status, protected veteran status, or any other characteristic protected by law. Please visit: https:// policy.ucop.edu/doc/4010393/PPSM‑20; https://policy.ucop.edu/doc/1001004/ Anti‑Discrimination. Open until filled. Apply online at https://jobs.ucsb.edu Job #75435

ELIMINATE GUTTER cleaning forever! LeafFilter, the most advanced debris‑blocking gutter protection. Schedule free LeafFilter estimate today. 20% off Entire Purchase. 10% Senior & Military Discounts. Call 1‑833‑610‑1936
NEED NEW WINDOWS? Drafty rooms? Chipped or damaged frames? Need outside noise reduction? New, energy efficient windows may be the answer! Call for a consultation & FREE quote today. 1‑877‑248‑9944.
PEST CONTROL: PROTECT YOUR HOME from pests safely and affordably. Roaches, Bed Bugs, Rodent, Termite, Spiders and other pests. Locally owned and affordable. Call for service or an inspection today! 1‑833‑237‑1199.
WATER DAMAGE CLEANUP & RESTORATION: A small amount of water can lead to major damage and mold growth in your home. We do complete repairs to protect your family and your home’s value! For a FREE ESTIMATE, call 24/7: 1‑888‑290‑2264
WATER DAMAGE CLEANUP & RESTORATION: A small amount of water can lead to major damage in your home. Our trusted professionals do complete repairs to protect your family and your home’s value! Call 24/7: 1‑888‑248‑0815. Have zip code of service location ready when you call! (Cal‑SCAN)
WATER DAMAGE cleanup: A small amount of water can cause major damage to your home. Our trusted professionals dry out wet areas & repair to protect your family & your home value! Call 24/7: 1‑888‑872‑2809. Have zip code!
Performs culinary duties such as preparing soups and casseroles, grilling, roasting or barbecuing foods, working a sauté station, and preparing and assembling made‑to‑order entrees serving up to 1,500 meals per shift. Ensures that assigned responsibilities are accomplished and that high standards of food quality, service, sanitation and safety are met at all times. Assists with student training, food production and sanitation. Reqs: High School Diploma. 1‑3 years Culinary experience in a high‑volume culinary environment. 1‑3 years Knowledge of and experience with culinary techniques, including but not inclusive of sautéing, grilling, frying, steaming, preparing sauces and stocks. Or equivalent combination of education and experience. Notes: Ability to lift up to 50 pounds and work standing for up to 8 hours per day. Satisfactory criminal history background check. Work hours/days may vary. Hiring/ Budgeted Hourly Range: $ 20.12 ‑ $ 22.21/hr. The University of California is an Equal Opportunity/Affirmative Action Employer, and all qualified applicants will receive consideration for employment without regard to race, color, religion, sex, sexual orientation, gender identity, national origin, disability status, protected veteran status, or any other characteristic protected by law. For the University of California’s Affirmative Action Policy, please visit: https://policy. ucop. edu/doc/4010393/PPSM‑20. For the University of California’s Anti‑Discrimination Policy, please visit: https://policy.ucop.edu/doc/1001004/ Anti‑Discrimination. Open until filled. Apply online at https://jobs.ucsb.edu Job #75608

Assists with all aspects of planning, analysis, implementation, and ongoing administration of the Development activities required to support a
successful and complex Development Team (D‑Team) in Gevirtz Graduate School of Education (GGSE). Manages online calendars, screens incoming calls, and makes travel/entertainment arrangements for D‑Team; completes and tracks administrative paperwork related to gift processing and budget expenses in compliance with policies and procedures; supports with the generation of gift documentation, donor correspondence, and donor stewardship communications; maintains electronic and hard‑copy files related to D‑Team activities; compiles data and reports from various sources including Advance database, requiring high degree of initiative, confidentiality, discretion, and strong analytical/technical capacity; assists with planning and execution of donor events; supports D‑Team social media activity and administrative tasks related to online community development; works collaboratively with various administrative support staff members from GGSE and Central Development; handles confidential, high profile, and time sensitive matters involving senior UCSB administrators, faculty, staff, collaborating institutions and the donor community, requiring discretion and highly professional written and verbal communication. Reqs: HS Diploma or equivalent experience; 1‑3 yrs using exceptional verbal and interpersonal skills that foster positive relationships with diverse populations; Excellent computer skills including proficiency in Word, Excel, PowerPoint, Internet and e‑mail and demonstrated ability to quickly learn various software programs; Ability to maintain strict confidentiality in all aspects of work. Notes: Satisfactory criminal history background check. Pay Rate/Range: The budgeted salary range is $28.44 ‑ $29.78/hr. The University of California is an Equal Opportunity/Affirmative Action Employer, and all qualified applicants will receive consideration for employment without regard to race, color, religion, sex, sexual orientation, gender identity, national origin, disability status, protected veteran status, or any other characteristic protected by law. Please visit: https:// policy.ucop.edu/doc/4010393/PPSM‑20; https://policy.ucop.edu/doc/1001004/ Anti‑Discrimination. Open until filled. Apply online at https://jobs.ucsb.edu Job #75432

UNIVERSITY CENTER
Under general direction from the Director, University Center & Events Center Administration, manages the financial accounting, fiscal operations, and financial analysis for the University Center (UCEN) and Events Center (ECEN) business operations. Providing sound fiscal practice in management of revenues and expenses, the incumbent posts revenue and expense accounts to the general ledger; provides categorical breakdown of revenue and expenses for all department budgets and cost centers. Prepares and processes TOE’s, TOF’s, and financial journals. Prepares monthly profit and loss statements by fund source. Provides the Director extensive research, analysis, advice and recommendations on a wide variety of financial issues. Using independent judgment, prepares and analyzes a wide variety of financial reports as well as monitors and analyzes expenditures and spending patterns. Works closely with the Director on special projects within the UCEN and ECEN. Reqs: 1‑3 years relevant work experience. Working knowledge of financial processes, policies and procedures. Strong knowledge of financial data management and reporting systems. Proficiency in the use of spreadsheet and database software. Skills to provide coaching and mentorship to support staff. Ability to successfully function as a member of a team. Must possess the ability to work at a high level of professionalism and work well under pressure, to meet deadlines and other needs of the Director. Ability to exercise good judgment, common sense, and discretion, and to employ creative solutions, in assessing and
solving problems. Demonstrated communication and interpersonal skills, ability to work independently, and with critical attention to detail. Notes: Willingness to work a few weekends a year during fall move in and spring commencement. Satisfactory criminal history background check. Budgeted pay rate: $28.07 to $38.17/ year. The University of California is an Equal Opportunity/Affirmative Action Employer, and all qualified applicants will receive consideration for employment without regard to race, color, religion, sex, sexual orientation, gender identity, national origin, disability status, protected veteran status, or any other characteristic protected by law. Please visit: https:// policy.ucop.edu/doc/4010393/PPSM‑20; https://policy.ucop.edu/doc/1001004/ Anti‑Discrimination. Open until filled. Apply online at https://jobs.ucsb.edu, Job #75454

OF CHEMISTRY & BIOCHEMISTRY
Provides support in all aspects of the graduate program. Provides Department and University policy and procedural information to current and prospective graduate students, faculty, and staff. Serves as liaison between students, faculty, and other campus administrative units and control points. Is responsible for advising approximately 175 graduate students on a variety of academic issues and ensures students are making progress towards their degree and career goals while remaining within established university and program guidelines and regulations. Manages graduate student records, program data and statistics and is responsible for overseeing all publications for the graduate program. Working with the student affairs team, the Graduate Program Advisor participates in policy decisions and program development to support faculty initiatives and encourage student academic success. Is responsible for the overall coordination and administration of graduate student recruitment, admission, outreach and new student orientation processes. In collaboration with the Payroll Coordinator, advises graduate students on academic appointments and employment matters. Is expected to be strongly committed to the program and to the welfare of the students, maintaining a climate of interpersonal support while exercising independent professional judgment and creative problem solving skills. Reqs: 1‑3 years of directly related experience, preferably in a higher education institution. Bachelor’s Degree in related area or equivalent experience and/or training. Note: Satisfactory conviction history background check The full hourly range is $24.95 to $42.10/ hr. The budgeted hourly range is $24.95 to $33.52/hr. The University of California is an Equal Opportunity/Affirmative Action Employer, and all qualified applicants will receive consideration for employment without regard to race, color, religion, sex, sexual orientation, gender identity, national origin, disability status, protected veteran status, or any other characteristic protected by law. For more information: https://policy.ucop.edu/doc/4010393/ PPSM‑20 and https://policy.ucop.edu/ doc/1001004/Anti‑Discrimination. Open until filled. Apply online at https://jobs. ucsb.edu, Job # 75508.

RESIDENTIAL OPERATIONS
Performs general duties related to the maintenance and operations of the irrigation systems, both manual and automatic, throughout HDAE. Performs other duties in the field of general grounds maintenance such as mowing, weed whipping, hedge clipping and other duties as assigned. Reqs: 1‑3
years Performing a variety of advanced semi‑skilled irrigation duties including installing, repairing, and maintaining manual and automatic irrigation systems and related equipment.
Notes: May work shifts other than Monday ‑ Friday 7:00 am ‑ 3:30 pm, to meet the operational needs of the department. Subject to occasional emergency call‑outs and repair work.
Maintain a valid CA driver’s license, a satisfactory DMV record and enrollment in the DMV Employer Pull‑Notice Program. Satisfactory criminal history background check. Pay Rate/Range: $24.94 ‑ $29.20/hour. The University of California is an Equal Opportunity/ Affirmative Action Employer, and all qualified applicants will receive consideration for employment without regard to race, color, religion, sex, sexual orientation, gender identity, national origin, disability status, protected veteran status, or any other characteristic protected by law. For the University of California’s Affirmative Action Policy, please visit: https:// policy.ucop.edu/doc/4010393/PPSM‑20.
For the University of California’s Anti‑Discrimination Policy, please visit: https://policy.ucop.edu/doc/1001004/ Anti‑Discrimination. Open until filled. Apply online at https://jobs.ucsb.edu
Job #75630

FACULTY CLUB & GUEST HOUSE
Assists in the preparation of food for meal service and catering events in the Club & Guest House Restaurant. Performs culinary duties, quality assurance on all menu items, with attention to detail on presentation. Assists the Club Chef with food production and supervision of the part time student culinary team. Under the direction of the Club Chef, assists in the production of food for The Club & Guest House Restaurant. Tasks include menu item preparation and the production of hot and cold menued items that meet the quality and guidelines of The Club & Guest House. Reqs: High School Diploma or equivalent combination of education and experience. 1‑3 years Experience in a restaurant or high‑volume culinary kitchen. 1‑3 years Knowledge of and experience with culinary techniques, including but not inclusive of sautéing, grilling, frying, steaming, preparing sauces and stocks. Notes: Ability to lift up to 50 pounds and work standing for up to 8 hours. Work days and hours will vary, evenings and weekends included. Satisfactory criminal history background check. Budgeted hourly range: $20.12 to $22.21/hour. The University of California is an Equal Opportunity/Affirmative Action Employer, and all qualified applicants will receive consideration for employment without regard to race, color, religion, sex, sexual orientation, gender identity, national origin, disability status, protected veteran status, or any other characteristic protected by law. Please visit: https:// policy.ucop.edu/doc/4010393/PPSM‑20; https://policy.ucop.edu/doc/1001004/ Anti‑Discrimination. Application review begins 1/28/25. Apply online at https:// jobs.ucsb.edu, Job #75466

MULTICULTURAL CENTER
The MCC Office and Space Coordinator reports directly to the MCC Director. Must be aware of concerns, pressures, and inequities affecting marginalized communities, including people of color and people with diverse sexual orientations. Must be willing to work as a member of a team of staff and students advocating for the above mentioned populations. Responsible for the physical aspect of day to day operations of a 150‑seat theater, a lounge/gallery space that seats 70 people, two small meeting rooms and a kitchen. Manages the office independently, schedules the entire space, and oversees equipment
and technology needs. Responsible for hiring, training, and supervising student staff. Manages logistics and assists with publicity strategies for events. Supports special projects and other duties as assigned. Reqs: HS diploma or equivalent experience; Administrative and supervisory experience with students; Experience working with theater and/or audio visual equipment; Knowledge in administrative procedures and processes including word processing, spreadsheet and database applications; Requires strong interpersonal and good verbal and written communication skills, active listening, analytical and critical thinking, and time and organizational management skills; Knowledge of social justice issues, both current and historical and knowledge of social justice frameworks; Able to adapt to multiple competing deadlines, with attention to details, and the frequent need to troubleshoot problems. Notes: Occasionally will be required to work nights and weekends; Mandated reporting requirements of Child Abuse; UCSB Campus Security Authority under Clery Act; Satisfactory criminal history background check; UCSB is a Tobacco‑Free environment. Hiring/ Budgeted Salary or Hourly Range: The budgeted salary range is $28.44 ‑ $29.07/hr. The full salary range for this position is $28.44 ‑ $40.76/ hr. The University of California is an Equal Opportunity/Affirmative Action Employer, and all qualified applicants will receive consideration for employment without regard to race, color, religion, sex, sexual orientation, gender identity, national origin, disability status, protected veteran status, or any other characteristic protected by law. Please visit: https:// policy.ucop.edu/doc/4010393/PPSM‑20; https://policy.ucop.edu/doc/1001004/ Anti‑Discrimination. Open until filled. Apply online at https://jobs.ucsb.edu, Job #75421.

STUDENT HEALTH
Under the general direction of the Student Health Medical Director, the Physical Therapy Supervisor is responsible for the operation of the Student Health Physical Therapy department which has a staff of 2 physical therapists, a physical therapist specializing in orthotics (independent contractor), 1 physical therapy assistant, a physical therapy aide and an office manager. Duties include but are not limited to: designing the master schedule, managing equipment, ensuring patient satisfaction, managing staff issues and providing direct outpatient care to UCSB students. Reqs: Must have a California Physical Therapist license with specialization in outpatient orthopedic therapy. Bachelor’s Degree in related area and/or equivalent experience/training. Master’s Degree or Doctorate from an accredited postgraduate program. Experience in orthopedic physical therapy rehabilitation. Experience in pelvic floor and postural restoration. Notes: Mandated reporting requirements of Child Abuse and Adult Dependent Abuse. Student Health requires that clinical staff must successfully complete and pass the background check and credentialing process before the start date. To comply with Santa Barbara County Public Health Department Health Officer Order, this position must provide evidence of annual influenza vaccination, or wear a surgical mask while working in patient care areas during the influenza season. Per California Code of Regulations Title 8, Section 5199 Aerosol Transmissible Disease Standard requires; upon hire and annually thereafter Tuberculosis (TB) screening for all employees. The method of testing is determined by past medical history and any current symptoms. Per Cal/OSHA regulations and UCSB Campus Policy, all UCSB personnel who use respiratory protection equipment shall be included in the UCSB Respiratory
AFFORDABLE TV & INTERNET. If you are overpaying for your service, call now for a free quote and see how much you can save! 1‑844‑588‑6579.
BATH & shower updates in as little as 1 day! Affordable prices ‑ No payments for 18 months! Lifetime warranty & professional installs. Senior & military discounts available. 1‑877‑543‑9189
BECOME A published author. We want to read your book! Dorrance Publishing trusted since 1920.Consultation, production, promotion & distribution. Call for free author’s guide 1‑877‑729‑4998 or visit dorranceinfo.com/ads
CONSUMER CELLULAR ‑ same reliable, nationwide coverage as the largest carriers. No long‑term contract, no hidden fees free activation. All plans feature unlimited talk & text, starting at just $20/mo. Call 1‑877‑751‑0866
CONSUMER CELLULAR ‑ the same
reliable, nationwide coverage as the largest carriers. No long‑term contract, no hidden fees and activation is free.
All plans feature unlimited talk and text, starting at just $20/month. For more information, call 1‑844‑908‑0605 (Cal‑SCAN)
DID YOU KNOW Newspaper‑generated content is so valuable it’s taken and repeated, condensed, broadcast, tweeted, discussed, posted, copied, edited, and emailed countless times throughout the day by others? Discover the Power of Newspaper Advertising. For a free brochure call 916‑288‑6011 or email
cecelia@cnpa.com (Cal‑SCAN)
DON’T LET the stairs limit your mobility! Discover the ideal solution for anyone who struggles on the stairs, is concerned about a fall or wants to regain access to their entire home. Call AmeriGlide today!
1‑833‑399‑3595
ELIMINATE GUTTER cleaning forever! LeafFilter, the most advanced
Adult Beginner Flamenco Dance Classes Rosal Ortega Flamenco


Environmental Health & Safety. Any HIPAA or FERPA violation is subject to disciplinary action. Student Health is closed between the Christmas and New Year’s Day holidays. Hiring/Budgeted Salary Range: $101,100/year ‑ $146,700/ year. Full Salary Range: $101,100/ year ‑ $192,300/year. The University of California is an Equal Opportunity/ Affirmative Action Employer, and all qualified applicants will receive consideration for employment without regard to race, color, religion, sex, sexual orientation, gender identity, national origin, disability status, protected veteran status, or any other characteristic protected by law. For the University of California’s Affirmative Action Policy, please visit: https:// policy.ucop.edu/doc/4010393/PPSM‑20. For the University of California’s Anti‑Discrimination Policy, please visit: https://policy.ucop.edu/doc/1001004/ Anti‑Discrimination. Open until filled. Apply online at https://jobs.ucsb.edu Job #69547

PROJECT
COORDINATOR
RESIDENTIAL AND COMMUNITY LIVING Provides
debris‑blocking gutter protection.
Schedule a FREE LeafFilter estimate today. 20% off Entire Purchase. 10% Senior & Military Discounts. Call 1‑855‑424‑7581 (Cal‑SCAN)
GET A break on your taxes! Donate your car, truck, or SUV to assist the blind and visually impaired. Arrange a swift, no‑cost vehicle pickup and secure a generous tax credit for 2025. Call Heritage for the Blind Today at 1‑844‑491‑2884 today! (Cal‑SCAN)
HOME BREAK‑ins take less than 60 seconds. Don’t wait! Protect your family, your home, your assets now for as little as 70¢/day! 1‑844‑591‑7951
JACUZZI BATH Remodel can install a new, custom bath or shower in as little as one day. For a limited time, we’re cutting installation costs in half and offering a FREE safety upgrade!
Additional terms apply. Subject to change and vary by dealer.
Offer ends 3/31/24 Call 1‑844‑501‑3208
PORTABLE OXYGEN Concentrator may be covered by Medicare!
Reclaim independence and mobility with the compact design and long‑lasting battery of Inogen One.
Free information kit! Call 877‑305‑1535
PREPARE FOR power outages today with a Generac Home Standby Generator. Act now to receive a FREE 5‑Year warranty with qualifying purchase* Call 1‑855‑948‑6176 today to schedule a free quote. It’s not just a generator. It’s a power move.
REPLACE YOUR roof w/the best looking & longest lasting material steel from Erie Metal Roofs! 3 styles & multiple colors available. Guaranteed to last a lifetime! Limited Time Offer up to 50% off install + Additional 10% off install (military, health & 1st responders.) 1‑833‑370‑1234
STOP OVERPAYING FOR AUTO
INSURANCE! A recent survey says that most Americans are overpaying for their car insurance. Let us show you how much you can save. Call Now for a no‑obligation quote: 1‑866‑472‑8309
THE DIFFERENCE in winning and losing market share is how businesses use their advertising dollars. CNPA’s Advertising Services’ power to connect to nearly 13 million of the state’s readers who are an engaged audience, makes our services an indispensable marketing solution. For more info call Cecelia @ (916) 288‑6011 or cecelia@ cnpa.com.
YOU MAY QUALIFY for disability
benefits if you have are between 52‑63 years old and under a doctor’s care for a health condition that prevents you from working for a year or more. Call now! 1‑877‑247‑6750.
WE BUY Vintage Guitar’s! Looking for 1920‑1980 Gibson, Martin, Fender, Gretsch, Epiphone, Guild, Mosrite, Rickenbacker, Prairie State, D’Angelico, Stromberg. And Gibson Mandolins / Banjos. These brands only! Call for a quote: 1‑855‑402‑7208
RETIRED COUPLE $$$$ for business purpose Real Estate loans. Credit unimportant. V.I.P. Trust Deed Company www.viploan.com Call 1‑818‑248‑0000. Broker‑principal DRE 01041073. No consumer loans. (Cal‑ SCAN).
Contact advertising@independent.com for more details and in-print rates
and
and facilities management. Oversees the 8 Residence Hall front desks and works closely with building managers and student staff by directing the operational and facilities needs of the eight Front Desks. Coordinates the check‑in process for annual Move‑In/ Move‑out of the eight Residence Halls. Works in collaboration with R&CL Lead staff, Assignment Services, Operations, Parking Services, Conference Services, and Dining, Ucen, etc. Is the R&CL point person for Residence Halls staff and resident keys. Works in collaboration with locksmiths to train staff on key issuance/reconciliation. Coordinates key access as needed for new staff, and troubleshoots keyrelated issues. Coordinates with campus and outside partners on facilities related needs such as building access, staff office and apartment furniture, moving services and recreation equipment. Leads the Front Desk Committee, and coordinates the annual recruitment, hiring and training of Desk Attendants. Reqs: Bachelor’s degree in related area and / or equivalent experience / training. 1‑3 years college/university administration, or equivalent. 1‑3 years customer service experience. Interpersonal skills including verbal and written communication, active listening, critical thinking, persuasiveness, advising, and counseling to effectively motivate others. Outstanding administrative and organizational skills. Demonstrated ability to effectively manage multiple priorities. Notes: UCSB Campus Security Authority under Clery Act. Satisfactory criminal history background check. Pay Rate/Range: $30.04 to $38.45/
hr. UC Santa Barbara is an Equal Opportunity/Affirmative Action Employer. All qualified applicants will receive consideration for employment without regard to race, color, religion, sex, sexual orientation, gender identity, national origin, disability, age or protected veteran status. For the University of California’s Affirmative Action Policy, please visit: https:// policy.ucop.edu/doc/4010393/PPSM‑20. For the University of California’s Anti‑Discrimination Policy, please visit: https://policy.ucop.edu/doc/1001004/ Anti‑Discrimination. Open until filled. Apply online at https://jobs.ucsb.edu, Job #75546

RESIDENTIAL AND COMMUNITY LIVING
The Resident Director (RD) is a full‑time, 12‑month, live‑in position with on‑call responsibilities. Under the general supervision of an Assistant Director, the RD utilizes a curricular approach and equity mindset as cornerstones of their daily work – each is a framework by which daily work is achieved. Primary responsibilities include: Implementation of a curricular approach in the development and education of a residential community ranging from 600‑1,800 residents.
The direct supervision, training, and evaluation of 1‑2 full‑time professional staff (Assistant Resident Directors),
and up to 30 paraprofessional student staff. Management of a student conduct and students of concern case load consisting of students living within their community. After‑hours crisis response and scheduled on‑call responsibilities for a neighborhood of 5,000‑6,000 residents and a campus community of 10,000‑11,000 residents. Developing effective working relationships with the 60+ colleagues that make up our R&CL staff. Reqs: Bachelor’s degree in related area and / or equivalent experience / training. Master’s degree or equivalent working experience in Residential Life, Housing, or Student Affairs. Track record of infusing Diversity, Equity, and Inclusion principles into daily work. Ability to work collaboratively with colleagues throughout a large, multifunctional department. Commitment to creating communities where residents feel a deep sense of belonging. Knowledge of and/or experience working within a residential curriculum campus. Notes: The Resident Director (RD) is a full‑time, 12‑month, live‑in position with on‑call responsibilities. Possibility of contract renewal for a maximum of three additional terms. This position may require night and weekend hours as needed. Position also includes a furnished apartment. UCSB Campus Security Authority under Clery Act Satisfactory criminal history background check Exercise the utmost discretion in managing sensitive information learned in the course of performing their duties. Sensitive information includes but is not limited







































ByMattJones


1. Nearly boils, as water
7. “Drugs are bad, ___?”
(“South Park” line)
11. Sea-___ Airport
14. Bruce Springsteen’s “Greetings from ___ Park, N.J.”
15. “Arrested Development” star Michael
16. Unexpected
17. The most fortunate member of the Scooby Gang?
19. Rank under cpl.
20. Last part of “Aida,” e.g.
21. Broadway star McDonald
23. ___ apso (small terrier)
26. Footwear with spikes
29. Meal component?
30. Half a Robert Louis Stevenson title character?
32. “I’ll just pop out for ___ bit ...”
33. What a flag made up of green, white, grey, and black stripes represents
34. Battery terminal, for short
35. Old sitcom’s new chance?
37. Bite-sized Chinese dishes
39. ___-Lytton Fiction Contest
42. Map section
44. Birthplace of Albert Einstein
45. “Much ___ About Nothing”
46. “Free Willy” creature
48. Instructions before weeping?
50. Comedian ___ Lina
51. Completely reliable
53. John on the Mayflower
55. Bit of a giggle
56. Traffic sign verb
58. Prefix meaning “upon”
59. Vegan block for Laura Ingalls Wilder?
65. Hairstyling stuff
66. Shredded
67. Stewed fruits
68. NPR’s Shapiro who hosted the latest season of “The Mole”
69. Booty
70. Quaking trees
1. “Do the Right Thing” pizzeria owner 2. Fort Collins sch. 3. “Doctor Odyssey” network 4. Haas of “Inception” 5. University that doesn’t allow alcohol 6. Pt. of DOS 7. James of “X-Men” movies 8. Ale container 9. Braz. neighbor 10. “Get Yer ___ Out” (Rolling Stones album)
11. Direction to put in laundry, in some machines? 12. Like most paid streaming accounts
13. Music holder in a tower,

to employee and student records, health and patient records, financial data, strategic plans, proprietary information, and any other sensitive or non‑public information learned during the course and scope of employment. Understands that sensitive information should be shared on a limited basis and actively takes steps to limit access to sensitive information to individuals who have legitimate business need to know. Ensure that sensitive information is properly safeguarded. Follow all organizational policies and laws on data protection and privacy. This includes secure handling of physical and digital records and proper usage of IT systems to prevent data leaks. The unauthorized or improper disclosure of confidential work‑related information obtained from any source on any work‑related matter is a violation of these expectations.
Pay Rate/Range: $63,800 ‑ $65,300/ yr. UC Santa Barbara is an Equal Opportunity/Affirmative Action Employer. All qualified applicants will receive consideration for employment without regard to race, color, religion, sex, sexual orientation, gender identity, national origin, disability, age or protected veteran status. For the University of California’s Affirmative Action Policy, please visit: https:// policy.ucop.edu/doc/4010393/PPSM‑20. For the University of California’s Anti‑Discrimination Policy, please visit: https://policy.ucop.edu/doc/1001004/ Anti‑Discrimination. Open until filled. Apply online at https://jobs.ucsb.edu, Job #75471

LIBRARY
Accessions incoming archival collection materials in all formats, creates and establishes processing plans for collections, processes collections, including those containing audiovisual and born‑digital elements, trains and supervises students in the processing of simple collections or portions of collections, creates indexes, container lists, and finding guides. Using the library content management system and other tools, creates EAD finding guides for publication. Maintains and updates collection records in ArchivesSpace and republishes guides as needed. Collaborates with catalogers on cataloging collections and with metadata and digitization staff on collections being digitized. Works with Curators and Department staff on identifying collections for the SRLF transfer. Contributes to both the processing unit’s and the SRC department’s policies, procedures, and the design of productive workflows. Uses independent judgment and works with minimal supervision. Reqs: Bachelor’s Degree or equivalent training and experience. Notes: Schedule may vary. Satisfactory conviction history background check The budgeted hourly range is $29.05 to $34.87/ hr. The full hourly range is $29.05 to $42.92/hr. The University of California is an Equal Opportunity/Affirmative Action Employer, and all qualified applicants will receive consideration for employment without regard to race, color, religion, sex, sexual orientation, gender identity, national origin, disability status, protected veteran status, or any other characteristic protected by law. For more information: https://policy.ucop.edu/doc/4010393/ PPSM‑20, https://policy.ucop.edu/ doc/1001004/Anti‑Discrimination. Open until filled. Apply online at https://jobs. ucsb.edu Job # 75537

Under the general supervision of the Asst. Residence Hall Manager or Residence Hall Manager, performs duties in accordance with established standards and instruction, for University owned Residence Halls, Apartments and Dining Facilities. May be required to perform other duties as assigned to meet the operational needs of the department. Promotes a customer service environment to residence and clients. Assists with the development and maintenance of a work environment which is conducive to meeting the mission of the organization and supports the EEP. Responsible for completing job duties that demonstrates support for the Operations Team. Initiates communication directly with co‑workers and or supervisor to improve and clarify working relationship, identifying problems and concerns, and seeking resolution to work‑related conflicts. Reqs: Working knowledge and experience in utilizing the following equipment: vacuums, conventional and high‑speed buffers, extractors and related custodial equipment desirable. Will train on all equipment and chemicals used. Demonstrated ability to work effectively with others as a team. Must have effective communication skills. Ability to interact as a team member with sensitivity towards a multi‑cultural work environment. Notes: May be required to work other schedules to meet the operational needs of the department. Maintain a valid CA driver’s license, a satisfactory DMV record and enrollment in the DMV Employer Pull‑Notice Program Satisfactory criminal history background check. Pay Rate/Range: $22.66 ‑ $24.51/hr. UC Santa Barbara is an Equal Opportunity/Affirmative Action Employer. All qualified applicants will receive consideration for employment without regard to race, color, religion, sex, sexual orientation, gender identity, national origin, disability, age or protected veteran status. For the University of California’s Affirmative Action Policy, please visit: https:// policy.ucop.edu/doc/4010393/PPSM‑20.
For the University of California’s Anti‑Discrimination Policy, please visit: https://policy.ucop.edu/doc/1001004/ Anti‑Discrimination Open until filled. Apply online at https://jobs.ucsb.edu Job #75208
VOLUNTEERS NEEDED

INTERESTED IN becoming a Walking Tour Docent?
Want to learn about how the 1925 Earthquake affected Santa Barbara as we know it today?
The Architectural Foundation of Santa Barbara is seeking docents to lead our popular weekend Architectural Walking Tours. Training will be provided, and the commitment is approximately one two‑hour tour per month, with a flexible schedule to accommodate all docents.
Join us in sharing and celebrating Santa Barbara’s rich architectural legacy with locals and visitors alike, especially as the the 1925 earthquake nears it’s 100‑year anniversary.
Please contact Lydia at 805.965.6307 or email info@afsb.org to join!
NOTICE OF PETITION TO ADMINISTER
ESTATE OF: MARY MADELINE HANRAHAN, aka MARY MADELINE
DALY No.: 24PR00704
To all heirs, beneficiaries, creditors, contingent creditors, and persons who may otherwise be interested in the will or estate, or both of: MARY MADELINE
HANRAHAN, MARY MADELINE DALY, MADELINE HANRAHAN
A PETITION FOR PROBATE has been filed by: JOHN MICHAEL HANRAHAN in the Superior Court of California, County of Santa Barbara.
THE PETITION requests that (name): JOHN MICHAEL HANRAHAN be appointed as personal representative to administer the estate of the decedent.
THE PETITION requests authority to administer the estate under the Independent Administration of Estates Act. (This authority will allow the personal representative to take many actions without obtaining court approval. Before taking certain very important actions, however, the personal representative will be required to give notice to interested persons unless they have waived notice or consented to the proposed action.) The Independent administration authority will be granted unless an interested person files an objection to the petition and shows good cause why the court should not grant the authority.
A HEARING on the petition will be held in this court as follows: 2/27/2025 AT 9:00 a.m. Dept: 5 SUPERIOR COURT OF CALIFORNIA COUNTY OF SANTA BARBARA, located at 1100 Anacapa Street Santa Barbara, CA 93101. Anacapa Division.
IF YOU OBJECT to the granting of the petition, you should appear at the hearing and state your objections or file written objections with the court before the hearing. Your appearance may be in person or by your attorney.
IF YOU ARE A CREDITOR or a contingent creditor of the decedent, you must file your claim with the court and mail a copy to the personal representative appointed by the court within the later of either (1) four months from the date of first issuance of letters to a general personal representative, as defined in section 58 (b) of the California

Probate Code, or (2) 60 days from the date of mailing or personal delivery to you of a notice under section 9052 of the California Probate Code. Other California statutes and legal authority may affect your rights as a creditor. You may want to consult with an attorney knowledgeable in California law. YOU MAY EXAMINE the file kept by the court. If you are a person interested in the estate, you may file with the court a Request for Special Notice (form DE‑154) of the filing of an inventory and appraisal of estate assets or of any petition or account as provided in Probate Code Section 1250. A Request for Special notice form is available from the court clerk. Darrel E. Parker, Executive Officer 12/12/2024 by Monica Buenrostro, Deputy. Attorney for Petitioner: Self‑represented John Michael Hanrahan; 197 Ryans Ln, Grass Valley, CA 95945; 530‑263‑1933
Published: Jan 9, 16, 23 2025.
NOTICE OF PETITION TO ADMINISTER ESTATE OF: STANLEY A. MATKOWSKI No.: 25PR00008
To all heirs, beneficiaries, creditors, contingent creditors, and persons who may otherwise be interested in the will or estate, or both of: STANLEY A. MATKOWSKI
A PETITION FOR PROBATE has been filed by: MELISSA I. SANTORO in the Superior Court of California, County of Santa Barbara. THE PETITION requests that (name): STANLEY A. MATKOWSKI be appointed as personal representative to administer the estate of the decedent. THE PETITION requests authority to administer the estate under the Independent Administration of Estates Act. (This authority will allow the personal representative to take many actions without obtaining court approval. Before taking certain very important actions, however, the personal representative will be required to give notice to interested persons unless they have waived notice or consented to the proposed action.) The Independent administration authority will be granted unless an interested person files an objection to the petition and shows good cause why the court should not grant the authority.
A HEARING on the petition will be held in this court as follows: 3/13/2025 AT 9:00 a.m. Dept: 5 SUPERIOR COURT OF CALIFORNIA COUNTY OF SANTA BARBARA, located at 1100 Anacapa Street Santa Barbara, CA 93101. Anacapa Division.
IF YOU OBJECT to the granting of the petition, you should appear at the hearing and state your objections or file written objections with the court before the hearing. Your appearance may be in person or by your attorney.
IF YOU ARE A CREDITOR or a contingent creditor of the decedent, you must file your claim with the court and mail a copy to the personal representative appointed by the court within the later of either (1) four months from the date of first issuance of letters to a general personal representative, as defined in section 58 (b) of the California Probate Code, or (2) 60 days from the date of mailing or personal delivery to you of a notice under section 9052 of the California Probate Code. Other California statutes and legal authority may affect your rights as a creditor. You may want to consult with an attorney knowledgeable in California law.
DONATE YOUR Car to Veterans Today! Help and Support our Veterans. Fast ‑ FREE pick up. 100% tax deductible. Call 1‑800‑245‑0398 DONATE YOUR VEHICLE to fund the SEARCH FOR MISSING CHILDREN. FAST FREE PICKUP. 24 hour response. Running or not. Maximum Tax Deduction and No Emission Test Required! Call 24/7: 1‑877‑434‑6852 (Cal‑SCAN) GOT AN UNWANTED CAR??? DONATE IT TO PATRIOTIC HEARTS. Fast free pick up. All 50 States. Patriotic Hearts’ programs help veterans find work or start their own business. Call 24/7: 1‑855‑408‑6546 (Cal‑SCAN)
TIENE UN vehiculo no deseado?
Donelo a Patriotic Hearts! Recogida rápida y gratuita en los 50 estados. Patriotic Hearts ofrece programas para ayudar a los veteranos a encontrar trabajo o iniciar su propio negocio.
Llama ahora: 1‑855‑ 408‑7368 (24/7) (Cal‑SCAN)
Court of California, County of Santa Barbara.
THE PETITION requests that (name): SCOTT SANDER be appointed as personal representative to administer the estate of the decedent.
THE PETITION requests the decedent’s will and codicils, if any, be admitted to probate. The will and any codicils are available for examination in the file kept by the court.
THE PETITION requests authority to administer the estate under the Independent Administration of Estates Act. (This authority will allow the personal representative to take many actions without obtaining court approval. Before taking certain very important actions, however, the personal representative will be required to give notice to interested persons unless they have waived notice or consented to the proposed action.) The Independent administration authority will be granted unless an interested person files an objection to the petition and shows good cause why the court should not grant the authority.
A HEARING on the petition will be held in this court as follows: 3/13/2025 AT 9:00 a.m. Dept: SB 5 SUPERIOR COURT OF CALIFORNIA COUNTY OF SANTA BARBARA, located at 1100 Anacapa Street Santa Barbara, CA 93101. Anacapa Division.
IF YOU OBJECT to the granting of the petition, you should appear at the hearing and state your objections or file written objections with the court before the hearing. Your appearance may be in person or by your attorney.
IF YOU ARE A CREDITOR or a contingent creditor of the decedent, you must file your claim with the court and mail a copy to the personal representative appointed by the court within the later of either (1) four months from the date of first issuance of letters to a general personal representative, as defined in section 58 (b) of the California Probate Code, or (2) 60 days from the date of mailing or personal delivery to you of a notice under section 9052 of the California Probate Code. Other California statutes and legal authority may affect your rights as a creditor. You may want to consult with an attorney knowledgeable in California law. YOU MAY EXAMINE the file kept by the court. If you are a person interested in the estate, you may file with the court a Request for Special Notice (form DE‑154) of the filing of an inventory and appraisal of estate assets or of any petition or account as provided in Probate Code Section 1250. A Request for Special notice form is available from the court clerk. Darrel E. Parker, Executive Officer 1/8/2025 by Monica Buenrostro, Deputy. Attorney for Petitioner: Julianna M. Malis; Santa Barbara Estate Planning 14 W. Valerio Street, Suite A Santa Barbara, CA 93101; 805‑946‑1550
Published: Jan 16, 23, 30 2025.
NOTICE OF PETITION TO ADMINISTER
ESTATE OF: CARLOS ANGEL MAYA No.: 24PR00706
To all heirs, beneficiaries, creditors, contingent creditors, and persons who may otherwise be interested in the will or estate, or both of: CARLOS ANGEL MAYA
A PETITION FOR PROBATE has been filed by: THERESA MARIA MONTOYA in the Superior Court of California, County of Santa Barbara.
YOU MAY EXAMINE the file kept by the court. If you are a person interested in the estate, you may file with the court a Request for Special Notice (form DE‑154) of the filing of an inventory and appraisal of estate assets or of any petition or account as provided in Probate Code Section 1250. A Request for Special notice form is available from the court clerk. Darrel E. Parker, Executive Officer 1/7/2025 by Monica Buenrostro, Deputy. Attorney for Petitioner: Robert B. Locke; 5290 Overpass Rd. Suite 204 Santa Barbara, CA 93111; 805‑683‑1459
Published: Jan 16, 23, 30 2025.
NOTICE OF PETITION TO ADMINISTER
ESTATE OF: MARY ANN JENKINS No.: 25PR00013
To all heirs, beneficiaries, creditors, contingent creditors, and persons who may otherwise be interested in the will or estate, or both of: MARY ANN JENKINS
A PETITION FOR PROBATE has been filed by: SCOTT SANDER in the Superior
Anacapa Division.
IF YOU OBJECT to the granting of the petition, you should appear at the hearing and state your objections or file written objections with the court before the hearing. Your appearance may be in person or by your attorney.
IF YOU ARE A CREDITOR or a contingent creditor of the decedent, you must file your claim with the court and mail a copy to the personal representative appointed by the court within the later of either (1) four months from the date of first issuance of letters to a general personal representative, as defined in section 58 (b) of the California Probate Code, or (2) 60 days from the date of mailing or personal delivery to you of a notice under section 9052 of the California Probate Code. Other California statutes and legal authority may affect your rights as a creditor. You may want to consult with an attorney knowledgeable in California law.
YOU MAY EXAMINE the file kept by the court. If you are a person interested in the estate, you may file with the court a Request for Special Notice (form DE‑154) of the filing of an inventory and appraisal of estate assets or of any petition or account as provided in Probate Code Section 1250. A Request for Special notice form is available from the court clerk. Darrel E. Parker, Executive Officer 12/23/2024 by Rosa Reyes, Deputy. Attorney for Petitioner: Romelia DeDe Soto, Esq. and Dillon Hughes, Esq. SOTO LAW GROUP, APC; 4041 Macarthur Blvd, Suite 200 Newport Beach, CA 92660; 949‑945‑0059 Published: Jan 16, 23, 30 2025.
NOTICE OF PETITION TO ADMINISTER ESTATE OF: MERRY EILEEN BRIDGES No.: 25PR00005
To all heirs, beneficiaries, creditors, contingent creditors, and persons who may otherwise be interested in the will or estate, or both of: MERRY EILEEN BRIDGES
A PETITION FOR PROBATE has been filed by: JENNIFER CUTFORTH in the Superior Court of California, County of Santa Barbara.
THE PETITION requests that (name): JENNIFER CUTFORTH be appointed as personal representative to administer the estate of the decedent.
THE PETITION requests the decedent’s will and codicils, if any, be admitted to probate. The will and any codicils are available for examination in the file kept by the court.
THE PETITION requests authority to administer the estate under the Independent Administration of Estates Act. (This authority will allow the personal representative to take many actions without obtaining court approval. Before taking certain very important actions, however, the personal representative will be required to give notice to interested persons unless they have waived notice or consented to the proposed action.) The Independent administration authority will be granted unless an interested person files an objection to the petition and shows good cause why the court should not grant the authority.
A HEARING on the petition will be held in this court as follows: 3/6/2025 AT 9:00 a.m. Dept: SB5 SUPERIOR COURT OF CALIFORNIA COUNTY OF SANTA BARBARA, located at 1100 Anacapa Street Santa Barbara, CA 93101. Anacapa Division.
THE PETITION requests that (name): THERESA MARIA MONTOYA be appointed as personal representative to administer the estate of the decedent. THE PETITION requests authority to administer the estate under the Independent Administration of Estates Act. (This authority will allow the personal representative to take many actions without obtaining court approval. Before taking certain very important actions, however, the personal representative will be required to give notice to interested persons unless they have waived notice or consented to the proposed action.) The Independent administration authority will be granted unless an interested person files an objection to the petition and shows good cause why the court should not grant the authority.
A HEARING on the petition will be held in this court as follows: 2/27/2025 AT 9:00 a.m. Dept: SB5 SUPERIOR COURT OF CALIFORNIA COUNTY OF SANTA BARBARA, located at 1100 Anacapa Street Santa Barbara, CA 93101.
DE‑154) of the filing of an inventory and appraisal of estate assets or of any petition or account as provided in Probate Code Section 1250. A Request for Special notice form is available from the court clerk. Darrel E. Parker, Executive Officer 1/9/2025 by Monica Buenrostro, Deputy. Attorney for Petitioner: Janet M. O’Neill; O’Neill & Woolpert 1014 Palm Street, San Luis Obispo, CA 93401; 805‑543‑7695 Published: Jan 16, 23, 30 2025.
NOTICE OF PETITION TO ADMINISTER ESTATE OF JAY ARTHUR WETHERALL CASE NO. 24PR00718
To all heirs, beneficiaries, creditors, contingent creditors, and persons who may otherwise be interested in the will or estate, or both, of JAY ARTHUR WETHERALL A PETITION FOR PROBATE has been filed by Eric Jay Wetherall in the Superior Court of California, County of SANTA BARBARA. THE PETITION FOR PROBATE requests that Eric Jay Wetherall be appointed as personal representative to administer the estate of the decedent. THE PETITION requests authority to administer theestate under the Independent Administration of Estates Act. (This authority will allow the personal representative to take many actions without obtaining court approval. Before taking certain very important actions, however, the personal representative will be required to give notice to interested persons unless they have waived notice or consented to the proposed action.) The independent administration authority will be granted unless an interested person files an objection to the petition and shows good cause why the court should not grant the authority.
IF YOU OBJECT to the granting of the petition, you should appear at the hearing and state your objections or file written objections with the court before the hearing. Your appearance may be in person or by your attorney.
IF YOU ARE A CREDITOR or a contingent creditor of the decedent, you must file your claim with the court and mail a copy to the personal representative appointed by the court within the later of either (1) four months from the date of first issuance of letters to a general personal representative, as defined in section 58 (b) of the California Probate Code, or (2) 60 days from the date of mailing or personal delivery to you of a notice under section 9052 of the California Probate Code. Other California statutes and legal authority may affect your rights as a creditor. You may want to consult with an attorney knowledgeable in California law. YOU MAY EXAMINE the file kept by the court. If you are a person interested in the estate, you may file with the court a Request for Special Notice (form
A HEARING on the petition will be held on March 13, 2025 at 9:00 AM in Dept. No. SB5 located at 1100 Anacapa St., Santa Barbara, CA 93101. IF YOU OBJECT to the granting of the petition, you should appear at the hearing and state your objections or file written objections with the court before the hearing. Your appearance may be in person or by your attorney. IF YOU ARE A CREDITOR or a contingent creditor of the decedent, you must file your claim with the court and mail a copy to the personal representative appointed by the court within the later of either (1) four months from the date of first issuance of letters to a general personal representative, as defined in section 58(b) of the California Probate Code, or (2) 60 days from the date of mailing or personal delivery to you of a notice under section 9052 of the California Probate Code. Other California statutes and legal authority may affect your rights as a creditor. You may want to consult with an attorney knowledgeable in California law. YOU MAY EXAMINE the file kept by the court. If you are a person interested in the estate, you may file with the court a Request for Special Notice (form DE‑154) of the filing of an inventory and appraisal of estate assets or of any petition or account as provided in Probate Code section 1250. A Request for Special Notice form is available from the court clerk. Attorney for petitioner: YVETTE VALENCIA ESQ SBN 237055 VALENCIA LAW NOW INC 8141 E 2ND ST STE 625 DOWNEY CA 90241 CN113219 WETHERALL JAN 16,23,30, 2025
NOTICE OF PETITION TO ADMINISTER ESTATE OF: WILSON PATRICK GLEESON No.: 24PR00175 To all heirs, beneficiaries, creditors, contingent creditors, and persons who may otherwise be interested in the will or estate, or both of: WILSON PATRICK GLEESON A PETITION FOR PROBATE has been filed by: PAUL D. GLEESON
personal representative will be required to give notice to interested persons unless they have waived notice or consented to the proposed action.) The Independent administration authority will be granted unless an interested person files an objection to the petition and shows good cause why the court should not grant the authority.
A HEARING on the petition will be held in this court as follows: 2/27/2025 AT 9:00 a.m. Dept: SB 5 SUPERIOR COURT OF CALIFORNIA COUNTY OF SANTA BARBARA, located at 1100 Anacapa Street Santa Barbara, CA 93101. Anacapa Division.
IF YOU OBJECT to the granting of the petition, you should appear at the hearing and state your objections or file written objections with the court before the hearing. Your appearance may be in person or by your attorney.
IF YOU ARE A CREDITOR or a contingent creditor of the decedent, you must file your claim with the court and mail a copy to the personal representative appointed by the court within the later of either (1) four months from the date of first issuance of letters to a general personal representative, as defined in section 58 (b) of the California Probate Code, or (2) 60 days from the date of mailing or personal delivery to you of a notice under section 9052 of the California Probate Code. Other California statutes and legal authority may affect your rights as a creditor. You may want to consult with an attorney knowledgeable in California law.
YOU MAY EXAMINE the file kept by the court. If you are a person interested in the estate, you may file with the court a Request for Special Notice (form DE‑154) of the filing of an inventory and appraisal of estate assets or of any petition or account as provided in Probate Code Section 1250. A Request for Special notice form is available from the court clerk. Darrel E. Parker, Executive Officer 1/7/2025 by Nicolete Barnard, Deputy. Attorney for Petitioner: Adrian S. Andrade; 211 East Fesler Street Santa Maria, CA 93454; 805‑928‑3651 Published: Jan 16, 23, 30 2025.
NOTICE OF PETITION TO ADMINISTER
ESTATE OF: ELAINE M. RYMILLS No.: 25PR00015
To all heirs, beneficiaries, creditors, contingent creditors, and persons who may otherwise be interested in the will or estate, or both of: ELAINE M. RYMILLS, ELAINE MARGARET RYMILLS
A PETITION FOR PROBATE has been filed by: LISA STORRIE‑LOMBARDI in the Superior Court of California, County of Santa Barbara.
THE PETITION requests that (name): LISA STORRIE‑LOMBARDI be appointed as personal representative to administer the estate of the decedent. THE PETITION requests the decedent’s will and codicils, if any, be admitted to probate. The will and any codicils are available for examination in the file kept by the court.
THE PETITION requests authority to administer the estate under the Independent Administration of Estates Act. (This authority will allow the personal representative to take many actions without obtaining court approval. Before taking certain very important actions, however, the personal representative will be required to give notice to interested persons unless they have waived notice or consented to the proposed action.) The Independent administration authority will be granted unless an interested person files an objection to the petition and shows good cause why the court should not grant the authority.
A HEARING on the petition will be held in this court as follows: 03/13/2025 AT 9:00 a.m. Dept: SB5 Room: Zoom (see attached) SUPERIOR COURT OF CALIFORNIA COUNTY OF SANTA BARBARA, located at 1100 Anacapa Street PO Box 21107 Santa Barbara, CA 93101. Anacapa Division.
IF YOU OBJECT to the granting of the petition, you should appear at the hearing and state your objections or file written objections with the court before the hearing. Your appearance may be in person or by your attorney. IF YOU ARE A CREDITOR or a contingent creditor of the decedent, you must file your claim with the court and mail a copy to the personal representative appointed by the court within the later of either (1) four months from the date of first issuance of letters to a general
personal representative, as defined in section 58 (b) of the California Probate Code, or (2) 60 days from the date of mailing or personal delivery to you of a notice under section 9052 of the California Probate Code. Other California statutes and legal authority may affect your rights as a creditor. You may want to consult with an attorney knowledgeable in California law. YOU MAY EXAMINE the file kept by the court. If you are a person interested in the estate, you may file with the court a Request for Special Notice (form DE‑154) of the filing of an inventory and appraisal of estate assets or of any petition or account as provided in Probate Code Section 1250. A Request for Special notice form is available from the court clerk. Darrel E. Parker, Executive Officer 1/9/2025 by Monica Buenrostro, Deputy. Attorney for Petitioner: Colton J. Kerfoot; 112 E. Victoria Street, Santa Barbara, CA 93101; 805‑966‑1501
Published: Jan 16, 23, 30 2025. NOTICE OF PETITION TO ADMINISTER ESTATE OF: HARRY D. CARRUBBA No.: 25PR00011
To all heirs, beneficiaries, creditors, contingent creditors, and persons who may otherwise be interested in the will or estate, or both of: HARRY D. CARRUBBA A PETITION FOR PROBATE has been filed by: ROBERT CARRUBBA, SR. in the Superior Court of California, County of Santa Barbara.
THE PETITION requests that (name): ROBERT CARRUBBA, SR. be appointed as personal representative to administer the estate of the decedent.
THE PETITION requests the decedent’s will and codicils, if any, be admitted to probate. The will and any codicils are available for examination in the file kept by the court.
THE PETITION requests authority to administer the estate under the Independent Administration of Estates Act. (This authority will allow the personal representative to take many actions without obtaining court approval. Before taking certain very important actions, however, the personal representative will be required to give notice to interested persons unless they have waived notice or consented to the proposed action.) The Independent administration authority will be granted unless an interested person files an objection to the petition and shows good cause why the court should not grant the authority.
A HEARING on the petition will be held in this court as follows: 2/26/2025 AT 8:30 a.m. Dept: SM1 SUPERIOR COURT OF CALIFORNIA COUNTY OF SANTA BARBARA, located at 312 East Cook Street, Building E Santa Maria, CA 93453. COOK DIVISION.
IF YOU OBJECT to the granting of the petition, you should appear at the hearing and state your objections or file written objections with the court before the hearing. Your appearance may be in person or by your attorney.
IF YOU ARE A CREDITOR or a contingent creditor of the decedent, you must file your claim with the court and mail a copy to the personal representative appointed by the court within the later of either (1) four months from the date of first issuance of letters to a general personal representative, as defined in section 58 (b) of the California Probate Code, or (2) 60 days from the date of mailing or personal delivery to you of a notice under section 9052 of the California Probate Code. Other California statutes and legal authority may affect your rights as a creditor. You may want to consult with an attorney knowledgeable in California law. YOU MAY EXAMINE the file kept by the court. If you are a person interested in the estate, you may file with the court a Request for Special Notice (form DE‑154) of the filing of an inventory and appraisal of estate assets or of any petition or account as provided in Probate Code Section 1250. A Request for Special notice form is available from the court clerk. Darrel E. Parker, Executive Officer 1/8/2025 by Blanca Delabra, Deputy. Attorney for Petitioner: Brighton K. Hushing‑Kline; Hushing Law P.O. Box 1980, Atascadero, CA 93423; 805‑466‑6644
Published: Jan 16, 23, 30 2025.
NOTICE OF PETITION TO ADMINISTER ESTATE OF: RODNEY DRAPER No.: 24PR00683
To all heirs, beneficiaries, creditors, contingent creditors, and persons who may otherwise be interested in the will or estate, or both of: RODNEY DRAPER
A PETITION FOR PROBATE has been filed by: HARRY E. HAGEN, SANTA BARBARA COUNTY PUBLIC ADMINISTRATOR in the Superior Court of California, County of Santa Barbara.
THE PETITION requests that (name): HARRY E. HAGEN, SANTA BARBARA COUNTY PUBLIC ADMINISTRATOR be appointed as personal representative to administer the estate of the decedent.
THE PETITION requests authority to administer the estate under the Independent Administration of Estates Act. (This authority will allow the personal representative to take many actions without obtaining court approval. Before taking certain very important actions, however, the personal representative will be required to give notice to interested persons unless they have waived notice or consented to the proposed action.) The Independent administration authority will be granted unless an interested person files an objection to the petition and shows good cause why the court should not grant the authority.
A HEARING on the petition will be held in this court as follows: 2/20/2025 AT 9:00 a.m. Dept: 5 SUPERIOR COURT OF CALIFORNIA COUNTY OF SANTA BARBARA, located at 1100 Anacapa Street Santa Barbara, CA 93101. Anacapa Division.
IF YOU OBJECT to the granting of the petition, you should appear at the hearing and state your objections or file written objections with the court before the hearing. Your appearance may be in person or by your attorney.
IF YOU ARE A CREDITOR or a contingent creditor of the decedent, you must file your claim with the court and mail a copy to the personal representative appointed by the court within the later of either (1) four months from the date of first issuance of letters to a general personal representative, as defined in section 58 (b) of the California Probate Code, or (2) 60 days from the date of mailing or personal delivery to you of a notice under section 9052 of the California Probate Code. Other California statutes and legal authority may affect your rights as a creditor. You may want to consult with an attorney knowledgeable in California law.
YOU MAY EXAMINE the file kept by the court. If you are a person interested in the estate, you may file with the court a Request for Special Notice (form DE‑154) of the filing of an inventory and appraisal of estate assets or of any petition or account as provided in Probate Code Section 1250. A Request for Special notice form is available from the court clerk. Darrel E. Parker, Executive Officer 12/9/2024 by Nicole Barnard, Deputy. Attorney for Petitioner: Mike Munoz, Senior Deputy County Counsel; 105 E. Anapamu Street, #201, Santa Barbara, CA 93101; 805‑568‑2950 Published: Jan 16, 23, 30 2025.
FBN ABANDONMENT
STATEMENT OF ABANDONMENT OF USE OF FICTITIOUS BUSINESS NAME
The following Fictitious Business Name is being abandoned: RINCON EVENTS, EVENTS BY RINCON, RINCON BEACH CLUB, RNCON BEACH CLUB & CATERING, ZOO CATERING SERVICES BY RINCON: 3805 Santa Claus Ln Carpinteria, CA 93013 The original statement for use of this Fictitious Business Name was filed 06/26/2020 in the County of Santa Barbara. Original File no. FBN 2020‑0001590. The persons or entities abandoning use of this name are as follows: Rincon Catering Inc. (same address) The business was conducted by an A Trust. Registrant commenced to tranact business under the fictitious business name or names listed above on Jun 19, 2020 Signed by: MARC BOROWITZ/PRESIDENT Filed with the County Clerk of Santa Barbara County on 1/3/25, FBN 2025‑0000025 E57. I hereby certify that this is a correct copy of the original statement on file in the Office of the County Clerk, Joseph E. Holland, County Clerk (SEAL). Published: Jan 9, 16, 23, 30 2025.
STATEMENT OF ABANDONMENT OF USE OF FICTITIOUS BUSINESS NAME The following Fictitious Business Name is being abandoned: SAFEGUARD ROOFING: 725 E Mason
St Santa Barbara, CA 93103 The original statement for use of this Fictitious Business Name was filed 03/5/2024 in the County of Santa Barbara. Original File no. FBN 2024‑0000562. The persons or entities abandoning use of this name are as follows: Gail L Lobdell 1201 Diana Rd Santa Barbara, CA 93103 The business was conducted by an A Trust. Registrant commenced to tranact business under the fictitious business name or names listed above on Mar 5, 2024 Signed by: GAIL L. LOBDELL/ TRUSTEE OF THE LOBDELL FAMILY TRUST Filed with the County Clerk of Santa Barbara County on 12/23/24, FBN 2024‑0002989, E57. I hereby
certify that this is a correct copy of the original statement on file in the Office of the County Clerk, Joseph E. Holland, County Clerk (SEAL). Published: Jan 9, 16, 23, 30 2025.
STATEMENT OF ABANDONMENT OF USE OF FICTITIOUS BUSINESS NAME The following Fictitious Business Name is being abandoned: GLASS LAKE CONSULTING LLC: 6598 Sand Castle Pl Goleta, CA 93117 The original statement for use of this Fictitious Business Name was filed 11/6/2024 in the County of Santa Barbara. Original File no. FBN 2024‑0002626. The persons or entities abandoning use of this name are as
follows: Glass Lake Consulting (same address) The business was conducted by an Limited Liability Company. Registrant commenced to tranact business under the fictitious business name or names listed above on Oct 24, 2024 Signed by: RICHARD BALLEW/ PRESIDENT Filed with the County Clerk of Santa Barbara County on 12/26/24, FBN 2024‑0003007, E30. I hereby certify that this is a correct copy of the original statement on file in the Office of the County Clerk, Joseph E. Holland, County Clerk (SEAL). Published: Jan 9, 16, 23, 30 2025. STATEMENT OF ABANDONMENT OF
OF FICTITIOUS
The following Fictitious Business Name is being abandoned: ANGELS LANDING FARM LLC: 2484 Roblar Avenue Los Olivos, CA 93441 The original statement for use of this Fictitious
SANTA BARBARA COUNTY, CA HAS BEEN AWARDED FEDERAL FUNDS MADE AVAILABLE THROUGH THE DEPARTMENT OF HOMELAND SECURITY (DHS)/FEDERAL EMERGENCY MANAGEMENT AGENCY UNDER THE EMERGENCY FOOD AND SHELTER NATIONAL BOARD PROGRAM.
SANTA BARBARA COUNTY, CA has been chosen to receive $181,385 in Phase 42 funding to supplement emergency food and shelter programs in the county.
The selection was made by a National Board that is chaired by the U. S. Department of Homeland security’s Federal Emergency Management Agency and consists of representatives from American Red Cross; Catholic Charities, USA; National Council of the Churches of Christ in the USA; The Jewish Federations of North America, The Salvation Army; and United Way Worldwide. The Local Board is charged to distribute funds appropriated by Congress to help expand the capacity of food and shelter programs in high-need areas around the country.
A Local Board made up of United Way of Santa Barbara County, Catholic Charities, American Red Cross, Salvation Army, Foodbank of Santa Barbara County, Jewish Federation, All Saints by the Sea, and United Way of Northern Santa Barbara County will determine how the funds awarded to SANTA BARBARA COUNTY, CA are to be distributed among the emergency food and shelter programs run by local service agencies in the area. The Local Board is responsible for recommending agencies to receive these funds and any additional funds made available under this phase of the program.
Under the terms of the grant from the National Board, local agencies chosen to receive funds must: 1) be private voluntary non-profits or units of government, 2) be eligible to receive Federal funds, 3) have an accounting system, 4) practice nondiscrimination, 5) have demonstrated the capability to deliver emergency food and/or shelter programs, and 6) if they are a private voluntary organization, have a voluntary board. Qualifying agencies are urged to apply.
SANTA BARBARA COUNTY, CA has distributed Emergency Food and Shelter funds previously with Catholic Charities, Good Samaritan Shelter, Foodbank of Santa Barbara County, Salvation Army, PATH, Jewish Federation of Greater Santa Barbara, and Transition House.
Public or private voluntary agencies interested in applying for Emergency Food and Shelter Program funds must contact Raquel Sanchez, United Way of Santa Barbara County, rsanchez@unitedwaysb.org for an application. The deadline for applications to be received is Friday January 31, 2025.
Notice is hereby given that the Santa Barbara Unified School District will receive proposals from prequalified firms for Preconstruction and Lease-Leaseback Services for the Dos Pueblos High School CTE Pavilion Repair Project (“Project”).
Contractor’s License Required: B, General Building Contractor. Submittal Deadline: Proposals must be received by February 21, 2025, by 2:00 p.m. at the office of Santa Barbara Unified School District, 724 Santa Barbara Street, Santa Barbara, CA 93101, Attention: Marina Verdian
Anticipated Start of Construction: Spring 2025
Prequalification: All firms submitting a proposal to this RFP must be prequalified with the District pursuant to Public Contract Code section 20111.6 (b)-(m) without exception prior to submitting a proposal.
Prequalification documents must be submitted by February 11, 2025. Pursuant to Public Contract Code section 20111.6(j) a list of prequalified general contractors and electrical, mechanical, and plumbing subcontractors will be made available by the District no later than five business days before the proposal opening at the Santa Barbara Unified School District, Planning Dept., 724 Santa Barbara St., Santa Barbara, CA 93101. Prequalification packages are available through Cybercopy at http://www.cybercopyplanroom.com. Pre-qualification questions must be directed to L.M. Sweaney at Lindasweaney@gmail.com or leave a voice message at (909) 337-8302. Prequalification packages must be submitted to L.M. Sweaney & Associates, P. O. Box 3187 Santa Barbara, CA 93130 no later than the date specified herein by US MAIL ONLY. Faxed or Emailed Applications will not be accepted.
Prevailing Wages: Pursuant to the provisions of Section 1773 and 1773.2 of the Labor Code of the State of California, the District has obtained from the Director of Industrial Relations (“DIR”), the general prevailing rate of per diem wages and the general prevailing rate for holiday and overtime work in the locality in which the work is to be performed for each craft, classification or type of workman needed to execute the contract which is available for review at http://www.dir.ca.gov/dlsr/statistics_research.html. During the Work, the DIR will monitor compliance with prevailing wage rate requirements and enforce the Contractor’s prevailing wage rate obligations, with a copy of the same being on file with the clerk of the District’s governing board. It shall be mandatory upon the contractor to whom the contract is awarded, and upon any subcontractor under him, to pay not less than the said specified rates to all workmen employed by them in the execution of the contract, and to comply with all prevailing wage requirements set forth in the Labor Code.
DIR Registration/Monitoring: Pursuant to the provisions of Section 1771.1 of the Labor Code of the State of California, a contractor or subcontractor shall not be qualified to bid or engage in the performance of any contract for this project unless; (1) currently registered and qualified to perform public work pursuant to Section 1725.5; or (2) expressly authorized to submit a bid by Section 1771.1 and provided the contractor is registered to perform public work pursuant to section 1725.5 at the time the contract is awarded. This project is subject to compliance monitoring and enforcement by the DIR. The successful Bidder will be required to post all job-site notices required by DIR regulations and other applicable law.
Project and Submittal Information: The full scope of work for the Project, prequalification information, and the required submittal information is further set forth in the Request for
Proposals (the “RFP”) available on the District’s website at www.sbunified.org or via email request to Marina Verdian at mverdian@sbunified.org
As further described in the RFP, the successful proposal will be that which offers the best value to the District, as determined pursuant to the criteria and evaluation process set forth in the RFP. Following its selection of the successful Responder, the District will notify all Responders of its intent to award a contract.
If the District is unable to successfully negotiate a LLB Contract with the successful Responder which is satisfactory to the District, or if the selected proposer refuses or fails to execute the tendered contract, the District may award the contract to the proposer with the second highest best value score, if deemed in the best interest of the District. If that proposer then refuses or fails to execute the tendered contract, the Board may award the contract to the proposer with the third highest best value score, and so on.
MEMBER Filed with the County Clerk of Santa Barbara County on 1/9/25, FBN 2025‑0000081, E30. I hereby
certify that this is a correct copy of the original statement on file in the Office of the County Clerk, Joseph E. Holland, County Clerk (SEAL). Published: Jan 16, 23, 30. Feb 5 2025.
STATEMENT OF ABANDONMENT OF USE OF FICTITIOUS BUSINESS NAME
The following Fictitious Business Name is being abandoned: PATRICIA’S
HAIR FASHIONS: 1922 De La Vina St Santa Barbara, CA 93101 The original statement for use of this Fictitious Business Name was filed 02/13/2023 in the County of Santa Barbara. Original File no. FBN 2023‑0000391. The persons or entities abandoning use of this name are as follows: Sandra Aguilar 28 N Alisos St Unit A Santa Barbara, CA 93101 The business was conducted by an A Individual. Registrant commenced to tranact business under the fictitious business name or names listed above on May 12, 2003 Signed by: SANDRA AGUILAR/INDIVIDUAL Filed with the County Clerk of Santa Barbara County on 1/13/25, FBN 2025‑0000101, E40.
I hereby certify that this is a correct copy of the original statement on file in the Office of the County Clerk, Joseph E. Holland, County Clerk (SEAL). Published: Jan 23 30. Feb 5, 13 2025.
FICTITIOUS BUSINESS NAME STATEMENT
FICTITIOUS BUSINESS NAME STATEMENT The following person(s) is/ are doing business as: SANTA BARBARA SCOTTISH COUNTRY DANCE CLASSES: 2285 Las Positas Road Santa Barbara, CA 93105; Rachel L McDonald 945 Ward Dr Spc 11 Santa Barbara, CA 93111 This business is conducted by A Individual Registrant commenced to transact business under the fictitious business name or names listed above on N/A. Filed by: RACHEL L MCDONALD with the County Clerk of Santa Barbara County on Dec 31, 2024. This statement expires five years from the date it was filed in the Office of the County Clerk.

Joseph E. Holland, County Clerk (SEAL) by E30. FBN Number: 2024‑0003027. Published: Jan 9, 16, 23, 30 2025.
FICTITIOUS BUSINESS NAME STATEMENT The following person(s) is/are doing business as: MAD DOGS LUNAR PRODUCTIONS: 64 Rip Curl Place Goleta, CA 93117; Michael D Lampkin PO Box 90757 Goleta, CA 93117 This business is conducted by A Individual Registrant commenced to transact business under the fictitious business name or names listed above on N/A. Filed by: MICHAEL LAMPKIN with the County Clerk of Santa Barbara County on Dec 19, 2024. This statement expires five years from the date it was filed in the Office of the County Clerk. Joseph E. Holland, County Clerk (SEAL) by E49. FBN Number: 2024‑0002968. Published: Jan 16, 23, 30. Feb 5 2025.
FICTITIOUS BUSINESS NAME STATEMENT The following person(s) is/are doing business as: MISSION POOL AND SPA SERVICES: 103 Vereda Cordillera Goleta, CA 93117; Conner R Lee (same address) This business is conducted by A Individual Registrant commenced to transact business under the fictitious business name or names listed above on Jan 1, 2025. Filed by: CONNER LEE/OWNER with the County Clerk of Santa Barbara County on Jan 6, 2025. This statement expires five years from the date it was filed in the Office of the County Clerk. Joseph E. Holland, County Clerk (SEAL) by E63. FBN Number: 2025‑0000034. Published: Jan 9, 16, 23, 30 2025.
FICTITIOUS BUSINESS NAME STATEMENT The following person(s) is/ are doing business as: GALASET: 782 Acacia Walk Apt H Goleta, CA 93117; Xiaoling Lin (same address) This business is conducted by A Individual Registrant commenced to transact business under the fictitious business name or names listed above on Dec 17, 2024. Filed by: XIAOLING LIN with the County Clerk of Santa Barbara County on Dec 18, 2024. This statement expires five years from the date it was filed in the Office of the County Clerk. Joseph E. Holland, County Clerk (SEAL) by E66. FBN Number: 2024‑0002963.
Published: Jan 9, 16, 23, 30 2025.
FICTITIOUS BUSINESS NAME
STATEMENT The following person(s) is/ are doing business as: SANTA BARBARA
AMATEUR RADIO CLUB: 2707 State
Street Santa Barbara, CA 93105; Santa Barbara Wireless Foundation P.O. Box 3907 Santa Barbara, CA 93130 This business is conducted by A Corporation Registrant commenced to transact business under the fictitious business name or names listed above on Dec 13, 2024. Filed by: DOROTHY OKSNER/ TREASURER with the County Clerk of Santa Barbara County on Dec 17, 2024. This statement expires five years from the date it was filed in the Office of the County Clerk. Joseph E. Holland, County Clerk (SEAL) by E30. FBN Number: 2024‑0002951. Published: Jan 9, 16, 23, 30 2025.
FICTITIOUS BUSINESS NAME
STATEMENT The following person(s) is/ are doing business as: LOCAL GARAGE
DOOR REPAIR: 132 Juana Maria Ave Santa Barbara, CA 93103; Local Garage Door Repair, Inc 8265 W. Sunset Blvd Unit #100 West Hollywood, CA 90046
This business is conducted by A Corporation Registrant commenced to transact business under the fictitious business name or names listed above on N/A. Filed by: DANNY ATAR/CEO with the County Clerk of Santa Barbara County on Dec 20, 2024. This statement expires five years from the date it was filed in the Office of the County Clerk. Joseph E. Holland, County Clerk (SEAL) by E30. FBN Number: 2024‑0002984. Published: Jan 9, 16, 23, 30 2025.
FICTITIOUS BUSINESS NAME
STATEMENT The following person(s) is/ are doing business as: PRECIS SPIRTS: 1503 La Coronilla Dr Santa Barbara, CA 93109; Swebev, Inc. (same address)
This business is conducted by A Corporation Registrant commenced to transact business under the fictitious business name or names listed above on Oct 1, 2024. Filed by: ANDERS
RUNDCRANTZ/CEO with the County Clerk of Santa Barbara County on Dec 12, 2024. This statement expires five years from the date it was filed in the Office of the County Clerk. Joseph
E. Holland, County Clerk (SEAL) by E57. FBN Number: 2024‑0002908. Published: Jan 9, 16, 23, 30 2025.
FICTITIOUS BUSINESS NAME
STATEMENT The following person(s) is/are doing business as: SANTA BARBARA STONE MASTERS, YOUR HOME MASTERS: 5511 Ek11 St. Suite D Santa Barbara, CA 93111; Master Clean USA (same address) This business is conducted by A Corporation Registrant commenced to transact business under the fictitious business name or names listed above on Feb 21, 2020. Filed by: GUDALUPE SOLIS/OPERATIONS MANAGER with the County Clerk of Santa Barbara County on Dec 18, 2024. This statement expires five years from the date it was filed in the Office of the County Clerk. Joseph E. Holland, County Clerk (SEAL) by E30. FBN Number: 2024‑0002961. Published: Jan 9, 16, 23, 30 2025.
FICTITIOUS BUSINESS NAME
STATEMENT The following person(s) is/are doing business as: JORDAN’S ORGANIC GARDENING: 3615 Santa Maria Lane Santa Barbara, CA 93105; Jordan W Brewer (same address) This business is conducted by A Individual Registrant commenced to transact business under the fictitious business name or names listed above on Dec 2, 2024. Filed by: JORDAN WILLIAM BREWER with the County Clerk of Santa Barbara County on Dec 27, 2024. This statement expires five years from the date it was filed in the Office of the County Clerk. Joseph E. Holland, County Clerk (SEAL) by E30. FBN Number: 2024‑0003012. Published: Jan 9, 16, 23, 30 2025.
FICTITIOUS BUSINESS NAME
STATEMENT The following person(s) is/ are doing business as: LJ GUTTERS: 2037 Oak Ave Apt B Santa Barbara, CA 93101; Eduard J Caceres Chacon (same address) This business is conducted by A Individual Registrant commenced to transact business under the fictitious business name or names listed above on Dec 26, 2024. Filed by: EDUARD CACERES CHACON/OWNER with the County Clerk of Santa Barbara County on Dec 26, 2024. This statement expires
LOCAL BUILDING LAWS - EV REACH CODE
five years from the date it was filed in the Office of the County Clerk. Joseph E. Holland, County Clerk (SEAL) by E49. FBN Number: 2024‑0003011. Published: Jan 9, 16, 23, 30 2025.
FICTITIOUS BUSINESS NAME
STATEMENT The following person(s) is/ are doing business as: SOLVANG BOOK COMPANY: 305 North Z Street Lompoc, CA 93436; Edwin P Gregory (same address) This business is conducted by A Individual Registrant commenced to transact business under the fictitious business name or names listed above on Sep 1, 1995. Filed by: EDWIN P GREGORY with the County Clerk of Santa Barbara County on Dec 31, 2024. This statement expires five years from the date it was filed in the Office of the County Clerk. Joseph E. Holland, County Clerk (SEAL) by E30. FBN Number: 2024‑0003033. Published: Jan 9, 16, 23, 30 2025.
FICTITIOUS BUSINESS NAME STATEMENT The following person(s) is/ are doing business as: SHARP TAX: 303 Mesa Lane Santa Barbara, CA 93109; The Sharp Company LLC PO Box 512 Bodega Bay, CA 94923 This business is conducted by A Limited Liability Company Registrant commenced to transact business under the fictitious business name or names listed above on Jan 1, 2025. Filed by: JEREMY SHARP/OWNER with the County Clerk of Santa Barbara County on Jan 2, 2025. This statement expires five years from the date it was filed in the Office of the County Clerk. Joseph E. Holland, County Clerk (SEAL) by E30. FBN Number: 2025‑0000007. Published: Jan 9, 16, 23, 30 2025.
FICTITIOUS BUSINESS NAME STATEMENT The following person(s) is/are doing business as: UNDER OAK PROPERTIES: 5350 Overpass Rd Goleta, CA 93111; Anthony C Kurtz 126 Morada Ln Santa Barbara, CA 93105; Lisanne J Kurtz (same address) This business is conducted by A Married Couple Registrant commenced to transact business under the fictitious business name or names listed above on Jan 1, 2025. Filed by: ANTHONY KURTZ/PARTNER with the County Clerk
of Santa Barbara County on Jan 3, 2025. This statement expires five years from the date it was filed in the Office of the County Clerk. Joseph E. Holland, County Clerk (SEAL) by E66. FBN Number: 2025‑0000017. Published: Jan 9, 16, 23, 30 2025.
FICTITIOUS BUSINESS NAME STATEMENT The following person(s) is/are doing business as: VOICES: 47 Dearborn Place Apt 24 Goleta, CA 93117; Viviana L Marsano (same address) This business is conducted by A Corporation Registrant commenced to transact business under the fictitious business name or names listed above on Mar 28, 2003. Filed by: VIVIANA MARSANO/ OWNER with the County Clerk of Santa Barbara County on Jan 2, 2025. This statement expires five years from the date it was filed in the Office of the County Clerk. Joseph E. Holland, County Clerk (SEAL) by E28. FBN Number: 2025‑0000004. Published: Jan 9, 16, 23, 30 2025.
FICTITIOUS BUSINESS NAME STATEMENT The following person(s) is/ are doing business as: ORKIN CENTRAL COAST: 2369 A Street Santa Maria, CA 93455; A.E.T. Services, Inc (same address) This business is conducted by A Corporation Registrant commenced to transact business under the fictitious business name or names listed above on Jul 5, 2012. Filed by: KRISTA MAHAN/TREASURER with the County Clerk of Santa Barbara County on Jan 3, 2025. This statement expires five years from the date it was filed in the Office of the County Clerk. Joseph E. Holland, County Clerk (SEAL) by E30. FBN Number: 2025‑0000027. Published: Jan 9, 16, 23, 30 2025.
FICTITIOUS BUSINESS NAME STATEMENT The following person(s) is/are doing business as: RECLAMARE PRODUCTIONS: 1201 Alta Vista Rd 306 Santa Barbara, CA 93113; Jessie M Rand PO Box 134 Santa Barbara, CA 93102 This business is conducted by A Individual Registrant commenced to transact business under the fictitious business name or names listed above on Nov 9, 2024. Filed by: JESSIE RAND/OWNER with the County Clerk of Santa Barbara County on Dec 12, 2024. This statement expires five years from the date it was filed in the Office of the County Clerk. Joseph E. Holland, County Clerk (SEAL) by E30. FBN Number: 2024‑0002880. Published: Jan 9, 16, 23, 30 2025.
NOTICE OF PUBLIC HEARING CITY COUNCIL Hybrid Public Hearing – In Person and via Zoom February 4, 2025, at 5:30 P.M.
ATTENTION: The meeting will be held in person and via the Zoom platform. The public may also view the meeting on Goleta Channel 19 and/or online at https://cityofgoleta.org/goletameetings
NOTICE IS HEREBY GIVEN that the City Council will hold a public hearing to conduct the second reading of the following ordinance in accordance with Government Code Section 50022.3:
An Ordinance of the City Council of the City of Goleta, California, Amending Title 15, Chapter 15.12 (Green Building) of the Goleta Municipal Code Exempting Hospitals from the Electric Vehicle Reach Code and Finding the Amendment to be Exempt from the California Environmental Quality Act. The date, time, and location of the City Council public hearing are set forth below. The agenda for the hearing will also be posted on the City website (www.cityofgoleta.org).
PUBLIC HEARING INFORMATION:
HEARING DATE/TIME: Tuesday, February 4, 2025, at 5:30 PM
LOCATION: Goleta City Hall, 130 Cremona Drive, Goleta, CA, 93117 and Teleconference Meeting; this meeting will be held in person and via Zoom (with detailed instructions for participation included on the posted agenda)
PROJECT DESCRIPTION:
The proposed ordinance amendment would exempt alterations to hospitals in the Hospital Overlay Zone designated in the Goleta Municipal Code (GMC) from the requirements of the City’s electric vehicle (EV) Reach Code (GMC Chapter 15.12). The Hospital Overlay Zone is the only area within the City where there is an existing hospital.
PUBLIC COMMENT: Interested persons are encouraged to provide public comments during the public hearing in person or virtually through the Zoom webinar, by following the instructions listed on the City Council meeting agenda. Written comments may be submitted prior to the hearing by e-mailing the City Clerk at CityClerkgroup@cityofgoleta.org. Written comments will be distributed to Council and published on the City’s Meeting and Agenda page.
FOR PROJECT INFORMATION: For further information on the project, contact Sustainability Manager Dana Murray at 805-961-7547 or dmurray@cityofgoleta.org or sustainability@cityofgoleta.org. For inquiries in Spanish, please contact Marcos Martinez at (805) 562-5500 or mmartinez@cityofgoleta.org. Staff reports and documents will be posted approximately 72 hours before the hearing on the City’s website at www.cityofgoleta.org
NOTE: If you challenge the nature of the above action in court, you may be limited to only those issues you or someone else raised at the public hearing described in this notice or in written correspondence delivered to the City on or before the date of the hearing (Government Code Section 65009(b)(2)).
NOTE: In compliance with the Americans with Disabilities Act, if you need assistance to participate in the hearing, please contact the City Clerk’s Office at (805) 961-7505 or cityclerkgroup@cityofgoleta.org. Notification at least 48 hours prior to the hearing will enable City staff to make reasonable arrangements.
Publish Date: Santa Barbara Independent January 23, 2025, and January 30, 2025
FICTITIOUS BUSINESS NAME STATEMENT The following person(s) is/are doing business as: GALLAGHER PROPERTY MANAGEMENT: 5266 Hollister Ave, 113 Santa Barbara, CA 93111; Christine A Gallagher (same address) This business is conducted by A Individual Registrant commenced to transact business under the fictitious business name or names listed above on Jan 1, 1998. Filed by: CHRISTINE GALLAGHER/OWNER/BROKER with the County Clerk of Santa Barbara County on Jan 6, 2025. This statement expires five years from the date it was filed in the Office of the County Clerk. Joseph E. Holland, County Clerk (SEAL) by E49. FBN Number: 2025‑0000031. Published: Jan 9, 16, 23, 30 2025. FICTITIOUS BUSINESS NAME STATEMENT FILE NO. FBN2024‑0002938 The following person(s) is (are) doing business as: SANTA BARBARA SOAP COMPANY, 70 PEPPERWOOD WAY, SOLVANG, CA 93463 County of SANTA BARBARA LUCCA CLIFTON, 3210 GLENGARY RD, SANTA YNEZ, CA 93460 ALBERTO BATTAGLINI, 2716 GRAND AVE, LOS OLIVOS, CA 93441
This business is conducted by a General Partnership The registrant(s) commenced to transact business under the fictitious business name or names listed above on N/A. S/ LUCCA CLIFTON, This statement was filed with the County Clerk of Santa Barbara County on 12/16/2024. Joseph E. Holland, County Clerk 1/9, 1/16, 1/23, 1/30/25 CNS‑3883746# SANTA BARBARA INDEPENDENT
FICTITIOUS BUSINESS NAME
STATEMENT The following person(s) is/ are doing business as: CHELIA CAB: 45 Dearborn Pl., 38 Goleta, CA 93117; Haroun Arrif (same address) This business is conducted by A Individual Registrant commenced to transact business under the fictitious business name or names listed above on N/A. Filed by: HAROUN ARRIF/OWNER with the County Clerk of Santa Barbara County on Jan 8, 2025. This statement expires five years from the date it was filed in the Office of the County Clerk. Joseph E. Holland, County Clerk (SEAL) by E63. FBN Number: 2025‑0000065. Published: Jan 16, 23, 30. Feb 5 2025. FICTITIOUS BUSINESS NAME STATEMENT The following person(s) is/are doing business as: THE RACK: 611 Coronel Place Santa Barbara, CA 93101; Punky Pie LLC (same address) This business is conducted by A Limited Liability Company Registrant commenced to transact business under the fictitious business name or names listed above on Jun 8, 2025. Filed by: MEAGAN SOLOFF/OWNER with the County Clerk of Santa Barbara County on Jan 13, 2025. This statement expires five years from the date it was filed in the Office of the County Clerk. Joseph E. Holland, County Clerk (SEAL) by E66. FBN Number: 2025‑0000099. Published: Jan 16, 23, 30. Feb 5 2025.
FICTITIOUS BUSINESS NAME STATEMENT The following person(s) is/are doing business as: TACOS EL GUERO: 1015 Hutash #2 Santa Barbara, CA 93103; Pedro Jacinto Hernandez (same address) This business is conducted by A Individual Registrant commenced to transact business under the fictitious
The following person(s) is doing business as:
MCCALL, 910 HUSTON ST. GROVER BEACH, CA 93433, County of SAN LUIS OBISPO. MESA ENERGY SYSTEMS, INC., 2 CROMWELL IRVINE, CA 92618, CA
This business is conducted by A CORPORATION.
The registrant commenced to transact business under the fictitious business name or names listed above on SEP 16, 2024
/s/ THOMAS HIEBERT, VICE PRESIDENT
This statement was filed with the County Clerk of Santa Barbara County on 12/13/2024.
Joseph E. Holland, County Clerk 1/16, 1/23, 1/30, 2/5/25
CNS‑3884072# SANTA BARBARA
INDEPENDENT
FICTITIOUS BUSINESS NAME
STATEMENT The following person(s) is/are doing business as: NOMAD
VILLAGE: 4326 Calle Real Santa Barbara, CA 93110; Nomad Village MHP 101, LLC 500 Giuseppe Court Suite 2 Roseville, CA 95678; KW Nomad Village MHP LLC (same address) This business is conducted by An Unincorporated Assoc. Other Than a Partnership Registrant commenced to transact business under the fictitious business name or names listed above on Aug 1, 2008. Filed by: KENNETH
WATERHOUSE/MANAGING MEMBER
with the County Clerk of Santa Barbara County on Jan 7, 2025. This statement expires five years from the date it was filed in the Office of the County Clerk. Joseph E. Holland, County Clerk (SEAL) by E71. FBN Number: 2025‑0000045. Published: Jan 16, 23, 30. Feb 5 2025.
FICTITIOUS BUSINESS NAME
STATEMENT
FILE NO. FBN 2024‑0002893
The following person(s) is doing business as:
MCCALL & M/M, 910 HUSTON ST. GROVER BEACH, CA 93433, County of SAN LUIS OBISPO.
MESA ENERGY SYSTEMS, INC., 2 CROMWILL IRVINE, CA 92618, CA
This business is conducted by A CORPORATION.
The registrant commenced to transact business under the fictitious business name or names listed above on SEP 16, 2024 /s/ THOMAS HIEBERT, VICE PRESIDENT
This statement was filed with the County Clerk of Santa Barbara County on 12/11/2024.
Joseph E. Holland, County Clerk 1/16, 1/23, 1/30, 2/5/25
CNS‑3884071# SANTA BARBARA
INDEPENDENT
FICTITIOUS BUSINESS NAME
STATEMENT
FILE NO. 2024‑0002975
The following person(s) is (are) doing business as:
TOUCH OF HEAVEN MASSAGE, 827 STATE ST STE 5, SANTA BARBARA, CA 93101 County of SANTA BARBARA Mailing Address: 827 STATE ST STE 5, SANTA BARBARA, CA 93101
FLAMING DRAGON INC, 827 STATE ST STE 5, SANTA BARBARA, CA 93101
This business is conducted by a Corporation
The registrant(s) commenced to transact business under the fictitious business name or names listed above on 12/19/2024.
FLAMING DRAGON INC
S/ JUNRU WANG, CEO
This statement was filed with the County Clerk of Santa Barbara County on 12/19/2024.
Joseph E. Holland, County Clerk
1/16, 1/23, 1/30, 2/5/25
CNS‑3883964#
SANTA BARBARA
INDEPENDENT
FICTITIOUS BUSINESS NAME
STATEMENT
FILE NO. FBN2024‑0003018
The following person(s) is (are) doing business as: BMRC, 93 Castilian Dr, Goleta, CA 93117 County of SANTA BARBARA Bharat Markin Research
Corporation, 93 Castilian Dr, Goleta, CA 93117
This business is conducted by a Corporation
The registrant(s) commenced to transact business under the fictitious business name or names listed above on 12/12/2024. Bharat Markin Research
Corporation
S/ Anish Bhattacharjya, CHIEF
EXECUTIVE OFFICER
This statement was filed with the County Clerk of Santa Barbara County on 12/30/2024. Joseph E. Holland, County Clerk 1/16, 1/23, 1/30, 2/5/25 CNS‑3879256# SANTA BARBARA
INDEPENDENT
FICTITIOUS BUSINESS NAME STATEMENT The following person(s) is/are doing business as: SAN ROQUE CABINETS: 6 Harbor Way Suite 192 Santa Barbara, CA 93109; Craig S Gutshall (same address) This business is conducted by A Individual Registrant commenced to transact business under the fictitious business name or names listed above on Jan 1, 2025. Filed by: CRAIG S GUTSHALL/OWNER with the County Clerk of Santa Barbara County on Jan 8, 2025. This statement expires five years from the date it was filed in the Office of the County Clerk. Joseph E. Holland, County Clerk (SEAL) by E71. FBN Number: 2025‑0000059. Published: Jan 16, 23, 30. Feb 5 2025.
FICTITIOUS BUSINESS NAME STATEMENT The following person(s) is/ are doing business as: SOLVANG JELLY FACTORY: 583 Amber Way Solvang, CA 93463; David C Jonsen (same address) This business is conducted by A Individual Registrant commenced to transact business under the fictitious business name or names listed above on Dec 17, 2024. Filed by: DAVID C. JONSEN/OWNER with the County Clerk of Santa Barbara County on Dec 17, 2024. This statement expires five years from the date it was filed in the Office of the County Clerk. Joseph E. Holland, County Clerk (SEAL) by E30. FBN Number: 2024‑0002973. Published:

Jan 16, 23, 30. Feb 5 2025.
FICTITIOUS BUSINESS NAME STATEMENT The following person(s) is/are doing business as: NATIONAL AUTO BODY & PAINT: 879 S Kellogg Ave Goleta, CA 93117; National Auto Body & Paint Inc. (same address) This business is conducted by A Corporation Registrant commenced to transact business under the fictitious business name or names listed above on Jan 5, 1995. Filed by: JOSEPH ANTONUCCI/ OWNER with the County Clerk of Santa Barbara County on Jan 7, 2025. This statement expires five years from the date it was filed in the Office of the County Clerk. Joseph E. Holland, County Clerk (SEAL) by E71. FBN Number: 2025‑0000053. Published: Jan 16, 23, 30. Feb 5 2025.
FICTITIOUS BUSINESS NAME STATEMENT The following person(s) is/are doing business as: SUNSWEPT SAILING, SUNSWEPTSAILING. COM, SUNSWEPT YACHT SALES, SUNSWEPTYACHTSALES. COM, SUNSWEPT YACHTS, SUNSWEPTYACHTS.COM, DISCOVERCHANNELISLANDS.COM:
311 Shoreline Drive, Santa Barbara Harbor Marina 2B018 Santa Barbara, CA 93109; Spencer J Macrae 246 Puente Drive Santa Barbara, CA 93110 This business is conducted by A Individual Registrant commenced to transact business under the fictitious business name or names listed above on May 24, 2012. Filed by: SPENCER J. MACRAE/ OWNER with the County Clerk of Santa Barbara County on Jan 6, 2025. This statement expires five years from the date it was filed in the Office of the County Clerk. Joseph E. Holland, County Clerk (SEAL) by E30. FBN Number: 2025‑0000037. Published: Jan 16, 23, 30. Feb 5 2025.
FICTITIOUS BUSINESS NAME
STATEMENT The following person(s) is/are doing business as: M.D.L. PRODUCTIONS: 1221 State Street, Suite 12 Santa Barbara, CA 93101; Michael D Lampkin (same address) This business is conducted by A Individual Registrant commenced to transact business under the fictitious business
name or names listed above on Dec 19, 2024. Filed by: MICHAEL LAMPKIN with the County Clerk of Santa Barbara County on Jan 6, 2025. This statement expires five years from the date it was filed in the Office of the County Clerk. Joseph E. Holland, County Clerk (SEAL) by E73. FBN Number: 2025‑0000038. Published: Jan 16, 23, 30. Feb 5 2025.
FICTITIOUS BUSINESS NAME
STATEMENT The following person(s) is/are doing business as: ALEBRUE TALLERES Y TESOROS: 2915 De La Vina Street Santa Barbara, CA 93105; Claudis M Berumen (same address) This business is conducted by A Individual Registrant commenced to transact business under the fictitious business name or names listed above on Dec 10, 2024. Filed by: CLAUDIA BERUMAN/ OWNER with the County Clerk of Santa Barbara County on Dec 11, 2024. This statement expires five years from the date it was filed in the Office of the County Clerk. Joseph E. Holland, County Clerk (SEAL) by E67. FBN Number: 2024‑0002902. Published: Jan 16, 23, 30. Feb 5 2025.
FICTITIOUS BUSINESS NAME
STATEMENT The following person(s) is/are doing business as: BEAR TECHNOLOGY GROUP: 2911 Foothill Rd Santa Barbara, CA 93105‑2905; Keith A Carlson (same address) This business is conducted by A Individual Registrant commenced to transact business under the fictitious business name or names listed above on Jan 1, 2025. Filed by: KEITH A. CARLSON with the County Clerk of Santa Barbara County on Jan 9, 2025. This statement expires five years from the date it was filed in the Office of the County Clerk. Joseph E. Holland, County Clerk (SEAL) by E30. FBN Number: 2025‑0000087. Published: Jan 16, 23, 30. Feb 5 2025.
FICTITIOUS BUSINESS NAME STATEMENT The following person(s) is/are doing business as: SANTA BARBARA NEUROPSYCHOLOGY, SBNP: 5276 Hollister Ave, Ste 307 Santa Barbara, CA 93111; Santa Barbara Neuropsychology, Corporation (same address) This business is conducted by A Corporation Registrant commenced
to transact business under the fictitious business name or names listed above on Jul 30, 2024. Filed by: MEGAN L. BECKER WRIGHT/OWNER with the County Clerk of Santa Barbara County on Jan 1, 2025. This statement expires five years from the date it was filed in the Office of the County Clerk. Joseph E. Holland, County Clerk (SEAL) by E57. FBN Number: 2025‑0000005. Published: Jan 16, 23, 30. Feb 5 2025.
FICTITIOUS BUSINESS NAME STATEMENT
FILE NO. FBN 2024‑0001831
The following person(s) is doing business as:
JANINE LUCIA FLORALS, 4971
CARPINTERIA AVE APT C CARPINTERIA, CA 93013, County of SANT BARBARA. JANINE YOTHERS, 4971
CARPINTERIA AVE APT C CARPINTERIA, CA 93013
This business is conducted by AN INDIVIDUAL.
The registrant commenced to transact business under the fictitious business name or names listed above on NOT APPLICABLE /s/ JANINE YOTHERS
This statement was filed with the County Clerk of Santa Barbara County on 08/07/2024. Joseph E. Holland, County Clerk 1/16, 1/23, 1/30, 2/5/25 CNS‑3884164# SANTA BARBARA INDEPENDENT
FICTITIOUS BUSINESS NAME STATEMENT The following person(s) is/are doing business as: MONTECITO
MASSAGE: 1211 Coast Village Rd 1 Santa Barbara, CA 93108; Jeff B Dutcher (same address) This business is conducted by A Individual Registrant commenced to transact business under the fictitious business name or names listed above on N/A. Filed by: JEFF DUTCHER/OWNER with the County Clerk of Santa Barbara County on Jan 7, 2025. This statement expires five years from the date it was filed in the Office of the County Clerk. Joseph E. Holland, County Clerk (SEAL) by E71. FBN Number: 2025‑0000052. Published:
Jan 16, 23, 30. Feb 5 2025.
FICTITIOUS BUSINESS NAME
STATEMENT The following person(s) is/are doing business as: RENGA BROTHERS INTERIORS: 2614 De La Vina Street Santa Barbara, CA 93105; Jessie A Renga (same address) This business is conducted by A Individual Registrant commenced to transact business under the fictitious business name or names listed above on Jan 7, 2025. Filed by: JESSIE RENGA/OWNER with the County Clerk of Santa Barbara County on Jan 13, 2025. This statement expires five years from the date it was filed in the Office of the County Clerk. Joseph E. Holland, County Clerk (SEAL) by E24. FBN Number: 2025‑0000095. Published: Jan 23, 30. Feb 5, 13 2025.
FICTITIOUS BUSINESS NAME
STATEMENT The following person(s) is/are doing business as: SEE INTERNATIONAL: 6500 Hollister Ave., Suite 120 Goleta, CA 93117; Surgical Eye Expeditions International, Inc Goleta, CA 93117 This business is conducted by A Corporation Registrant commenced to transact business under the fictitious business name or names listed above on Aug 26, 1974. Filed by: RACHEL TENNANT/CHIEF DEVELOPMENT
OFFICER with the County Clerk of Santa Barbara County on Dec 3, 2024. This statement expires five years from the date it was filed in the Office of the County Clerk. Joseph E. Holland, County Clerk (SEAL) by E30. FBN Number: 2024‑0002837. Published: Jan 23, 30. Feb 5, 13 2025.
FICTITIOUS BUSINESS NAME
STATEMENT
FILE NO. FBN2025‑0000049
The following person(s) is (are) doing business as: GREEN RODENT RESTORATION OF SANTA BARBARA, 827 State St , Suite 21, Santa Barbara, CA 93101 County of SANTA BARBARA GRR SB COUNTY LLC, 827 State St , Suite 21, Santa Barbara, CA 93101 This business is conducted by a limited liability company
The registrant(s) commenced to
LOCALES DE CONSTRUCCIÓN - CÓDIGO DE ALCANCE EV
transact business under the fictitious business name or names listed above on N/A. GRR SB COUNTY LLC S/ SHAY KALMANOVICH, MANAGER
This statement was filed with the County Clerk of Santa Barbara County on 01/07/2025. Joseph E. Holland, County Clerk 1/23, 1/30, 2/5, 2/13/25
CNS‑3880180# SANTA BARBARA
INDEPENDENT
FICTITIOUS BUSINESS NAME STATEMENT FILE NO. FBN2025‑0000046
The following person(s) is (are) doing business as: RAMOS LANDSCAPING GARDENING, 246 W ALAMAR AVE APT 5, SANTA BARBARA, CA 93105 County of SANTA BARBARA
ALFREDO RAMOS CRUZ, 246 W ALAMAR AVE APT 5, SANTA BARBARA, CA 93105
This business is conducted by an Individual
The registrant(s) commenced to transact business under the fictitious business name or names listed above on N/A. S/ ALFREDO RAMOS CRUZ This statement was filed with the County Clerk of Santa Barbara County on 01/07/2025. Joseph E. Holland, County Clerk 1/23, 1/30, 2/5, 2/13/25
CNS‑3880778#
SANTA BARBARA
INDEPENDENT
FICTITIOUS BUSINESS NAME STATEMENT The following person(s) is/are doing business as: 3 L’S POOL SERVICE: 211 Village Circle Drive Lompoc, CA 93436; Leyver Campuzano Vences (same address) This business is conducted by A Individual Registrant commenced to transact business under the fictitious business name or names listed above on Dec 19, 2024. Filed by: LEYVER CAMPUZANO VENCES/OWNER with the County Clerk of Santa Barbara County on Dec 23, 2024. This statement
AVISO DE AUDIENCIA PÚBLICA AYUNTAMIENTO
Audiencia pública híbrida: en persona y vía Zoom 4 de Febrero, 2025, a las 5:30 P.M.
ATENCIÓN: La reunión se realizará de forma presencial y a través de la plataforma Zoom. El público también podrá ver la reunión en Goleta Canal 19 y/o en línea en https://cityofgoleta.org/goletameetings
SE DA AVISO que el Concejo Municipal llevará a cabo una audiencia pública para llevar exempt a cabo la segunda lectura de la siguiente ordenanza de acuerdo con la Sección del Código de Gobierno 50022.3:
Ordenanza del Concejo Municipal de la Ciudad de Goleta, California, que enmienda el Título 15, Capítulo 15.12 (Edificios Ecológicos) del Código Municipal de Goleta, eximiendo a los hospitales del Código de Alcance de Vehículos Eléctricos y determinando que la enmienda está exenta de la Ley de Calidad Ambiental de California. La fecha, hora y lugar de la audiencia pública del Concejo Municipal se establecen a continuación. La agenda de la audiencia también se publicará en el sitio web de la Ciudad. (www.cityofgoleta.org).
INFORMACIÓN DE LA AUDIENCIA PÚBLICA:
FECHA/HORA: Martes, 4 de Febrero, 2025, a las 5:30 PM
SITIO: Ayuntamiento de Goleta, 130 Cremona Drive, Goleta, CA, 93117 y reunión por teleconferencia; esta reunión se llevará a cabo en persona y vía Zoom (con instrucciones detalladas para participar incluidas en la agenda publicada)
DESCRIPCIÓN DEL PROYECTO:
La enmienda propuesta a la ordenanza eximiría las modificaciones a los hospitales en la Zona de Superposición de Hospitales designada en el Código Municipal de Goleta (CMG) de los requisitos del Código de Alcance de Vehículos Eléctricos (EV) de la Ciudad (Capítulo 15.12 del CMG). La Zona de Superposición de Hospitales es la única área dentro de la Ciudad donde hay un hospital existente.
COMENTARIOS PÚBLICOS: Se anima a las personas interesadas a proporcionar comentarios públicos durante la audiencia pública en persona o virtualmente a través del seminario web Zoom, siguiendo las instrucciones que figuran en la agenda de la reunión del Concejo Municipal. Se pueden enviar comentarios por escrito antes de la audiencia enviando un correo electrónico al Secretario Municipal a CityClerkgroup@cityofgoleta.org. Los comentarios escritos se distribuirán al Concejo y se publicarán en la página de Agenda y Reuniones de la Ciudad.
PARA INFORMACIÓN DEL PROYECTO: Para obtener más información sobre el proyecto, comuníquese con la Gerente de Sostenibilidad Dana Murray al 805-961-7547 o dmurray@cityofgoleta.org o sostenibilidad@cityofgoleta.org. Para consultas en español, comuníquese con Marcos Martínez al (805) 562-5500 o mmartinez@cityofgoleta.org. Los informes y documentos del personal se publicarán aproximadamente 72 horas antes de la audiencia en el sitio web de la Ciudad en www.cityofgoleta.org
NOTA: Si impugna la naturaleza de la acción anterior en el tribunal, es posible que se le limite solo a aquellas cuestiones que usted u otra persona plantearon en la audiencia pública descrita en este aviso o en correspondencia escrita entregada a la Ciudad en la fecha de la audiencia o antes ( Sección 65009(b)(2) del Código de Gobierno).
NOTA: De conformidad con la Ley de Estadounidenses con Discapacidades, si necesita ayuda para participar en la audiencia, comuníquese con la Oficina de la Secretaria Municipal al (805) 961-7505 o cityclerkgroup@cityofgoleta.org. La notificación al menos 48 horas antes de la audiencia permitirá al personal de la Ciudad hacer arreglos razonables.
Fecha de publicación: Santa Barbara Independent 23 de Enero, 2025, y 30 de Enero, 2025
expires five years from the date it was filed in the Office of the County Clerk.
Joseph E. Holland, County Clerk (SEAL) by E30. FBN Number: 2024‑0002991. Published: Jan 23, 30. Feb 5, 13 2025.
FICTITIOUS BUSINESS NAME
STATEMENT
FILE NO. FBN2025‑0000047
The following person(s) is (are) doing business as:
CANYON CREEK LANDSCAPE SERVICES, 6806 PHELPS RD APT 217, GOLETA, CA 93117
County of SANTA BARBARA
PEDRO LOPEZ‑LOPEZ, 6806
PHELPS RD APT 217, GOLETA, CA 93117
This business is conducted by an Individual
The registrant(s) commenced to transact business under the fictitious business name or names listed above on N/A.
S/ PEDRO LOPEZ‑LOPEZ
This statement was filed with the County Clerk of Santa Barbara County on 01/07/2025.
Joseph E. Holland, County Clerk 1/23, 1/30, 2/6, 2/13/25
CNS‑3880780# SANTA BARBARA INDEPENDENT
FICTITIOUS BUSINESS NAME
STATEMENT The following person(s) is/are doing business as: MILK AND HONEY, MILK & HONEY: 30 W Anapamu Street Santa Barbara, CA 93101; The Bitar Group MH, LLC 3343 State Street Santa Barbara, CA 93105 This business is conducted by A Limited Liability Company Registrant commenced to transact business under the fictitious business name or names listed above on Jan 12, 2025. Filed by: GEORGES
BITAR/MANAGER with the County Clerk of Santa Barbara County on Jan 15, 2025. This statement expires five years from the date it was filed in the Office of the County Clerk. Joseph E. Holland, County Clerk (SEAL) by E71. FBN Number: 2025‑0000135. Published: Jan 23, 30. Feb 5, 13 2025.
FICTITIOUS BUSINESS NAME STATEMENT
FILE NO. FBN 2024‑0002934
The following person(s) is doing business as:
EXPRESS PIPE & SUPPLY CO., 15850 DALLAS PARKWAY, DALLAS TEXAS 75248, County of DALLAS.
REECE SUPPLY, LLC, 15850 DALLAS PARKWAY, DALLAS TEXAS 75248
This business is conducted by A Limited Liability Company.
The registrant commenced to transact business under the fictitious business name or names listed above on N/A /s/ DERYL WARD, SECRETARY This statement was filed with the County Clerk of Santa Barbara County on 12/13/2024. Joseph E. Holland, County Clerk 1/23, 1/30, 2/5, 2/13/25
CNS‑3886569# SANTA BARBARA
INDEPENDENT
FICTITIOUS BUSINESS NAME
STATEMENT The following person(s)
is/are doing business as: SB SHARKS FOOTBALL: 27 W Anapamu Street Suite 447 Santa Barbara, CA 93101; Santa Barbara Sharks Football (same address) This business is conducted by A Corporation Registrant commenced to transact business under the fictitious business name or names listed above on Jan 16, 2025. Filed by: LISA VELEZ/ TREASURER with the County Clerk of Santa Barbara County on Jan 16, 2025. This statement expires five years from the date it was filed in the Office of the County Clerk. Joseph E. Holland, County Clerk (SEAL) by E71. FBN Number: 2025‑0000137. Published: Jan 23, 30. Feb 5, 13 2025.
FICTITIOUS BUSINESS NAME
STATEMENT The following person(s) is/are doing business as: SYLVA PARTNERS: 1187 Coast Village Road Montecito, CA 93108; Alvn Moore (same address) Gun Dukes 597 Freehaven Drive Montecito, CA 93108 This business is conducted by A Limited Partnership Registrant commenced to transact business under the fictitious business name or names listed above on Jan 1, 1981. Filed by: GUN DUKES with the County Clerk of Santa Barbara County on Jan 16, 2025. This statement
expires five years from the date it was filed in the Office of the County Clerk. Joseph E. Holland, County Clerk (SEAL) by E71. FBN Number: 2025‑0000139. Published: Jan 23, 30. Feb 5, 13 2025.
FICTITIOUS BUSINESS NAME STATEMENT FILE NO. FBN 2024‑0003017
The following person(s) is doing business as: THE BLUESZONE CAFE, 1576 COPENHAGEN DR SOLVANG, CA 93463, County of SANTA BARBARA. PELONIS SOUND AND ACOUSTICS, INC., 102 N. MILPAS STREET SANTA BARBARA, CA 93103, CA
This business is conducted by A CORPORATION.
The registrant commenced to transact business under the fictitious business name or names listed above on NOT APPLICABLE /s/ CHRIS PELONS, PRESIDENT
This statement was filed with the County Clerk of Santa Barbara County on 12/30/2024.
Joseph E. Holland, County Clerk 1/23, 1/30, 2/6, 2/13/25
CNS‑3885945# SANTA BARBARA INDEPENDENT
FICTITIOUS BUSINESS NAME STATEMENT FILE NO. FBN 2024‑0003035
The following person(s) is doing business as:
REECE USA 15850 DALLAS PARKWAY, DALLAS, TEXAS 95248, County of DALLAS. REECE, INC., 15850 DALLAS PARKWAY, DALLAS, TEXAS 95248;State of Inc./Org./Reg. TEXAS
This business is conducted by A Corporation.
The registrant commenced to transact business under the fictitious business name or names listed above on Jun 03, 2024 /s/ DERYL WARD, SECRETARY
This statement was filed with the County Clerk of Santa Barbara County on 12/31/2024.
Joseph E. Holland, County Clerk 1/23, 1/30, 2/5, 2/13/25
CNS‑3886795# SANTA BARBARA
INDEPENDENT
INVITATION FOR BIDS
INVITATION TO BID
Habitat Santa Barbara is soliciting sealed bids for Roof Repair located 970 Medio St Santa Barbara CA 93103. The scope of work consists of but is not limited to: roof replacement – like‑ for‑like.
Habitat Santa Barbara will receive sealed bids until 2/17/25 at 4pm for the proposed work at 710 E Cota St. at which time and place all bids will be opened on 2/20/25 at 10am at 710 E Cota. For bids to be considered responsible contractors must attend a mandatory job walk at 2/10/25 at the job site of 970 Medio St at 2pm.
Contract documents, including specifications, may be obtained by visiting 710 E. Cota St., Santa Barbara, during regular office hours.
Bids shall be accompanied by a bid guarantee in the form of a money order, cashiers check, certified check or bank draft payable to the Sponsor, U.S. Government bonds, or a satisfactory bid bond executed by the bidder and acceptable sureties in an amount equal to five (5%) of the bid. No bid may be withdrawn for a period of thirty (30) days after bid opening.
All bidders will be required to certify that they are not on the federal Consolidated List of Debarred, Suspended and Negligible Contractors.
All bidders are required to be Public Works Contractors registered with the California Department of Industrial Relations. The contract documents required to accompany all bids (Certifications, bid bond, form of bid, etc.) shall be in an envelope which shall be clearly labeled with the words “Contract Bid Documents” and show the project identifications, name of bidder, name
of project and date and time of opening.
Contracts awarded under these contract documents in excess of $150,000 shall be required to post a performance bond or equivalent security and a Payment bond for contracts over $25,000. The successful bidder will be required to furnish evidence of Worker’s Compensation and Liability Insurance in the favor and amount as required by these contract documents.
The successful bidder will be required to comply with all nondiscrimination laws and regulations pursuant to the provisions of these contract documents.
Habitat Santa Barbara reserves the right to postpone, accept or reject any or all bids as Habitat Santa Barbara deems in its own best interest, subject to the terms and provisions of the contract documents.
For any additional information please contact Steven Moliterno at repairs@ sbhabitat.org. Published: Jan 23, 30 2025.
INVITATION TO BID
Habitat Santa Barbara is soliciting sealed bids for electrical system upgrade located 511 De La Vista Ave Santa Barbara CA 93103. The scope of work consists of but is not limited to: Installation and re‑wiring of entire home to current code. Remove knob and tube wiring. Install updated panel.
Habitat Santa Barbara will receive sealed bids until 2/17/25 at 4pm for the proposed work at 710 E Cota St. at which time and place all bids will be opened on 2/20/25 at 10am at 710 E Cota St.
For bids to be considered responsible contractors must attend a mandatory job walk at 2/10/25 at the job site of 511 De La Vista Ave at 12 pm.
Contract documents, including specifications, may be obtained by visiting 710 E. Cota St., Santa Barbara, during regular office hours.
Bids shall be accompanied by a bid guarantee in the form of a money order, cashiers check, certified check or bank draft payable to the Sponsor, U.S. Government bonds, or a satisfactory bid bond executed by the bidder and acceptable sureties in an amount equal to five (5%) of the bid. No bid may be withdrawn for a period of thirty (30) days after bid opening.
All bidders will be required to certify that they are not on the federal Consolidated List of Debarred, Suspended and Negligible Contractors.
All bidders are required to be Public Works Contractors registered with the California Department of Industrial Relations. The contract documents required to accompany all bids (Certifications, bid bond, form of bid, etc.) shall be in an envelope which shall be clearly labeled with the words “Contract Bid Documents” and show the project identifications, name of bidder, name of project and date and time of opening.
Contracts awarded under these contract documents in excess of $150,000 shall be required to post a performance bond or equivalent security and a Payment bond for contracts over $25,000. The successful bidder will be required to furnish evidence of Worker’s Compensation and Liability Insurance in the favor and amount as required by these contract documents.
The successful bidder will be required to comply with all nondiscrimination laws and regulations pursuant to the provisions of these contract documents.
Habitat Santa Barbara reserves the right to postpone, accept or reject any or all bids as Habitat Santa Barbara deems in its own best interest, subject to the terms and provisions of the contract documents.
For any additional information please contact Steven Moliterno at repairs@ sbhabitat.org. Published: Jan 23, 30 2025
INVITATION TO BID Habitat Santa Barbara is soliciting
sealed bids for Roof Repair located 1416 Portesuello Ave Santa Barbara CA 93105. The scope of work consists of but is not limited to: roof replacement –like‑for‑like.
Habitat Santa Barbara will receive sealed bids until 2/17/25 at 4pm for the proposed work at 710 E Cota St. at which time and place all bids will be opened on 2/20/25 at 10 am at 710 E Cota St. For bids to be considered responsible contractors must attend a mandatory job walk at 2/10/25 at the job site of 1416 Portesuello Ave Santa Barbara CA 93105 at 10am.
Contract documents, including specifications, may be obtained by visiting 710 E. Cota St., Santa Barbara, during regular office hours.
Bids shall be accompanied by a bid guarantee in the form of a money order, cashiers check, certified check or bank draft payable to the Sponsor, U.S. Government bonds, or a satisfactory bid bond executed by the bidder and acceptable sureties in an amount equal to five (5%) of the bid. No bid may be withdrawn for a period of thirty (30) days after bid opening.
All bidders will be required to certify that they are not on the federal Consolidated List of Debarred, Suspended and Negligible Contractors. All bidders are required to be Public Works Contractors registered with the California Department of Industrial Relations. The contract documents required to accompany all bids (Certifications, bid bond, form of bid, etc.) shall be in an envelope which shall be clearly labeled with the words “Contract Bid Documents” and show the project identifications, name of bidder, name of project and date and time of opening.
Contracts awarded under these contract documents in excess of $150,000 shall be required to post a performance bond or equivalent security and a Payment bond for contracts over $25,000. The successful bidder will be required to furnish evidence of Worker’s Compensation and Liability Insurance in the favor and amount as required by these contract documents.
The successful bidder will be required to comply with all nondiscrimination laws and regulations pursuant to the provisions of these contract documents.
Habitat Santa Barbara reserves the right to postpone, accept or reject any or all bids as Habitat Santa Barbara deems in its own best interest, subject to the terms and provisions of the contract documents.
For any additional information please contact Steven Moliterno at repairs@ sbhabitat.org. Published: Jan 23, 30 2025.
INVITATION TO BID
Habitat Santa Barbara is soliciting sealed bids for Window/ Glass Door Replacements located 2643 State St Spc 11 Santa Barbara CA 93105. The scope of work consists of but is not limited to: Replacement of window for primary bedroom, sliding window from bedroom to back patio, and bathroom window.
Habitat Santa Barbara will receive sealed bids until 2/17/25 at 4pm for the proposed work at 710 E Cota St. at which time and place all bids will be opened on 2/20/25 at 10am at 710 E Cota St. For bids to be considered responsible contractors must attend a mandatory job walk at 2/10/25 at the job site of 2643 State St Spc 11 at 3:30pm.
Contract documents, including specifications, may be obtained by visiting 710 E. Cota St., Santa Barbara, during regular office hours.
Bids shall be accompanied by a bid guarantee in the form of a money order, cashiers check, certified check or bank draft payable to the Sponsor, U.S. Government bonds, or a satisfactory bid bond executed by the bidder and acceptable sureties in an amount equal to five (5%) of the bid. No bid may be withdrawn for a period of thirty (30) days after bid
PETITIONER: EDGAR EDUARDO
opening.
All bidders will be required to certify that they are not on the federal Consolidated List of Debarred, Suspended and Negligible Contractors. All bidders are required to be Public Works Contractors registered with the California Department of Industrial Relations. The contract documents required to accompany all bids (Certifications, bid bond, form of bid, etc.) shall be in an envelope which shall be clearly labeled with the words “Contract Bid Documents” and show the project identifications, name of bidder, name of project and date and time of opening.
Contracts awarded under these contract documents in excess of $150,000 shall be required to post a performance bond or equivalent security and a Payment bond for contracts over $25,000. The successful bidder will be required to furnish evidence of Worker’s Compensation and Liability Insurance in the favor and amount as required by these contract documents.
The successful bidder will be required to comply with all nondiscrimination laws and regulations pursuant to the provisions of these contract documents.
Habitat Santa Barbara reserves the right to postpone, accept or reject any or all bids as Habitat Santa Barbara deems in its own best interest, subject to the terms and provisions of the contract documents.
For any additional information please contact Steven Moliterno at repairs@ sbhabitat.org. Published: Jan 23, 30 2025.
NOTICE OF PUBLIC SALE
To satisfy the owner’s storage lien, PS Retail Sales, LLC will sell at public lien sale on January 31, 2025, the personal property in the below‑listed units. The public sale of these items will begin at 08:00 AM and continue until all units are sold. The lien sale is to be held at the online auction website, www.storagetreasures.com, where indicated. For online lien sales, bids will be accepted until 2 hours after the time of the sale specified. PUBLIC STORAGE # 25714, 7246 Hollister Ave, Goleta, CA 93117, (805) 324‑6770 Sale to be held at www.storagetreasures.com. 4104 ‑ Vargas, Joe; 6332 ‑ Almanza, Carol; 6434 ‑ campos, Oliver; A219 ‑ Brian, Alan; A238 ‑ Paredes, Sebastian PUBLIC STORAGE # 75078, 7246 Hollister Ave, Goleta, CA 93117, (805) 961‑8198 Sale to be held at www.storagetreasures.com. 015 ‑ Kozlowski, Alan; 304 ‑ Aragon, Lucinda; 327 ‑ York, David; 332 ‑ Chapman, Tom; 357 ‑ Kozlowski, Alan; 488 ‑ Guron, Emelyn PUBLIC STORAGE # 75079, 5425 Overpass Rd, Santa Barbara, CA 93111, (805) 284‑9002 Sale to be held at www.storagetreasures.com. 178 ‑ Reyes, Fernando; 190 ‑ Hoppers, Brian; 232 ‑ Badone Assili, Genevieve Public sale terms, rules, and regulations will be made available prior to the sale. All sales are subject to cancellation. We reserve the right to refuse any bid. Payment must be in cash or credit card‑no checks. Buyers must secure the units with their own personal locks. To claim tax‑ exempt status, original RESALE certificates for each space purchased is required. By PS Retail Sales, LLC, 701 Western Avenue, Glendale, CA 91201. (818) 244‑8080. 1/23/25
CNS‑3888277# SANTA BARBARA INDEPENDENT
NAME CHANGE
IN THE MATTER OF THE APPLICATION TO SHOW CAUSE FOR CHANGE OF NAME: EDGAR EDUARDO RODRIGUEZ VALENZUELA
CASE NUMBER: 24CV06645 TO ALL INTERESTED PERSONS:
RODRIGUEZ VALENZUELA A petition has been filed by the above named Petitioner(s) in Santa Barbara Superior Court for decree changing name (s) as follows:
PRESENT NAME: EDGAR EDUARDO
RODRIGUEZ VALENZUELA
PROPOSED NAME: EDGAR EDUARDO
RODRIGUEZ
THE COURT ORDERS that all persons interested in this matter shall appear before this court at the hearing indicated below to show cause, if any, why the petition for change of name should not be granted. Any person objecting to the name changes described above must file a written objection that includes the reasons for the objection at least two court days before the matter is scheduled to be heard and must appear at the hearing to show cause why the petition should not be granted. If no written objection is timely filed, the court may grant the petition without a hearing. Notice of Hearing February 24, 2025, 10:00 am, DEPT: 5 SANTA BARBARA SUPERIOR COURT COUNTY OF SANTA BARBARA 1100 Anacapa Street., P.O BOX 21107 Santa Barbara, CA 93121‑1107, ANACAPA DIVISION A copy of this Order to Show Cause shall be published in the Independent, a newspaper of general circulation, printed in this county, at least once each week for four successive weeks prior to the date set for hearing on the petition. Dated DECEMBER 12, 2024, JUDGE Colleen k. Sterne of the Superior Court. Published Jan 9, 16, 23, 30 2025.
IN THE MATTER OF THE APPLICATION TO SHOW CAUSE FOR CHANGE OF NAME: BELLA ROSE PADILLA LIBBY CASE NUMBER: 24CV06421 TO ALL INTERESTED PERSONS: PETITIONER: BELLA ROSE PADILLA LIBBY A petition has been filed by the above named Petitioner(s) in Santa Barbara Superior Court for decree changing name (s) as follows: PRESENT NAME: BELLA ROSE PADILLA LIBBY PROPOSED NAME: BELLA ROSE PADILLA‑GUERRERO THE COURT ORDERS that all persons interested in this matter shall appear before this court at the hearing indicated below to show cause, if any, why the petition for change of name should not be granted. Any person objecting to the name changes described above must file a written objection that includes the reasons for the objection at least two court days before the matter is scheduled to be heard and must appear at the hearing to show cause why the petition should not be granted. If no written objection is timely filed, the court may grant the petition without a hearing. Notice of Hearing January 27, 2025, 10:00 am, DEPT: 5 SANTA BARBARA SUPERIOR COURT COUNTY OF SANTA BARBARA 1100 Anacapa Street., P.O BOX 21107 Santa Barbara, CA 93121‑1107, ANACAPA DIVISION A copy of this Order to Show Cause shall be published in the Independent, a newspaper of general circulation, printed in this county, at least once each week for four successive weeks prior to the date set for hearing on the petition. Dated NOVEMBER 25, 2024, JUDGE Colleen k. Sterne of the Superior Court. Published Jan 9, 16, 23, 30 2025.
IN THE MATTER OF THE APPLICATION TO SHOW CAUSE FOR CHANGE OF NAME: MAMMAD NAVAB CASE NUMBER: 24CV07159 TO ALL INTERESTED PERSONS:
PETITIONER: MAMMAD NAVAB A petition has been filed by the above named Petitioner(s) in Santa Barbara Superior Court for decree changing name (s) as follows: PRESENT NAME: MAMMAD NAVAB PROPOSED NAME: MOHAMAD NAVAB THE COURT ORDERS that all persons interested in this matter shall appear before this court at the hearing indicated below to show cause, if any, why the petition for change of name should not be granted. Any person objecting to the name changes described above must file a written objection that includes the reasons for the objection at least two court days before the matter is scheduled to be heard and must appear at the hearing to show cause why the petition should not be granted. If no written objection is timely filed, the court may grant the
petition without a hearing. Notice of Hearing February 28, 2025, 10:00 am, DEPT: 4, SANTA BARBARA SUPERIOR COURT COUNTY OF SANTA BARBARA 1100 Anacapa Street., P.O BOX 21107 Santa Barbara, CA 93121‑1107, ANACAPA DIVISION A copy of this Order to Show Cause shall be published in the Independent, a newspaper of general circulation, printed in this county, at least once each week for four successive weeks prior to the date set for hearing on the petition. Dated JANUARY 7, 2025, JUDGE Donna D. Geck of the Superior Court. Published Jan 16, 23, 30. Feb 5 2025.
IN THE MATTER OF THE APPLICATION TO SHOW CAUSE FOR CHANGE OF NAME: MARIT TER MATE‑MARTINSEN AND ERIC MARTINSEN CASE NUMBER: 24CV07081 TO ALL INTERESTED PERSONS: PETITIONER: MARIT TER MATE‑MARTINSEN AND ERIC MARTINSEN A petition has been filed by the above named Petitioner(s) in Santa Barbara Superior Court for decree changing name (s) as follows: PRESENT NAME: LOUISA SAGE MARTINSEN PROPOSED NAME: LUANA SAGE MARTINSEN
THE COURT ORDERS that all persons interested in this matter shall appear before this court at the hearing indicated below to show cause, if any, why the petition for change of name should not be granted. Any person objecting to the name changes described above must file a written objection that includes the reasons for the objection at least two court days before the matter is scheduled to be heard and must appear at the hearing to show cause why the petition should not be granted. If no written objection is timely filed, the court may grant the petition without a hearing. Notice of Hearing February 24, 2025, 10:00 am, DEPT: 5, SANTA BARBARA SUPERIOR COURT COUNTY OF SANTA BARBARA 1100 Anacapa Street., P.O BOX 21107 Santa Barbara, CA 93121‑1107, SANTA BARBARA COUNTY COURTHOUSE A copy of this Order to Show Cause shall be published in the Independent, a newspaper of general circulation, printed in this county, at least once each week for four successive weeks prior to the date set for hearing on the petition. Dated JANUARY 6, 2025, JUDGE Colleen K. Sterne of the Superior Court. Published Jan 16, 23, 30. Feb 5 2025. IN THE MATTER OF THE APPLICATION TO SHOW CAUSE FOR CHANGE OF NAME: CYRUS JAYDE ALEXANDER CASE NUMBER: 24CV07155 TO ALL INTERESTED PERSONS: PETITIONER: CYRUS JAYDE ALEXANDER A petition has been filed by the above named Petitioner(s) in Santa Barbara Superior Court for decree changing name (s) as follows: PRESENT NAME: CYRUS JAYDE ALEXANDER PROPOSED NAME: CyrusJayde Alexander THE COURT ORDERS that all persons interested in this matter shall appear before this court at the hearing indicated below to show cause, if any, why the petition for change of name should not be granted. Any person objecting to the name changes described above must file a written objection that includes the reasons for the objection at least two court days before the matter is scheduled to be heard and must appear at the hearing to show cause why the petition should not be granted. If no written objection is timely filed, the court may grant the petition without a hearing. Notice of Hearing February 28, 2025, 10:00 am, DEPT: 4, SANTA BARBARA SUPERIOR COURT COUNTY OF SANTA BARBARA 1100 Anacapa Street., P.O BOX 21107 Santa Barbara, CA 93121‑1107, ANACAPA DIVISION A copy of this Order to Show Cause shall be published in the Independent, a newspaper of general circulation, printed in this county, at least once each week for four successive weeks prior to the date set for hearing on the petition. Dated JANUARY 7, 2025, JUDGE Donna D. Geck of the Superior Court. Published Jan 16, 23, 30. Feb 5 2025.
IN THE MATTER OF THE APPLICATION TO SHOW CAUSE FOR CHANGE OF NAME: ARLIN HUBERT HAMM JR. CASE NUMBER: 24CV07023 TO ALL INTERESTED PERSONS:
PETITIONER: ARLIN HUBERT HAMM
JR. A petition has been filed by the above named Petitioner(s) in Santa Barbara Superior Court for decree changing name (s) as follows:
PRESENT NAME: ARLIN HUBERT
HAMM JR.
PROPOSED NAME: ALLEN MICHAEL
HAMM
THE COURT ORDERS that all persons interested in this matter shall appear before this court at the hearing indicated below to show cause, if any, why the petition for change of name should not be granted. Any person objecting to the name changes described above must file a written objection that includes the reasons for the objection at least two court days before the matter is scheduled to be heard and must appear at the hearing to show cause why the petition should not be granted. If no written objection is timely filed, the court may grant the petition without a hearing.
Notice of Hearing February 26, 2025, 10:00 am, DEPT: 3, SANTA BARBARA SUPERIOR COURT COUNTY OF SANTA BARBARA 1100 Anacapa Street., P.O BOX 21107 Santa Barbara, CA 93121‑1107, ANACAPA DIVISION A copy of this Order to Show Cause shall be published in the Independent, a newspaper of general circulation, printed in this county, at least once each week for four successive weeks prior to the date set for hearing on the petition. Dated DECEMBER 30, 2024, JUDGE Thomas P. Anderle of the Superior Court. Published Jan 16, 23, 30. Feb 5 2025.
IN THE MATTER OF THE APPLICATION
TO SHOW CAUSE FOR CHANGE OF
NAME: HANNAH ROSE MANGOLD CASE NUMBER: 24CV06773
TO ALL INTERESTED PERSONS:
PETITIONER: HANNAH ROSE
MANGOLD A petition has been filed by the above named Petitioner(s) in Santa Barbara Superior Court for decree changing name (s) as follows:
PRESENT NAME: HANNAH ROSE
MANGOLD PROPOSED NAME: HANNAH ROSE
ROBERTOVNA MANGOLD
THE COURT ORDERS that all persons interested in this matter shall appear before this court at the hearing indicated below to show cause, if any, why the petition for change of name should not be granted. Any person objecting to the name changes described above must file a written objection that includes the reasons for the objection at least two court days before the matter is scheduled to be heard and must appear at the hearing to show cause why the petition should not be granted. If no written objection is timely filed, the court may grant the petition without a hearing. Notice of Hearing February 19, 2025, 10:00 am, DEPT: 3, SANTA BARBARA SUPERIOR COURT COUNTY OF SANTA BARBARA 1100 Anacapa Street., P.O BOX 21107 Santa Barbara, CA 93121‑1107, SUPREME COURT of CALIFORNIA COUNTY of SANTA
BARBARA A copy of this Order to Show Cause shall be published in the Independent, a newspaper of general circulation, printed in this county, at least once each week for four successive weeks prior to the date set for hearing on the petition. Dated JANUARY 8, 2025, JUDGE Thomas P. Anderle of the Superior Court. Published Jan 23, 30. Feb 5, 13 2025.
IN THE MATTER OF THE APPLICATION
TO SHOW CAUSE FOR CHANGE OF NAME: KURT DURAN YALCIN CASE NUMBER: 25CV00014
TO ALL INTERESTED PERSONS:
PETITIONER: KURT DURAN YALCIN A petition has been filed by the above named Petitioner(s) in Santa Barbara Superior Court for decree changing name (s) as follows: PRESENT NAME: KURT DURAN YALCIN
PROPOSED NAME: KURT DURAN YALCIN LUCOVSKY THE COURT ORDERS that all persons interested in this matter shall appear before this court at the hearing indicated below to show cause, if any, why the petition for change of name should not be granted. Any person objecting to the name changes described above must file a written objection that includes the reasons for the objection at least two court days before the matter is scheduled to be heard and must appear at the hearing to show cause why the petition should not be granted. If no written
objection is timely filed, the court may grant the petition without a hearing. Notice of Hearing March 12, 2025, 10:00 am, DEPT: 3, SANTA BARBARA SUPERIOR COURT COUNTY OF SANTA BARBARA 1100 Anacapa Street., P.O BOX 21107 Santa Barbara, CA 93121‑1107, ANACAPA DIVISION A copy of this Order to Show Cause shall be published in the Independent, a newspaper of general circulation, printed in this county, at least once each week for four successive weeks prior to the date set for hearing on the petition. Dated JANUARY 16, 2025, JUDGE Thomas P. Anderle of the Superior Court. Published Jan 23, 30. Feb 5, 13 2025.
Join the IVCSD Board of Directors!
The Isla Vista Community Services District is accepting applications to fill a vacancy on its Board of Directors. This is your opportunity to serve your community and make a difference!
Deadline to Apply: January 24th, 2025, by 5 PM
How to Apply: Email your resume and letter of intent to generalmanager@ islavistacsd.com
Eligibility: Must live in Isla Vista, be a U.S. citizen, and be at least 18 years old Stipend: $100 per meeting, up to $300/ month
Interviews and the appointment decision will take place during Special Meetings on January 30th and/or February 4th at 6 PM. Applicants must be available for both dates.
For more information, visit IVCSD’s Website.
SUPERIOR COURT OF CALIFORNIA COUNTY OF SANTA BARBARA 1/2/2025, Darrell E. Parker, Executive Officer, BY Teddy Napoli, Deputy Clerk.
SUPERIOR COURT FOR THE STATE OF CALIFORNIA COUNTY OF SANTA BARBARA ANACAPA DIVISION
Case No. 24EPO0412 SUMMONS
NOTICE TO NICCOLA JOSHUA
CAMACHO:
The Santa Barbara Police Department is asking for a Gun Violence Restraining Order against you. You are hereby summoned to appear before me at the Superior Court of California in and for the County of Santa Barbara, Figueroa Division, 118 E. Figueroa Street, Santa Barbara, California, Department 9 on March 25, 2025, at 8:30 a.m. to answer the request by the Santa Barbara Police Department in this case. If you do not go to your court date, the Court can grant a Gun. Violence Restraining Order preventing you from having guns and ammunition for up to five years. If you do not go to your court date, the Court could grant everything that the Santa Barbara Police Department asked the Court to order. Dated 1/2/2025
HONORABLE ELIZABETH DIAZ COMMISSIONER SANTA BARBARA SUPERIOR COURT
Published Jan 23, 30. Feb 5 13 2025.
TRUSTEE NOTICE
TITLE ORDER NO.: 2535361CAD Trustee Sale No.: 87622 Loan No.: 399481485 APN: 073‑221‑014 NOTICE OF TRUSTEE’S SALE YOU ARE IN DEFAULT UNDER A DEED OF TRUST DATED 10/30/2023 . UNLESS YOU TAKE ACTION TO PROTECT YOUR PROPERTY, IT MAY BE SOLD AT A PUBLIC SALE. IF YOU NEED AN EXPLANATION OF THE NATURE OF THE PROCEEDINGS AGAINST YOU, YOU SHOULD CONTACT A LAWYER. On 1/29/2025 at 1:00 PM, CALIFORNIA TD SPECIALISTS, AS TRUSTEE as the duly appointed Trustee under and pursuant to Deed of Trust Recorded on 11/8/2023 as Instrument No. 2023‑0033512 in book ////, page //// of official records in the Office of the Recorder of Santa Barbara County, California, executed by: JEANETTE M. RICHARDSON ZINKE, TRUSTEE U/D/T DATED NOVEMBER 21, 2006, F/B/O THE
RICHARDSON ZINKE FAMILY TRUST , as Trustor SEE ATTACHED EXHIBIT “B” , as Beneficiary
WILL SELL AT PUBLIC AUCTION TO THE HIGHEST BIDDER FOR CASH (payable at time of sale in lawful money of the United States, by cash, a cashier’s check drawn by a state or national bank, a check drawn by a state or federal credit union, or a check drawn by a state or federal savings and loan association, savings association, or savings bank specified in section 5102 of the Financial Code and authorized to do business in this state).
At: At the North door of the Main entrance to the County Courthouse located at 1100 Anacapa Street, Santa Barbara, CA 93101, NOTICE OF TRUSTEE’S SALE – continued all right, title and interest conveyed to and now held by it under said Deed of Trust in the property situated in said County, California describing the land therein: LOT 14 OF TRACT NO. 10670 UNIT NO.1 IN THE CITY OF GOLETA, COUNTY OF SANTA BARBARA, STATE OF CALIFORNIA, AS PER MAP RECORDED IN BOOK 76, PAGES 18 AND 19 OF MAPS OFFICE OF THE COUNTY RECORDER OF SAID COUNTY. EXCEPT THEREFROM THE MINERALS, OIL, GAS, AND OTHER HYDROCARBON SUBSTANCES LYING BELOW THE SURFACE OF SAID LAND. The property heretofore described is being sold “as is”. The street address and other common designation, if any, of the real property described above is purported to be: 7307 LOWELL WAY GOLETA, CA 93117. The undersigned Trustee disclaims any liability for any incorrectness of the street address and other common designation, if any, shown herein. Said sale will be made, but without covenant or warranty, expressed or implied, regarding title, possession, or encumbrances, to pay the remaining principal sum of the note(s) secured by said Deed of Trust, with interest thereon, as provided in said note(s), advances, if any, under the terms of the Deed of Trust, estimated fees, charges and expenses of the Trustee and of trusts created by said Deed of Trust, to‑wit: $360,771.08 (Estimated). Accrued interest and additional advances, if any, will increase this figure prior to sale. The beneficiary under said Deed of Trust heretofore executed and delivered to the undersigned a written Declaration of Default and Demand for Sale, and a written Notice of Default and Election to Sell. The undersigned caused said Notice of Default and Election of Sell to be recorded in the county where the real property is located and more than three months have elapsed since such recordation.
DATE:
12/26/2024 CALIFORNIA TD SPECIALISTS, AS TRUSTEE, as Trustee 8190 EAST KAISER BLVD., ANAHEIM HILLS, CA 92808 PHONE: 714‑283‑2180 FOR TRUSTEE SALE INFORMATION LOG ON TO: www. stoxposting.com CALL: 844‑477‑7869
PATRICIO S. INCE’, VICE PRESIDENT CALIFORNIA TD SPECIALIST IS A DEBT COLLECTOR ATTEMPTING TO COLLECT A DEBT. ANY INFORMATION OBTAINED WILL BE USED FOR THAT PURPOSE. “NOTICE TO POTENTIAL BIDDERS: If you are considering bidding on this property lien, you should understand that there are risks involved in bidding at a trustee auction. You will be bidding on a lien, not on the property itself. Placing the highest bid on a trustee auction does not automatically entitle you to free and clear ownership of the property. You should also be aware that the lien being auctioned off may be a junior lien. If you are the highest bidder at the auction, you are or may be responsible for paying off all liens senior to the lien being auctioned off, before you can receive clear title to the property. You are encouraged to investigate the existence, priority, and size of the outstanding lien that may exist on this property by contacting the county recorder’s office or a title insurance company, either of which may charge you a fee for this information. If you consult
either of these resources, you should be aware that the same lender may hold more than one mortgage or deed of trust on the property. NOTICE TO PROPERTY OWNER:
The sale date shown on this notice of sale may be postponed one or more times by the mortgagee, beneficiary, trustee, or a court, pursuant to Section 2924g of the California Civil Code. The law requires that information about trustee sale postponements be made available to you and to the public, as a courtesy to those not present at the sale. If you wish to learn whether your sale date has been postponed, and if applicable, the rescheduled time and date for the sale of this property, you may call 844‑477‑7869, or visit this internet Web site www. stoxposting.com, using the file number assigned to this case T.S.# 87622. Information about postponements that are very short in duration or that occur close in time to the scheduled sale may not immediately be reflected in the telephone information or on the Internet Web site.
The best way to verify postponement information is to attend the scheduled sale.” For sales conducted after January 1, 2021: NOTICE TO TENANT: You may have a right to purchase this property after the trustee auction pursuant to Section 2924m of the California Civil Code. If you are an “eligible tenant buyer,” you can purchase the property if you match the last and highest bid placed at the trustee auction. If you are an “eligible bidder,” you may be able to purchase the property if you exceed the last and highest bid placed at the trustee auction. There are three steps to exercising this right of purchase. First, 48 hours after the date of the trustee sale, you can call (844) 477‑7869, or visit this internet website www.STOXPOSTING.com, using the file number assigned to this case 87622 to find the date on which the trustee’s sale was held, the amount of the last and highest bid, and the address of the trustee.
Second, you must send a written notice of intent to place a bid so that the trustee receives it no more than 15 days after the trustee’s sale. Third, you must submit a bid; by remitting the funds and affidavit described in Section 2924m(c) of the Civil Code; so that the trustee receives it no more than 45 days after the trustee’s sale. If you think you may qualify as an “eligible tenant buyer” or “eligible bidder,” you should consider contacting an attorney or appropriate real estate professional immediately for advice regarding this potential right to purchase. Exhibit “B” The following is a list of the lenders providing funds for this loan: • Ivan J. Kass and Marcia A. Kass, Trustees of that certain Declaration of Trust dated November 15, 2005 as to an undivided 197,160/318, 000 or 62% interest; • Leira Holdings LLC as to an undivided 120,840/318,000 or 38% interest
NOTICE OF TRUSTEE’S SALE
Trustee Sale No. 24‑00317‑2FNT Loan No:*****0028/Gray APN 039‑051‑ 010 YOU ARE IN DEFAULT UNDER A DEED OF TRUST, ASSIGNMENT OF RENTS
SECURITY AGREEMENT AND FIXTURE FILING DATED OCTOBER 8, 2004. UNLESS YOU TAKE ACTION TO PROTECT YOUR PROPERTY, IT MAY BE SOLD AT A PUBLIC SALE. IF YOU NEED AN EXPLANATION OF THE NATURE OF THE PROCEEDINGS AGAINST YOU, YOU SHOULD CONTACT A LAWYER. On February 5, 2025, at 01:00 PM, at the main entrance to the County Courthouse, 1100 Anacapa St., Santa Barbara, CA 93101, FIDELITY NATIONAL TITLE COMPANY, as the duly appointed Trustee (the “Trustee”), under and pursuant to the power of sale contained in that certain Deed of Trust, Assignment of Rents Security Agreement and Fixture Filing recorded on
October 19, 2004, as Instrument No. 2004‑0110993 of official records in the office of the Recorder of Santa Barbara County, CA, executed by: Heather Veronica Gray, a single woman, as Trustor (the “Trustor”), in favor of Santa Barbara Bank and Trust, a division of Pacific Capital Bank, N.A., as Beneficiary, and any modifications thereto are collectively referred to herein from time to time as the “Deed of Trust” WILL SELL AT PUBLIC AUCTION TO THE HIGHEST BIDDER, in lawful money of the United States, all payable at the time of sale, that certain property situated in said County, California describing the land therein as: COMMENCING ATA POINT ON THE NORTHWESTERLY LINE OF SOLA STREET, DISTANT THEREON 85 FEET SOUTHWESTERLY FROM THE MOST EASTERLY CORNER OF BLOCK NO. 80 OF SAID CITY OF SANTA BARBARA AS SAID STREET AND SAID BLOCK ARE LAID DOWN AND DESIGNATED ON THE OFFICIAL MAP AND SURVEY OF SAID CITY, AND RUNNING THENCE ALONG THE NORTHWESTERLY LINE OF SOLA STREET
SOUTHWESTERLY 50 FEET; THENCE AT RIGHT ANGLES INTO SAID BLOCK NO. 80 AND PARALLEL WITH CASTILLO STREET
NORTHWESTERLY 132 FEET 6 INCHES; THENCE AT RIGHT ANGLES
NORTHEASTERLY 50 FEET; THENCE AT RIGHT ANGLES
SOUTHEASTERLY 132 FEET 6 INCHES TO THE POINT OF BEGINNING. NOTICE TO POTENTIAL BIDDERS: If you are considering bidding on this property lien, you should understand that there are risks involved in bidding at a trustee auction. You will be bidding on a lien, not on the Property itself. Placing the highest bid at a trustee auction does not automatically entitle you to free and clear ownership of the Property. You should also be aware that the lien being auctioned off may be a junior lien. If you are the highest
bidder at the auction, you are or may be responsible for paying off all liens senior to the lien being auctioned off, before you can receive clear title to the Property. You are encouraged to investigate the existence, priority, and size of outstanding liens that may exist on this Property by contacting the county recorder’s office or a title insurance company, either of which may charge you a fee for this information. If you consult either of these resources, you should be aware that the same lender may hold more than one mortgage or deed of trust on the Property. NOTICE TO PROPERTY OWNER: The sale date shown on this notice of sale may be postponed one or more times by the mortgagee, beneficiary, trustee, or a court, pursuant to Section 2924g of the California Civil Code. The law requires that information about trustee sale postponements be made available to you and to the public, as a courtesy to those not present at the sale. If you wish to learn whether your sale date has been postponed, and, if applicable, the rescheduled time and date for the sale of this Property, you may call 1.866.684.2727 or visit this Internet Website www.servicelinkasap.com. using the file number assigned to this case 24‑00317‑2FNT. Information about postponements that are very short in duration or that occur close in time to the scheduled sale may not immediately be reflected in the telephone information or on the Internet Website. The best way to verify postponement information is to attend the scheduled sale. The real Property heretofore described is being sold “as is” The street address and other common designation, if any, of the real Property described above is purported to be: 410 WEST SOLA STREET, SANTA BARBARA, CA The undersigned Trustee disclaims any liability for any incorrectness of the street address and other common designation, if any, shown herein. Said sale will be
made without covenant or warranty, express or implied, regarding title, possession, or encumbrances, to pay the remaining unpaid balance of the obligations secured by and pursuant to the power of sale contained in that certain Deed of Trust (together with any modifications thereto). The total amount of the unpaid balance of the obligations secured by the Property to be sold and reasonable estimated costs, expenses and advances at the time of the initial publication of this Notice of Trustee’s Sale is estimated to be $506,510.00 (Estimated), provided, however, prepayment premiums, accrued interest and advances will increase this figure prior to sale. Beneficiary’s bid at said sale may include all or part of said amount. In addition to cash, the Trustee will accept a cashier’s check drawn on a state

rules are proposed in order to implement state and federal mandates to reduce air pollution in Santa Barbara County. Before the adoption or amendment of any rule, the District publishes a notice in a local newspaper and holds a public hearing to accept comments from affected businesses and other interested parties.
The following rules are tentatively proposed to be adopted in 2025:
Title
Asbestos Demolition and Renovation
The following rules are included in case adoption or amendment is needed during 2025:
Agricultural and Prescribed
Source Performance Standards (NSPS)
Emission Standard for Hazardous Air Pollutants (NESHAP)
If you would like to check on the status of a rule, please visit the District’s website at www.ourair.org/rules-and-regs/. For more information, contact Tim Mitro at (805) 979-8329.